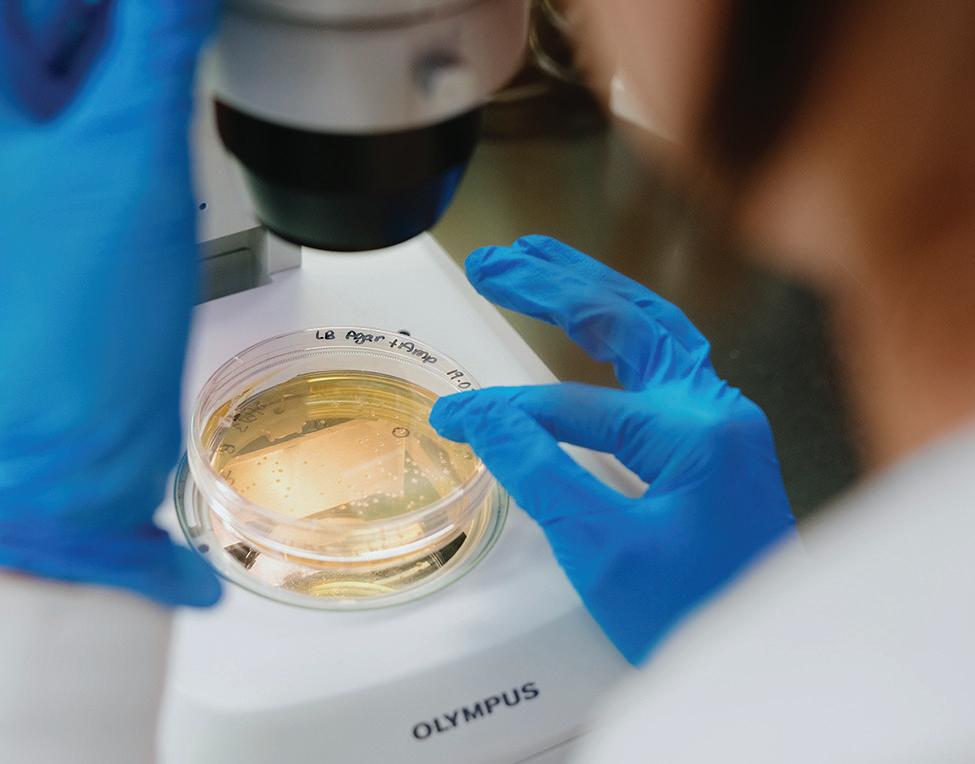

Dossiers
Déjeuners et dîners d'affaires
Voyage
La Nouvelle-Écosse
D re ANNE-SOPHIE VILLENEUVE ET D r SIMON LAFRENIÈRE PARODONTISTES ET COPROPRIÉTAIRES

![]()
Déjeuners et dîners d'affaires
Voyage
La Nouvelle-Écosse
D re ANNE-SOPHIE VILLENEUVE ET D r SIMON LAFRENIÈRE PARODONTISTES ET COPROPRIÉTAIRES



En page couverture :
Dre Anne-Sophie Villeneuve et Dr Simon Lafrenière, parodontistes et copropriétaires de Villa - Espace Paro
NOS CHRONIQUES 80 ASSURANCES ET GESTION DE RISQUES
ÉLECTRONIQUE
SANTÉ
NOS SECTIONS

Alors qu’une Autre Année s’Achève, un rituel s’impose presque n Aturellement : celui du trAditionnel bilAn. c’est un moment suspendu entre les derniers projets à compléter et l’effervescence du temps des f êtes, où l’on se permet enfin de lever lA tête, de regArder pAr-dessus son épAule et d’évAluer le chemin pArcouru. cet exercice, trop souvent négligé à trAvers les urgences du quotidien, s’Avère pourtAnt d’une richesse considérAble.
Cette rétrospective permet aux propriétaires d’entreprise — au-delà des chiffres et des objectifs atteints — d’analyser les choix stratégiques, les réussites et les apprentissages. De leur côté, les gestionnaires ont l’occasion de reconnaître les efforts collectifs, de mesurer la mobilisation des équipes et d’identifier les leviers de croissance à venir. Quant aux salariés passionnés, ils peuvent en profiter pour prendre conscience de l’évolution de leurs compétences, des valeurs qui les animent et du rôle qu’ils jouent au sein de leur organisation.
Pour les leaders, encourager une telle démarche au sein de leur personnel est un geste visionnaire. En effet, proposer à son équipe de réfléchir à son année, d’identifier les réussites et les zones d’amélioration permet de réaligner les forces et d’accroître la cohésion. Cet exercice collectif devient un puissant levier de mobilisation avant d’aborder une nouvelle année, non pas dans une confortable
routine, mais avec enthousiasme. Dans un environnement d’affaires en constante mutation, marqué par des enjeux économiques complexes, des changements technologiques rapides et des attentes grandissantes en matière de durabilité, cette capacité d’analyse devient un avantage stratégique. Savoir ce qui a bien fonctionné et ce qui mérite d’être repensé ouvre la voie à une prochaine année plus alignée, plus cohérente et, surtout, plus humaine.
Cette démarche introspective ne devrait pas se limiter à la sphère professionnelle, car le bilan personnel joue un rôle tout aussi essentiel. Trouver l’équilibre entre performance et bien-être, entre ambition et sérénité. Se demander comment on s’est senti dans son travail, quelles relations on a cultivées, quels projets nous ont réellement fait vibrer, voilà des questions qui nourrissent une réflexion authentique et profonde. C’est en ralliant les dimensions personnelle et professionnelle que l’on parvient à créer une dynamique durable et une satisfaction sincère.
Durant la pause des Fêtes, ce profitable temps de recul prend tout son sens. Ce moment de calme, où l’on quitte le rythme effréné du quotidien, sert de catalyseur pour donner forme à de nouvelles ambitions. C’est dans ce silence réfléchi que naissent souvent les idées les plus prometteuses… Que cette période de bilans vous inspire la fierté du travail accompli et la motivation d’aller plus loin ! Et, en parcourant les pages de ce numéro, laissez-vous imprégner par ces histoires illustrant à merveille la passion, la créativité et la résilience dont nos acteurs économiques et culturels ont fait preuve cette année. Ces exemples ne tiennent pas qu’à la réussite : ils sont la preuve que, lorsque la vision et l’engagement s’unissent, tout devient possible.
Micaël Minguy-Bédard
Éditeur
DÉCEMBRE 2025
Vol. 30, no 5, 249e parution
PUBLIÉ PAR :
L'Antidote Médias
DIRECTRICE DE CONTENU
Maude Simard-Langlois redaction@magazineprestige.com
COORDONNATRICE DE PRODUCTION
Jessie Vachon info@magazineprestige.com
VICE-PRÉSIDENTE DES VENTES
Alexandra Leduc alexandra.leduc@lantidote.com 418 805-9692
COLLABORATEURS
Ariane Arpin-Delorme
Cendrine Chénel
Gilles Levasseur
Jacynthe Picard
Jean-Marie Lebel
Jean-Pierre Bouchard
Johanne Martin
Julie Marie Dorval
Marie-Josée Turcotte
Mélina Vachon
Nathalie Clark
Nathalie Roy
Paméla Égan
CORRECTION ET RÉVISION
Gilles Levasseur
PRODUCTION, GRAPHISME
Jessie Vachon
L'Antidote Médias
PHOTO PAGE COUVERTURE
Étienne Dionne, Photographe
PHOTOGRAPHIES
Alexandre Zacharie
Étienne Dionne, Photographe
Jacques Fortin, l'Antidote Médias
Nadia Bélanger
IMPRESSION
Solisco
DISTRIBUTION RÉSIDENTIELLE ET COMMERCIALE
Postes Canada
Dépôt légal Bibliothèque nationale du Canada
ISSN-1205-6707
Dépôt légal Bibliothèque nationale du Québec
Magazine Prestige
6500, boul. Pierre-Bertrand, bureau 200 Québec (Québec) G2J 1R4
Téléphone : 581 981-9555 magazineprestige.com
Cette édition est distribuée à 20 000 exemplaires.
Les opinions émises dans les articles publiés par le magazine Prestige n’engagent que leur auteur.
Une publication de
La sclérose latérale amyotrophique (SLA) est une maladie neurodégénérative grave qui entraîne la détérioration progressive des neurones moteurs. Les personnes atteintes de la SLA perdent progressivement leur mobilité, mais aussi leur capacité à parler, à manger et, éventuellement, à respirer. Chaque année, environ 4 000 Canadiens reçoivent un diagnostic de SLA, ce qui équivaut à deux nouveaux cas par 100 000 habitants. Dans 80 % des cas, l’espérance de vie après le diagnostic est de deux à cinq ans.
La Société de la SLA du Québec est un organisme à but non lucratif qui a pour mission d’améliorer la qualité de vie des personnes touchées par la SLA et de leur famille. Elle a également comme mission de conscientiser le public afin qu’il comprenne mieux la maladie et se mobilise pour qu’il contribue à la cause et ainsi financer les projets de recherche les plus prometteurs et pertinents, susceptibles d’améliorer la condition de vie des personnes atteintes et de guérir la maladie. Pour plus d’information, visitez sla-quebec.ca
Dre Anne-Sophie Villeneuve, Dr Jean-Pierre Canuel, Dr Simon Lafrenière et Micaël Minguy-Bédard
Dans le cadre de l’édition 2025 du magazine
Prestige Duo inspirant de l’année , c'est avec fierté que l'Antidote médias reverse une portion des sommes recueillies à l’organisme choisi par les entrepreneurs en couverture. Cette année, la fondation soutenue est SLA Québec , un acteur essentiel qui accompagne les personnes touchées par cette maladie dégénérative et leurs familles. Grâce à l’engagement exemplaire de Villa – Espace Paro et de son partenaire, un chèque de 7 154 $ a été remis afin de soutenir cette mission honorable. Félicitations à tous ceux et celles qui contribuent à transformer notre communauté et à offrir espoir et soutien là où il est le plus nécessaire.




L’athlète paraplégique Jimmy Pelletier vient d’établir un nouveau record historique en dépassant la marque de 8557 km à vélo à main, inscrivant son nom comme l’homme le plus endurant de la planète dans sa catégorie. Ce jalon
AWŪ : le bien-être urbain réinventé par Strøm

Srituels inspirés du monde, studio de mouvement et café-restaurant axé sur la fraîcheur. Les deux premiers établissements ouvriront début 2026 au DIX30 et à Québec, dans les anciens locaux SKYSPA entièrement réinventés. AWŪ vise aussi une expansion internationale, avec un projet à Seattle déjà à l’étude. Porté par l’expertise reconnue du Groupe STRØM, AWŪ poursuit la mission d’offrir des espaces inspirants, adaptés aux réalités urbaines et ancrés dans une croissance responsable.
trøm lance AWŪ, une nouvelle marque sœur dédiée au bien-être urbain, accessible et énergisant. Conçu pour une nouvelle génération de citadins, AWŪ proposera une expérience immersive de soft wellness combinant cycle thermal, massages, n’est qu’une étape de son ambitieux tour du monde de 40 000 km, réparti sur 27 pays et 5 continents, qu’il prévoit compléter d’ici juin 2027. Au-delà de la performance, Jimmy souhaite inspirer et soutenir la mission essentielle d’Adaptavie, organisme québécois œuvrant depuis 45 ans auprès de personnes avec des limitations physiques, intellectuelles ou vivant avec un trouble du spectre de l’autisme dans le but d’améliorer leur bien-être et leur autonomie. Son défi vise à amasser des fonds pour le futur Complexe Santé Adaptavie.

Félicitations à Alexandra Leduc , nommée Professionnelle de l’année lors de la 30e édition de Format Libre ! Cette reconnaissance met de l’avant son expertise, son engagement et son influence dans son domaine. Format Libre, un événement phare de la communauté
créative, célèbre chaque année le talent sous toutes ses formes. Sa mission : valoriser l’excellence professionnelle tout en soutenant une cause essentielle. Format Libre remet l’ensemble de ses bénéfices à Centraide Québec ChaudièreAppalaches, contribuant ainsi au mieux-être de centaines d’organismes de la région. En remportant ce prix, Alexandra incarne parfaitement l’esprit de créativité, de rigueur et de dépassement que l’événement souhaite mettre en lumière. Bravo pour cette distinction amplement méritée !



située Au cŒur des Alpes frAnçAises, dAns lA vAllée de lA tArentAise en sAvoie, courchevel fAit pArtie du légendAire domAine skiAble des trois vAllées, le plus vAste Au monde. chAque hiver, cette stAtion mythique se tr A nsforme en un véritA ble théâtre de l’élégAnce et du prestige. depuis des décennies, les têtes couronnées, les gr A nds pAtrons et les vedettes du cinémA y trouvent refuge pour sAvourer les pl Aisirs de l A montAgne dAns une Atmosphère feutrée, AlliAnt discrétion, rAffinement et service irréprochAble.
LE RENDEZ-VOUS ALPIN DES STARS ET DES FAMILLES D’EXCEPTION
C’est à Courchevel 1850 que bat le cœur du luxe alpin. Les chalets scintillent sous les guirlandes, les vitrines rivalisent d’éclat et les rues s’animent de spectacles féeriques où petits et grands se retrouvent pour célébrer la magie des Fêtes. Chaque Noël, le grand sapin illuminé de la place du Tremplin attire familles et voyageurs venus du monde entier pour admirer ce décor de carte postale, tandis que les soirées se prolongent dans les hôtels de luxe, entre musique live, champagne et gastronomie d’exception.

Cheval Blanc Courchevel : l’élégance signée LVMH au sommet des Alpes offrant 36 chambres ultra luxueuses, un accès direct aux pistes et une table triplement étoilée Michelin.
Courchevel 1850, parée de lumières, s’illumine de toute la magie de Noël.

Les plus grandes célébrités — de Leonardo DiCaprio à George Clooney, en passant par la famille royale britannique, Christina Aguilera ou Geri Halliwell — ont fait de Courchevel leur refuge hivernal. La station regorge d’adresses prestigieuses, telles que Les Airelles, L’Apogée Courchevel, Hôtel Barrière Les Neiges ou Ultima Courchevel, mais un établissement se distingue par son raffinement incomparable : Cheval Blanc Courchevel.

Portant la signature du groupe LVMH, ce palace incarne la quintessence du luxe français. Ses 36 chambres et suites, décorées avec une élégance chaleureuse, s’ouvrent sur les pistes immaculées. Le restaurant gastronomique Le 1947, triplement étoilé Michelin, offre une expérience culinaire exceptionnelle sous la direction du chef Yannick Alléno. Le spa Guerlain, le service de majordome personnalisé et l’accès ski-in/ski-out parachèvent ce séjour d’exception, où chaque détail évoque l’art de vivre à la française.
Les soirées de Noël et du Nouvel An à Courchevel 1850 sont devenues légendaires. Les grands hôtels rivalisent d’imagination pour offrir des dîners de gala raffinés, suivis de soirées exclusives où les invités dansent jusqu’au petit matin. À minuit, les montagnes s’embrasent sous les feux d’artifice et les coupes de champagne se lèvent dans une ambiance à la fois festive et feutrée. À Courchevel, les Fêtes ne se contentent pas d’être luxueuses : elles deviennent inoubliables.

Courchevel : chalets élégants et pistes mythiques sous la neige, au cœur du plus grand domaine skiable des Alpes françaises.

VILLA – ESPACE PARO
lA pAssion de lA profession. symptômes ? engAgement sincère envers le dom A ine dent A ire, curiosité constA nte, expression de vA leurs personnelles et désir de se dép A sser. v olonté d’ A pprendre, de s’ A méliorer et de contribuer positivement à son milieu professionnel. Au bout du compte, le sourire de ces spéciAlistes en dit long sur ce qu’ils recherchent AvAnt tout pour l’humAin…




SYNERGIE ORTHODONTIE

AUCOIN ORTHODONTISTE


CLINIQUE OROSPHÈRE

TML INFORMATIQUE

Dre Anne-Sophie Villeneuve et Dr Simon Lafrenière, parodontistes et copropriétaires
d epuis douze A ns qu’ils évoluent ensemble en pArodontie, les drs Anne-sophie villeneuve et simon lA frenière pA rtA gent ce désir profond de fA ire rAyonner leur spéciAlité. cette démArche s’exprime en trois volets : offrir à leur clientèle des soins de h Aute quA lité à des tA rifs r A isonn A bles d A ns un environnement A p A is A nt, f A voriser le bienêtre de leurs employés et pArtAger leur expertise pAr l’entremise de l A form Ation Aux dentistes et hygiénistes. d ’ A illeurs, le sujet de m A îtrise de d r lAfrenière en disAit déjà long sur l’une de ses préoccupAtions premières : l’Anxiété des pAtients. Aujourd’hui, A u tourn A nt de l A qu A r A ntA ine, le tA ndem professionnel poursuit s A mission d A ns une clinique de rêve, villA — espAce pAro, couvrAnt quelque 25 000 pi 2 et inclu A nt même un centre de form A tion. p ortr A it de deux p A rodontistes pAssionnés.

Associés de manière pratiquement fortuite pour racheter la clinique de Dr M. A. Bélanger, pionnier de la parodontie à Québec, les deux jeunes parodontistes ont entrepris en duo leur aventure entrepreneuriale dès leur sortie de l’université. « Nous avons appris à travailler ensemble en nous appuyant sur nos forces, qui sont très complémentaires, raconte Dr Lafrenière. Nous avons bâti un socle de valeurs communes autour desquelles nous entendions développer notre pratique. » Rapidement, ils ont eu l’occasion d’acheter une seconde clinique de parodontie sur la rive sud de Québec, qu’ils ont su faire grandir et s’implanter dans son milieu. Celle-ci a été revendue en 2024.
Poursuivant leur croissance sur la rive nord, ils ont rénové et agrandi leur local, et recruté d’autres parodontistes pour finalement constater que les limites physiques et de stationnement ne leur permettaient plus de faire face à l’achalandage de manière satisfaisante. « L’environnement était trop petit pour nos projets d’avenir, explique D re Villeneuve. Nous étions jeunes, et notre vision était celle d’une clinique accueillante dans laquelle il est agréable de travailler et de recevoir des traitements, où l’expérience est synonyme de qualité des soins. » Lorsque la Covid a tout mis sur pause et que la rareté de la main-d’œuvre est devenue encore plus évidente, les jeunes entrepreneurs ont amorcé une réflexion profonde sur les façons de valoriser le personnel et l’importance du milieu de vie professionnel. « Au-delà des patients, ajoute Simon, accueillir nos employés dans un espace dont ils sont fiers et dans lequel ils se sentent bien nous apparaissait nécessaire. »
DÉVELOPPER LA SPÉCIALITÉ
Parallèlement, le tandem faisait connaître et rayonner cette spécialité en offrant de la formation continue aux dentistes de l’est du Québec. « Nous l’avons fait jusqu’en 2023 en plus de nous impliquer à l’Université Laval, explique Anne-Sophie, car la formation des dentistes généralistes a toujours été un volet important de notre mission. Ainsi, nous sensibilisions non seulement nos pairs à cette spécialité, notamment en détectant plus efficacement les maladies parodontales, qui touchent une personne sur deux en Amérique du Nord, mais cela créait aussi des relations de collaboration et d’entraide avec les dentistes de la région. » D’abord dispensées à la clinique, ces formations ont ensuite eu lieu dans des hôtels en raison de leur popularité, puis sont devenues virtuelles avec la pandémie. « C’est pour continuer cette vocation de partage du savoir que nous avons plus tard profité de la superficie de nos nouveaux locaux pour y inclure, avec autant de rigueur et de passion que dans tous nos projets, l’espace de formation Campus, indique Simon. L’occasion était trop belle ! »

TOURNANT MAJEUR : L’ÉCOLE
D’ENTREPRENEURSHIP DE BEAUCE
Si Villa — Espace Paro a vu le jour, c’est beaucoup grâce à l’immersion d’Anne-Sophie et Simon à l’École d’Entrepreneurship de Beauce. « En 2018, elle en est revenue avec plein d’idées, et je l’ai imitée l’année suivante pour mieux la comprendre, avoue Simon. L’expérience nous a notamment appris que les dentistes sont leur propre outil de production, leur propre produit, en plus d’être des gens d’affaires et des professionnels de la santé, et qu’en leur absence, tout s’arrête. C’est l’expertise et la qualité du travail à la chaise qui priment. Comme nous portions tous les chapeaux, en plus des familles que nous fondions, il était crucial de bien nous entourer, surtout avec une équipe qui avait grandi, et de prendre soin de nos employés, dont le bien-être se répercute indéniablement sur nos patients. »


Forts de cette perception renouvelée, Anne-Sophie et Simon se sont mis en quête d’un nouvel emplacement pour une future clinique afin de mieux gérer la croissance de leur entreprise. Après avoir lorgné plusieurs possibilités de locaux, la Covid a frappé. C’est alors qu’ils ont fait la connaissance du PDG d’Acero Immobilier, Benoît Raymond, qui souhaitait revitaliser ce secteur de la rue Cyrille-Duquet, lui proposant un partenariat dans un immeuble commercial. L’homme d’affaires a déniché un terrain, facilement accessible pour accommoder des patients provenant d’un peu partout au Québec et au Nouveau-Brunswick, et doté d’un très grand stationnement. « Nous en avons fait l’acquisition durant la pandémie, le promoteur s’est chargé de faire construire le bâtiment à partir de 2021, résume D r Lafrenière. Nous pouvions dès lors concevoir, puis mettre en place la clinique dont nous rêvions et que nous allions pouvoir habiter longtemps. Et en juin 2023, nous emménagions dans ce très vaste local de 25 000 pi2. Projet d’une vie, notre environnement idéal était devenu réalité. »
EN IMPLANTOLOGIE ET EN PARODONTIE
Comme les soins dentaires sont plutôt une source d’anxiété pour beaucoup de patients, une attention particulière a été apportée à tout ce qui peut les rassurer et rendre leur expérience chez Villa agréable. L’accueil est personnalisé, la luminosité naturelle, l’ambiance, la salle d’attente distinctive, les teintes apaisantes, la musique douce, la fragrance qu’on y distille, l’éclairage, le grand nombre de salles de traitement et de bureaux, les immenses corridors, autant de détails qui font que tout le monde s’y sent bien. « Nous avions tellement souffert de l’exiguïté de nos anciens locaux que nous nous sommes donné beaucoup de confort, précise Dr Lafrenière. La superficie est telle que l’important va-et-vient passe presque inaperçu. L’objectif est que les patients puissent dire que tout s’est passé bien mieux qu’ils auraient cru, car c’est à leur satisfaction que nous mesurons notre succès. »
SAVOIR S’ENTOURER
Un autre clin d’œil de la vie s’est produit lors de l’acquisition de la clinique Allegro en 2024. « Cette transaction nous a permis de faire d’une pierre deux coups, d’une part en accueillant D r Pierre Maccabée, chirurgien-dentiste de grande renommée en implantologie, et d’autre part en recrutant Stéphane Destison comme directeur général, poursuit D re Villeneuve. Ce fut l’une de nos meilleures décisions, car celui-ci, de pair avec la direction des ressources humaines, est devenu la clé de voûte de notre entreprise, s’assurant de la gestion pendant que nous nous concentrons sur la qualité de nos soins. »
Le principal intéressé s’étonne de la capacité des jeunes propriétaires à conjuguer la recherche de l’excellence en dentisterie et le souci du patient tout en gardant leur énergie d’entreprendre. « Depuis que je travaille chez Villa — Espace Paro, je suis impressionné par la primauté de l’humain et cette volonté d’innover sur les considérations de rentabilité, explique M. Destison. J’applaudis aussi au généreux partage du savoir avec la communauté dentaire, comme en fait foi notre centre de formation tout à fait unique à même notre clinique, avec son salon favorisant le réseautage et les échanges hors formation. Bref, autour des cinq professionnels s’active une équipe de soutien tout aussi consciente de l’importance de traiter le patient avec délicatesse et respect. »
Le partage fait partie de l’ADN d’Anne-Sophie et Simon, qui ont tour à tour présidé le conseil d’administration de la Société dentaire de Québec dans la dernière décennie. « Je pense que le monde dentaire — autant les dentistes invités que les propriétaires de cliniques — a besoin de se retrouver dans une certaine communauté pour partager, socialiser et s’épauler, souhaite Anne-Sophie. Quand nous voyons les gens repartir satisfaits de nos formations, c’est extrêmement gratifiant. Redonner à la société fait aussi partie de nos priorités ; nous avons d’ailleurs fondé le Parodon il y a huit ans, une formation dont les coûts d’inscription sont remis en totalité à un organisme caritatif, pour un total de 100 000 $ depuis les débuts de cette initiative. »
Simon rend hommage à ce détour de la vie lui ayant permis de croiser la route d’Anne-Sophie. « Si le hasard existe, conclut-il, c’en fut un très beau, car ce parcours n’aurait pas existé sans notre fructueux mariage professionnel, notre complémentarité et notre vision commune du bienêtre de nos patients, ainsi que notre recherche constante des meilleures façons de les traiter et de partager nos connaissances. »

Remise du chèque du 8e Paro-don au représentant de SLA Québec
Dre Anne-Sophie Villeneuve, Dr Jean-Pierre Canuel, Dr Simon Lafrenière et Stéphane Destison
Pour en savoir davantage :
Villa - Espace Paro 1440, rue Cyrille-Duquet, bureau 300, Québec quebec@parodontie.ca | 418 659-7779 parodontie.ca

« l'équipe représente notre plus grAnde fierté », lAncent dAns une belle unAnimité les propriétAires de lA clinique de pArodontie et d’implAntologie villA - espAce pAro, drs Anne-sophie villeneuve et simon lAfrenière. ce sont elles — principAlement des femmes — qui Accueillent les pAtients, les informent, les rAssurent et les grAtifient de leur sourire, bref, leur font vivre une expérience de trAitement lA plus AgréAble possible.
À une époque où la profession dentaire connaît depuis plusieurs années une rareté de main-d’œuvre à plusieurs postes, le directeur général de la clinique de la rue Cyrille-Duquet, Stéphane Destison, se sent particulièrement privilégié de réussir à maintenir un noyau central d’employées de très grande qualité et expérimentées. « Plusieurs d’entre elles sont présentes depuis 15, 25 et même 35 ans, se réjouit-il. Elles sont responsables de la formation, de l’accompagnement et de la croissance des jeunes membres de l’équipe. Nous sommes vraiment très bien entourés. Si les patients ont du mal à juger de la qualité des soins, en revanche, leur expérience à la clinique doit être impeccable, car c’est le souvenir qu’ils en garderont en repartant. Cette appréciation est rendue possible grâce à nos anges, qui reflètent au quotidien les valeurs d’humanité, de respect et de professionnalisme qui nous importent tant ! »
De son côté, Dre Anne-Sophie Villeneuve mentionne le fait qu’en retour, ces employées sont traitées avec respect et bienveillance. « C’est pour cela que nous avons soigné l’expérience que nous offrons à nos équipes :
Une partie de l’équipe Villa - Espace Paro : Dr Benjamin Labelle, Dre Béatrice GroleauAsselin, Dre Anne-Sophie Villeneuve et Dr Simon Lafrenière, parodontistes
des espaces dédiés très confortables, des ressources généreuses et une conscience accrue pour la conciliation travail-famille, précise-t-elle. Nous nous assurons également d’une ambiance respectueuse au sein du personnel, et nous faisons en sorte que toutes ces personnes puissent s’épanouir dans leur profession respective. Plusieurs fois par année, nous organisons des évènements et retraites pour notre équipe afin de nous assurer de la cohésion et du partage des valeurs. »
Le mot de la fin revient à Dr Simon Lafrenière : « Nous sommes heureux d’employer ce beau groupe de plus de 40 personnes à temps plein, qui contribuent non seulement à l’avancement de notre spécialité dentaire et à l’amélioration des services à la population, mais aussi au dynamisme économique de la capitale, conclut-il. C’est certes une responsabilité importante, mais aussi une grande fierté, car nous aimons notre ville et nous sommes heureux de participer à notre façon à son essor. »
directeur général, Villa -
Ayant à son actif deux décennies d’expérience dans le monde dentaire, Stéphane Destison dirigeait la clinique d’implantologie Allegro lorsque celleci a été acquise par Villa - Espace Paro. « Ce que je trouve extraordinaire chez Anne-Sophie et Simon, c’est vraiment l’intensité avec laquelle ils se préoccupent autant de la qualité des soins dentaires prodigués que de l’expérience des patients. Bref, ils conjuguent rigueur et bienveillance. Ils sont toujours à l’affût de nouveaux traitements, d’une manière de mieux servir les patients, d’une façon inédite d’envisager la gestion du personnel, tout cela en étant visionnaires pour le futur de Villa. Sans oublier qu’ils satisfont en parallèle leur désir profond de partager leur savoir auprès de leurs pairs avec le Campus - Espace de formation. »

Dre Béatrice Groleau-Asselin est la plus jeune parodontiste de Villa — Espace Paro. En joignant l’équipe il y a environ un an, elle était déjà en pays de connaissance, car son collègue Benjamin Labelle avait étudié en même temps qu’elle, et elle avait côtoyé Anne-Sophie et Simon pendant sa résidence multidisciplinaire. « Fraîchement sortie de l’université, j’étais rassurée d’y trouver des visages familiers, ça m’a beaucoup aidée, raconte-t-elle. L’entraide est très présente entre nous, je l’apprécie énormément, et toute l’équipe est aussi professionnelle que sympathique. Nous sommes comblés en matière d’équipements, incluant un laboratoire à même la clinique. Quand Anne-Sophie et Simon ont conçu ce magnifique espace, ils n’ont rien laissé au hasard. Je suis vraiment chanceuse d’y exercer ma profession ! »


Avant de se spécialiser en parodontie, Dr Benjamin Labelle a exercé pendant trois ans comme dentiste généraliste. « C’est au cours de cette période que j’ai été appelé à collaborer avec Anne-Sophie et Simon pour le traitement de mes patients, raconte-t-il, et nous sommes restés en contact pendant ma spécialisation. Mon diplôme en poche, j’ai décidé de joindre leur équipe. » Pourquoi la parodontie ? « Parce que j’avais le sentiment de ne pas être allé au bout de mon potentiel, notamment sur le plan chirurgical », ajoute-t-il. Après deux ans et demi chez Villa, il affirme avoir les coudées franches. « De plus, l’équipe est dynamique et l’ambiance professionnelle me stimule beaucoup, je me trouve donc choyé d’exercer dans un aussi bel environnement. Au cœur d’une telle expertise de pointe, ça donne vraiment envie d’aller toujours plus loin ! »
Dr PHILIPPE GIRARD
en dentisterie, l A pArodontie et l A prosthodontie sont deux spéci A lités complémentA ires d A ns l A restAurAtion de lA dentition. lA première concerne le diAgnostic, l A prévention et le trAitement des mAlAdies des gencives et des tissus de soutien des dents, tAndis que lA seconde consiste à répArer les dents nAturelles ou remplAcer celles qui mAnquent d A ns le but de rétA blir à l A fois l A fonction et l’esthétique.
Prosthodontiste à Québec, D r Philippe Girard collabore étroitement depuis des années avec ses collègues AnneSophie Villeneuve et Simon Lafrenière. « Je les connais depuis leur passage à l’université, car je les ai côtoyés en tant que clinicien pendant leurs années de résidence, explique-t-il. Après leur graduation, ils m’ont tout de suite proposé de collaborer avec moi, la chimie a opéré dès le départ, et nous avons développé au fil du temps une très belle complicité. Quand chacun sait comment l’autre perçoit les choses, le succès des interventions s’en voit optimisé. C’est important, surtout pour des cas complexes qui requièrent la participation de plusieurs dentistes spécialistes. »
La pose d’implants illustre très bien cette complémentarité entre les deux spécialités. Le parodontiste s’assure que la structure de soutien des implants (gencive et os) est saine et forte, car c’est la base dans laquelle l’implant sera inséré. Cette étape réalisée, le prosthodontiste s’occupe de la restauration dentaire et de la création de prothèses, notamment les couronnes. Il conçoit et installe la prothèse sur l’implant, en veillant à ce qu’elle soit fonctionnelle et esthétiquement agréable. « Cela dit, les technologies numériques facilitent de plus en plus notre travail, notamment l’étude virtuelle des cas », poursuit Dr Girard.

Ce dernier apprécie tout particulièrement le centre de formation ultramoderne de la Clinique Villa Espace Paro, surtout qu’il y dispense d’ailleurs lui-même de l’enseignement. « J’aime beaucoup cet endroit unique et chaleureux, car la salle est vraiment bien conçue pour une communication étroite avec les dentistes qui viennent apprendre, avec, en prime, la section lounge pour échanger agréablement en dehors des cours. La clinique adjacente permet en outre d’utiliser l’équipement de pointe pour illustrer concrètement au besoin certains aspects du contenu des formations. De la théorie à la pratique, sous un même toit ! Cela démontre de façon éloquente le désir de ces jeunes dentistes-propriétaires de transmettre le savoir et de faire rayonner la profession dentaire. »

Villa – Espace Paro
ORTHODONTISTES QUÉBEC
l e lien n’est p A s évident de prime A bord, m A is les orthodontistes coll A borent Avec les pA rodontistes pour nombre de leurs pAtients, surtout d’âge Adulte. « comme nous devons Augmenter le périmètre des ArcAdes dentAires Afin de permettre le réAlignement, les gencives doivent être solides en externe pour supporter les mouvements », explique d r louis dorvAl. le spéciAliste f A it p A rtie, Avec six A utres confrères, des entités o rthodontistes q uébec et o rthodontistes l évis, qui pr Atiquent indépend A mment tout en respectA nt les mêmes vAleurs professionnelles.
Même si Dr Dorval a gradué avant Drs Villeneuve et Lafrenière, il collaborait beaucoup avec leur prédécesseur, Dr Marc-André Bélanger, dont la clinique de Sainte-Foy est devenue VillaEspace Paro. « Marc-André a fait partie des précurseurs dans sa spécialité en raison de sa vision, de sa gestion efficace et de sa rigueur professionnelle, précise Dr Dorval. Il est assez remarquable de constater avec quel dynamisme Anne-Sophie et Simon ont repris cette pratique pour la propulser à un autre niveau. Il suffit de regarder les installations de la rue CyrilleDuquet pour s’en convaincre, sous la direction de Stéphane Destison, un excellent gestionnaire, qui supervisait la clinique d’implantologie de mon collègue et ami, Dr Pierre Maccabée, qui a gradué en même temps que moi et qui a rejoint l’équipe de Villa - Espace Paro. Fait à noter, c’est maintenant Orthodontistes Québec qui occupe ses anciens locaux de la route de l’Église. »


Chose certaine, la demande pour les soins orthodontiques est en constante progression. « En effet, explique le spécialiste, le volume des mâchoires humaines ne cesse de diminuer, de sorte qu’il ne reste que très peu de place pour les dents de sagesse, par exemple, et que le chevauchement de dents est presque devenu la norme. Les maxillaires sont de moins en moins proéminents et l’être humain moderne mastique une nourriture de moins en moins coriace. Heureusement, la technologie a évolué en orthodontie, notamment grâce aux aligneurs de plastique transparent, qui ont remplacé les traditionnelles broches dans plus du trois quarts de nos interventions, avec des résultats équivalents ou supérieurs et une expérience beaucoup plus agréable pour les patients. »
D r Louis Dorval conclut en disant que, dans la réussite du projet Villa - Espace Paro, le talent ainsi que les compétences exceptionnelles d’AnneSophie et Simon ne suffisaient pas. « Ils ont en plus l’instinct et la capacité de bien s’entourer et d’entraîner leur personnel dans leur énergie et leur vision. Impossible de créer ce succès sans leadership et sans pouvoir compter sur une équipe bien rodée. »
Dr Beaudet
Équipe Dorval et Beaudet
Clinique de Sainte-Foy | 418 651-6512
1000, route de l’Église, local 490, Québec (Québec) G1V 3V9
Clinique de Cap-Rouge | 418 877-8770
810, route Jean-Gauvin, bureau 200, Québec (Québec) G1X 0B6
L’orthodontie est un investissement pour votre confort et votre confiance.
Dorval
Équipe Elmaraghy
Clinique de Sainte-Foy | 418 651-6513 3385, chemin Sainte-Foy, Québec (Québec) G1X 1S7
Elmaraghy


Villa – Espace Paro
INSTITUT DENTAIRE GRANDE ALLÉE
v érit A ble p A ssionnée des sciences dent A ires, dre nAthAlie vAchon, qui dirige depuis une décennie l’ i nstitut d ent A ire g r A nde Allée, propose une pr Atique fondée sur l’imp A ct fond A mentA l des soins dentAires sur l A sAnté globAle. moderne et éprouvée, cette Approche conjugue deux disciplines émergentes : l’esthétique dentAire et lA dentisterie biofonctionnelle.
Accréditée depuis 2011 par l’American Academy Of Cosmetic Dentistry (AACD), Dre Vachon œuvre depuis plus de 30 ans comme généraliste offrant des services d’orthodontie et de réhabilitation dentaire complète. Aujourd’hui, sa clinique multidisciplinaire est l’une des trois au Québec — une centaine seulement dans le monde — certifiée DSD (Digital Smile Design). « Ce concept permet de concevoir un sourire convenant parfaitement à la morphologie faciale de chaque patient, lui permettant de visualiser et de faire l’essai de son futur sourire avant le début du traitement en plus de participer à son élaboration, explique Dre Vachon. Cette percée technologique révolutionne la profession en tenant compte de la qualité de l’occlusion pour réhabiliter de manière esthétique le sourire. » Elle utilise pour ce faire la technologie de dentisterie 4D Modjaw™, qui enregistre et analyse en temps réel les mouvements de la mâchoire.
Autant de passion amène D re Vachon à consacrer non seulement plus de 300 heures par année en formations postuniversitaires pour perfectionner son art, mais aussi à vouloir partager son expertise auprès de ses pairs. « Voilà pourquoi j’aime autant collaborer avec les parodontistes Anne-Sophie Villeneuve et Simon Lafrenière, de Villa — Espace Paro, qui sont sur la même longueur d’onde que moi à cet égard, souligne D re Vachon. J’avais déjà un lien professionnel avec leur prédécesseur, Dr Marc-André Bélanger, et j’ai été impressionnée par la façon dont ils ont

poussé encore plus loin sa pratique, et surtout par le centre de formation Campus, un endroit idéal pour l’enseignement. Ils y ont réuni, au cœur de leur vaste clinique, tous les outils techniques et multimédias pour créer une salle de formation modulable et ultra fonctionnelle, incluant même un espace lounge pour favoriser les échanges plus informels. » La dentiste dit également apprécier la précision et la minutie qui caractérise les professionnels de Villa — Espace Paro, ainsi que la qualité des suivis et des rapports, sans compter l’accueil chaleureux et l’excellent service client, car les patients qu’elle y dirige sont très satisfaits. « Je me reconnais surtout, conclut Dre Vachon, dans ce désir manifesté par ces jeunes et dynamiques propriétaires d’aller toujours plus loin pour l’avancement de la profession et le bénéfice de la communauté dentaire qui l’anime. »


REDRESSEZ VOS DENTS EN DOUCEUR GRÂCE À DES GOUTTIÈRES TRANSPARENTES ET CONFORTABLES.
OBTENEZ UN SOURIRE SUR MESURE GRÂCE À LA TECHNOLOGIE DSD, VISIBLE EN 3D AVANT LE TRAITEMENT.
DRE NATHALIE VACHON, DMD AACD
PRENEZ RENDEZ-VOUS
418 614-6282 | INFO@IDGA.CA
871, GRANDE ALLÉE OUEST, SUITE 210, QUÉBEC (QUÉBEC) G1S 1C1
SYNERGIE ORTHODONTIE
f ondée en 1997 p A r d res c h A ntA le g rim A rd et mA riec l A ude p oulin, l A clinique d’orthodontie g rim A rd et p oulin, située A ux p romen A des b e A uport, s’est développée Au fil des Années Autour d’une philosophie d’excellence des soins et du trAvAil d’équipe. en 2018, d re p oulin A pA ssé le fl A mbe Au à d re l é A d rouin- gAgné tout en poursuivAnt sA prAtique en mode semi-retrAite
A fin d’ A ssurer une continuité en tr A nsmettA nt son expertise. puis, à l’Automne 2025, lA clinique est devenue synergie orthodontie pour mieux refléter l’esprit de collAborAtion prévAlAnt non seulement à l’interne, mAis
Aussi Avec les pAtients et les pArtenAires du domAine dentAire, notAmment les pArodontistes de villA - espAce pAro. le nouveAu nom illustre égAlement l’Adhésion des propriétAires Aux technologies de pointe.

En effet, afin de servir encore plus efficacement sa patientèle, Synergie Orthodontie s’est mise au tout numérique. « Nous faisons des empreintes digitales et proposons les coquilles transparentes Invisalign, ainsi que les broches de céramique très efficaces et esthétiques, fabriquées à l’aide d’imprimantes 3D, explique Dre Drouin-Gagné. L’équipe de près d’une vingtaine d’employées accompagne les patients avec écoute, expertise et bienveillance, offrant des solutions orthodontiques modernes et personnalisées. Nous travaillons vraiment en synergie avec eux, peu importe l’âge, afin de révéler la meilleure version de leur sourire », résume-t-elle.
Pour ce qui est de la collaboration avec Villa Espace Paro, les fondatrices étaient déjà en relation avec le parodontiste D r Marc-André Bélanger quand D rs Anne-Sophie Villeneuve et Simon Lafrenière ont acquis sa pratique. « Nous avons constaté avec quel professionnalisme ils poursuivaient la mission de leur prédécesseur, animés par la même préoccupation que la nôtre pour le bien-être des patients, raconte Dre Grimard. Par ailleurs, nos spécialités sont complémentaires, car tout déplacement des dents requiert un soutien gingival adéquat. La communication est claire et fluide. Mieux encore, ils ont placé la barre plus haut en créant cette impressionnante clinique. »
Les interventions orthodontiques ont un impact qui va bien au-delà du simple alignement des dents. « Nous sommes chaque fois étonnées de constater à quel point les patients, particulièrement les adolescents, gagnent en confiance et en estime d’eux-mêmes durant le processus, conclut D re Grimard. Si vous me permettez le jeu de mots, on les voit progressivement sortir de leur coquille… grâces à nos coquilles ! Et c’est ce qui est pour nous le plus gratifiant. »

Unir expertise et bienveillance pour sourire en toute confiance
Orthodontie pour enfants
Première consultation dès 7 ans
Orthodontie pour adolescents
Appareils fixes, aligneurs transparents, correction des malocclusions
Orthodontie pour adultes
Solutions discrètes et efficaces adaptées à votre mode de vie
Aligneurs transparents
Esthétique et confort
418 660-5409 info@synergieorthodontie.ca
3333, rue du Carrefour, bureau A-295, Québec (Québec) G1C 5R9 synergieorthodontie.ca
AUCOIN ORTHODONTISTE
fondée pAr dr mArc-olivier Aucoin, lA clinique Aucoin o rthodontiste se distingue p A r une A pproche Authentique, un sAvoir-fAire technique et lA volonté profonde de redonner confiAnce à chAque pAtient, un sourire à lA fois. pAssionné pAr son métier, il se donne comme mission d’Avoir un impAct positif sur lA perception que chAque personne A d’elle-même.
Ce qui motive encore aujourd’hui l’orthodontiste, c’est la transformation tangible, significative et durable qu’il peut offrir à sa clientèle. Chaque réalignement dentaire est une occasion d’apporter un changement dans la vie de quelqu’un. Parmi ses souvenirs marquants, il évoque le cas d’une patiente dont le sourire retrouvé a incarné l’essence même de sa profession. Soucieux de l’excellence, il s’assure que chaque programme de traitement soit personnalisé et réalisé au moment le plus opportun pour le patient.
NATURELLE AVEC VILLA-ESPACE PARO
La collaboration entre Drs Marc-Olivier Aucoin, Anne-Sophie Villeneuve et Simon Lafrenière s’est naturellement imposée. Ex-collègues de Dre Villeneuve à l’Université Laval, ils partagent une vision commune : offrir les meilleurs soins possibles dans un cadre à la fois collaboratif et accessible. Leur complémentarité, entre orthodontie et parodontie, garantit une prise en charge harmonieuse et intégrée de chaque patient. Dr Aucoin souligne leur sens de l’innovation et de la proximité, ainsi que leur humilité : « Malgré le développement de leur entreprise, Anne-Sophie et Simon restent des professionnels intègres, profondément humains. » Ensemble, ils forment une équipe animée par la passion et le désir sincère de contribuer au bien-être des gens d’ici, instaurant ainsi une relation basée sur la confiance.

Chez Aucoin Orthodontiste, l’implication communautaire est une valeur fondamentale qui guide la pratique. Au-delà de son travail clinique, Dr Aucoin transmet son expertise à la relève par des cours et conférences sur le développement de la profession, notamment au campus de Villa — Espace Paro, une façon concrète de rester connecté aux besoins de son milieu.
Ce désir de donner au suivant trouve un écho chez AnneSophie et Simon, tout aussi engagés dans la formation continue et des causes significatives, comme leur rôle actif à la Société dentaire de Québec. Pour Dr Aucoin, c’est cette vision commune fondée sur la générosité et cette volonté d’avoir un réel impact sur leurs patients qui reflètent parfaitement leur approche et la nature de leur pratique.

Villa – Espace Paro
ARMOIRES TARDIF
lA fAbricAtion de mobilier sur mesure représente un véritAble tr AvA il d’orfèvre. c ’est une discipline qui exige p A ssion, rigueur, Attention Aux moindres détAils et compréhension Approfondie des mAtériAux Ainsi que des besoins du client. c ’est A insi qu’Armoires tA rdif, de sA inte- mA rie, en b e Auce, A relevé Avec brio le défi de concevoir et d’instAller le mobilier de lA clinique villA – espAce pAro, un contrAt qui comportAit d’inédites pArticulArités.

Depuis trois générations, Armoires Tardif perfectionne ses processus de fabrication pour offrir aujourd’hui une irréprochable qualité. Ses origines remontent à 1979, alors que Paul-Henri Tardif, déjà actif depuis 1964 dans le domaine de la construction, fonde l’entreprise que l’on connaît aujourd’hui. En 2003, l’homme d’affaires en cède la direction à ses quatre enfants, Céline, Alain, Clémence et René, et en 2024, l’un des fils de ce dernier, Francis, présent dans l’usine depuis une quinzaine d’années, reprend le flambeau, partageant avec son père les rênes de la compagnie.
« C’est par l’intermédiaire d’un collaborateur que nous avons été mis en contact avec les propriétaires de Villa – Espace Paro, explique Francis Tardif. Notre mandat était de concevoir et d’installer, en collaboration avec Agence Spatiale, tout le mobilier sur mesure, notamment dans les salles de traitement, où les demandes sortaient de l’ordinaire. En effet, D rs Anne-Sophie Villeneuve et Simon Lafrenière avaient comme exigence des comptoirs mur à mur en forme de U touchant trois côtés des salles, ce que nous n’avions jamais fait auparavant dans les projets dentaires, poursuit M. Tardif. Heureusement, ils savaient précisément ce qu’ils voulaient, de telle sorte que nous avons rapidement eu l’heure juste pour répondre à leurs besoins. Nos 45 ans d’expérience et notre centre d’usinage robotisé ont permis à l’équipe de rencontrer les critères élevés de ce type d’installation complexe. Ce projet nous a demandé près de trois mois de travail à l’automne 2022. »
Armoires Tardif a d’ailleurs signé une importante collaboration avec Sinclair Dentaire concernant la fabrication de mobilier à l’intention des cliniques, une entente en échange de laquelle le fournisseur aidera le fabricant beauceron à développer davantage son expertise dans ce domaine. « Nous pourrons donc, conclut Francis Tardif, offrir un produit local de qualité aux dentistes d’ici. »


« l’effet wow en chirurgie buccAle et mAxillo-fAciAle, voilà ce que je souhAitAis déjà susciter comme impAct en prAtique privée quAnd j’Ai démArré orosphère en jAnvier 2010, exprime son fondAteur, dr jeAn-philippe fréchette. pour y Arriver, je devAis compter sur une équipe orgAnisée et dédiée cApAble de s’occuper des détAils en Amont Afin que je puisse offrir toute mon expertise, non seulement Au pAtient, mAis à nos dentistes référents. » Après 15 Années d’Activité, l’orgAnisAtion compte
Aujourd’hui cinq chirurgiens et trois collAborAteurs Assistés d’une brigAde d’une trentAine de personnes complices de cette mission AlliAnt l’excellence des soins à une Approche client visAnt une expérience optimAle.
Champ d’expertise extrêmement pointu, la chirurgie buccale et maxillo-faciale consiste à traiter les problèmes de la bouche, des mâchoires et du visage, bref, la sphère orofaciale illustrée par la raison sociale de la clinique du boulevard Laurier. Jusqu’à 11 années d’études universitaires sont requises pour exercer. « Mon objectif de départ était d’évoluer majoritairement dans un contexte privé — une réalité familière aux dentistes avec lesquels j’entendais collaborer — et pratiquer de façon secondaire dans le secteur public, une vision qui était à l’opposé du courant à l’époque, explique D r Fréchette. Je souhaitais développer au maximum le concept de service à la clientèle. Quand Dr Martin Gaboury s’est joint à moi à l’été 2013, il apportait une complémentarité, étant donné sa formation à l’Hôpital de l’Enfant-Jésus davantage axée sur les chirurgies majeures en milieu hospitalier. » Ce dernier a ensuite quitté pour se surspécialiser en Belgique. « À mon retour en 2015, poursuit Dr Gaboury, nous nous sommes associés pour devenir copropriétaires l’année suivante. »

Martin Gaboury et Dr Jean-Philippe Fréchette
En 2022, Dre Claudya Aubry a joint l’équipe ; elle était la première à Québec dans le domaine maxillo-facial à détenir la double diplomation de dentiste et médecin à la suite de la refonte du programme. Cette réalité est également partagée par Dre Catherine Baillargeon-Audet, qui est entrée en poste au début de 2025. « Logique, dit Dr Fréchette, car nous sommes constamment à la frontière entre le médical et le dentaire. » Un moment important dans la croissance de la clinique est survenu en 2023 avec l’arrivée de Dr Carl Bouchard, chirurgien sénior également professeur titulaire à l’Université Laval et codirecteur du programme de chirurgie buccale et maxillo-faciale. Cela dit, Dr Fréchette possède une surspécialisation en chirurgie de l’articulation temporo-mandibulaire, Dr Gaboury en chirurgie plastique et esthétique du visage, tandis que la réparation des nerfs intéresse particulièrement Dr Bouchard. L’équipe est complétée par Dr Éric Lessard, spécialisé dans les douleurs complexes, D re Marie-Lou Landry, spécialiste en prosthodontie, ainsi que D re Geneviève Romanesky, dentiste généraliste avec une expertise en troubles de l’articulation temporomandibulaire. Bref, des compétences très variées qui font en sorte qu’OroSphère ratisse large dans ses champs d’intervention. « À ce propos, ajoute Dr Fréchette, nous avons convenu d’ouvrir l’actionnariat à nos spécialistes pour qu’ils se sentent encore davantage impliqués dans le développement de la clinique. Même si nous sommes encore dans la fleur de l’âge, nous pensons déjà à la relève. »


La croissance soutenue de l’organisation a d’ailleurs eu pour effet que la superficie de la clinique du 10e étage du Delta 3 a atteint sa pleine capacité en 2023. Pour continuer à progresser et à bien servir leur patientèle, Drs Fréchette et Gaboury ont opté pour une solution transitoire en ouvrant une succursale sur la rive sud en attendant la concrétisation de leur projet d’un grand centre médical spécialisé. Dans ce but, ils se sont portés acquéreurs du terrain sur lequel se dresse l’ancien restaurant Le Manoir du spaghetti, chemin Saint-Louis, à la tête des ponts. « Le dossier suit son cours, révèle Dr Fréchette, mais des considérations historiques en ont ralenti la progression, car l’établissement s’était greffé à la maison O’Gallagher, dont la construction remonte au milieu du XIXe siècle et qui présente un intérêt patrimonial supérieur. Chose certaine, cet audacieux projet verra le jour. »
Le bien-être des patients étant toujours en tête de leurs priorités, les propriétaires ont innové durant la Covid. OroSphère a en effet été la première clinique au Québec dans cette spécialité à conclure un partenariat avec un CISSS, celui de Chaudière-Appalaches, pour effectuer des actes relevant du secteur public en cabinet privé.

« Cette entente nous permet une pratique hospitalière, mais sans les contraintes qui s’y rattachent généralement, explique Dr Gaboury, ce qui ne nous empêche pas de poursuivre nos interventions à l’hôpital. Il s’agit d’un véritable partenariat public-privé au profit du patient et d’une dispensation plus efficace des soins. »
« Je dis souvent, un peu à la blague, raconte Dr Fréchette, qu’au bout de chaque dent que je traite, il y a un être humain… Nous avons vraiment le désir de considérer l’ensemble de la personne, de prendre du recul afin de prévoir au mieux les conséquences possibles de chaque intervention. Cela va jusqu’à la sédation intraveineuse dont nous disposons pour réduire l’anxiété, entre autres exemples. Bref, nous ne sommes pas des techniciens exécutant des traitements, mais des professionnels qui soignent les gens. Et cela inclut également tous ceux et celles qui gravitent autour de notre pratique. » Chez OroSphère, tous les membres d’une équipe bien rodée contribuent à servir efficacement non seulement les patients, mais également les partenaires externes.
Parmi ces partenaires, Villa - Espace Paro occupe une place particulière. « Bien qu’évoluant dans des disciplines différentes, mais complémentaires, nous partageons avec Drs Anne-Sophie Villeneuve et Simon Lafrenière ce souci élevé du bien-être du patient et ce désir d’innover, et surtout de transmettre nos connaissances, observe Dr Gaboury. Nous nous sommes côtoyés durant nos études, et nous avons développé une belle complicité. » Leur partenariat a finalement débouché sur l’élaboration d’un cours sur les injections esthétiques — webinaires et séances pratiques — après que l’Ordre des dentistes eut légiféré pour permettre aux dentistes de procéder à ces injections dans le cadre de leur pratique. « Leur centre de formation, Le Campus — Espace de formation a réuni toutes les conditions pour mener à bien ce projet, continue Dr Gaboury. De plus, la manière dont ils ont conçu l’infrastructure, permettant des démonstrations en direct sur des patients grâce à leurs salles de traitement contiguës, a ajouté beaucoup de dynamisme à la formation. J’ai trouvé cela exceptionnel, surtout d’avoir pu réunir nombre de spécialistes. Nous avons formé jusqu’à maintenant cinq cohortes de dentistes généralistes, et ce n’est qu’un début. »
Lorsque l’on associe passion, expertise, audace et innovation à un intérêt supérieur pour l’humain, tous les défis ne sont-ils pas permis ?
/ Chirurgie orthognatique
/ Dent de sagesse
/ Esthétique du visage
/ Extraction complexe
/ Greffe osseuse
/ Implant dentaire
Pour en savoir davantage :
/ Pathologie
/ Radiographie 3D
/ Sédation intraveineuse
/ Traumatisme
/ Trouble de l'ATM
Clinique OroSphère de Québec 2875, boulevard Laurier, bureau 1050, 10e étage, Québec
Clinique OroSphère de Lévis 1100, boulevard Guillaume-Couture, bureau 100, Lévis
info@cliniqueorosphere.com | 418 704-7077 cliniqueorosphere.com

« n otre rôle consiste, grâce à l A technologie, à simplifier Au mAximum le quotidien des gens, que ce soit à lA mAison ou en entreprise », résume frAncoispierre thompson, qui tient, Avec yAnnick mAilloux, les rênes de tml i nform Atique. e n A ffA ires depuis presque 20 A ns, l’entreprise signe, pA rmi l’une de ses plus belles réAlisAtions, l’AudAcieux projet de lA clinique dentAire villA — espAce pAro, qui illustre p A rf A itement l’étendue des compétences de tml informAtique, Appuyées pAr une équipe hAutement quAlifiée. informAtique, domotique et cybersécurité réunies sous un même toit, dAns un domAine où les exigences sont pArticulièrement élevées.
Difficile de décrire en quelques lignes toute la complexité technologique d’un tel chantier. « En concertation avec l’ensemble des professionnels impliqués, incluant des
spécialistes du domaine dentaire, nous avons assuré la conception, la vente et l’installation de toute l’infrastructure informatique et de domotique dans la clinique ainsi qu’au centre de formation hautement technologique qui y est annexé, précise M. Thompson. Le nombre d’ordinateurs, d’écrans, d’imprimantes, d’appareils spécialisés — sans oublier les kilomètres de câblage nécessaires pour les relier — aurait de quoi surprendre. L’objectif était de répondre aux attentes de nos clients, car à la clinique Villa — Espace Paro, la technologie contribue à l’expérience. Un mur d’écrans informe les patients en temps réel et une gestion harmonisée de la musique crée une ambiance unique et mémorable. Quant au centre de formation, il a représenté un défi multimédia de taille, mais tout aussi stimulant, parfaitement aligné avec notre expertise. Les parodontistes propriétaires, Anne-Sophie et Simon, nous ont vraiment fait confiance du début à la fin. »


Le domaine de la dentisterie se démarque notamment par la taille imposante des données informatiques qu’il génère. « Tout ce qui touche à l’imagerie numérique et à l’impression 3D occupe énormément d’espace sur les serveurs, explique Yannick Mailloux. Il faut prévoir l’équipement en conséquence, car le dentiste doit avoir accès à l’information instantanément. Ça représente toute une logistique ! Et comme la quantité de données augmente sans cesse, nous procédons régulièrement à des mises à niveau du système. » En 2025, impossible de parler d’informatique sans aborder la protection des données. « Nos clients ont opté pour une technologie de détection et de réponse aux menaces 24/7 pour une cybersécurité complète du réseau, surtout en raison de la sensibilité des dossiers patients, poursuit M. Mailloux. Cela dit, nous avons choisi les ordinateurs de marque Lenovo pour des considérations de fiabilité, compatibilité, performance et durabilité. Pour ce qui est de la domotique, son installation est d’autant plus optimale lorsqu’elle est assurée par des experts en informatique, car les deux disciplines sont étroitement interreliées. »
Parlant de domotique, celle-ci connaît un essor remarquable chez TML Informatique. Sans grande visibilité publicitaire, mais portée par un bouche-à-oreille très efficace, ses spécialistes multiplient les installations personnalisées, autant sur le plan commercial que dans les résidences, toutes tailles confondues. « Ce qu’il faut retenir, c’est qu’une seule application vous permet de contrôler l’ensemble du fonctionnement de votre demeure, qu’il s’agisse de chauffage, climatisation, éclairage, gestion vidéo, informatique, Wi-Fi, sécurité, sonorisation, etc. Bref, tout pour gérer le plus simplement possible votre environnement. »
Pour toutes ses installations domotiques, TML Informatique entretient depuis longtemps une collaboration solide avec l’entreprise Control4, dont les solutions garantissent un fonctionnement optimal et sans tracas. TML Informatique détient d’ailleurs depuis nombre d’années la certification de niveau diamant et de salle d’exposition certifiée, les plus hautes qui soient accordées. Cette relation d’expertise a d’ailleurs mené TML Informatique à recevoir, lors du salon CEDIA de septembre 2025 à Denver, le Prix d’Excellence, honneur décerné au détaillant ayant enregistré la meilleure croissance dans l’est du Canada. « Ce prix, c’est à la confiance de tous nos clients que nous le devons. Cette distinction nous encourage à mettre la barre toujours plus haute et à rester à l’affût des dernières tendances afin de continuer à vous accompagner de manière professionnelle dans vos choix technologiques. Transformer vos environnements en espaces connectés, intelligents, sécuritaires, pour un quotidien plus facile et agréable. »
Pour en savoir davantage : TML Informatique 6020, boulevard Wilfrid-Hamel, Québec info@tmlinformatique.com | 418 380-2229 tmlinformatique.com

PRÉSENTÉ PAR
L’endroit où affaires et gastronomie se rencontrent

FONDATION IUCPQ

© Jacques Fortin, L'Antidote Médias
Francis Morin, directeur général de la Fondation IUCPQ
sA uver des vies et A méliorer le quotidien des pAtients. à l’institut universitAire de cArdiologie et de pneumologie de québec — université lAvAl, lA mission est clAire. Afin d’Appuyer celle-ci, l A f ond Ation iucpq joue un rôle clé en A giss A nt comme un puiss A nt levier pour l A recherche, l’innovAtion et les soins. à sA tête, frAncis morin, directeur générAl, porte une vision Ambitieuse : mobiliser dAns le but de créer un impAct durAble.
« Chaque dollar amassé, chaque projet soutenu participe à la mission de l’IUCPQ », lance-t-il avec conviction. En poste depuis peu, mais fort de ses 25 ans d’expérience en gestion, dont huit dans le secteur de la santé, Francis Morin aborde ce défi avec humilité et passion. « On a ici, à Québec, un joyau qui fait une différence bien au-delà de nos frontières. À l’aube de la cinquantaine, j’ai envie de contribuer directement à une mission qui génère un réel impact et lutte contre les grandes maladies sociétales. »
Rappelons que l’IUCPQ dessert plus de 2,2 millions de personnes et traite certains des cas les plus complexes au pays. Acquisition d’équipements de pointe, mais aussi formation des équipes médicales, développement de nouvelles pratiques et financement de la recherche : grâce à l’appui de la Fondation IUCPQ, des projets d’envergure voient constamment le jour dans les trois axes majeurs que sont la cardiologie, la pneumologie et la santé métabolique.
« Ces domaines touchent directement le quotidien des gens. Les avancées réalisées à l’IUCPQ ont des répercussions concrètes sur les soins, la prévention et la qualité de vie des patients. Mais pour que les idées puissent se matérialiser, la mobilisation de nombreux acteurs est nécessaire. Ainsi, chercheurs, médecins, patients, donateurs et communauté d’affaires doivent unir leurs forces » , tient à mentionner le directeur général de la Fondation.
Cette mobilisation essentielle et chère à Francis Morin prend tout son sens dans des projets tels que SynergiQC, une initiative révolutionnaire destinée à améliorer le dépistage du cancer du poumon, le plus meurtrier dans les pays industrialisés. Dirigé par Drs Philippe Joubert et Yohan Bossé, chercheurs au Centre de recherche de l’IUCPQ, ce projet unique mise sur la puissance de l’intelligence artificielle dans l’objectif de pouvoir mieux cibler les patients à haut risque parmi les 380 000 Québécois concernés.
L’approche est novatrice : combiner le profil génétique, les marqueurs métaboliques et les données d’imagerie médicale afin de créer un modèle prédictif complet. Objectif : identifier rapidement les personnes qui doivent passer des examens plus poussés, réduire les coûts et, surtout, sauver des vies. Pour y parvenir, les chercheurs s’appuient sur des ressources comme la Biobanque de l’IUCPQ, de même que sur les données du projet pilote déjà en cours. Et la Fondation IUCPQ est au cœur de cette avancée, grâce à son soutien financier, qui agit comme un véritable catalyseur pour transformer la science en solutions concrètes.

La philanthropie, un moteur de transformation
« La philanthropie est pour moi un moteur de transformation. Elle va bien au-delà de contribuer financièrement. Elle permet de pérenniser des projets porteurs pour notre collectivité. Je crois qu’il faut mobiliser aujourd’hui pour changer demain, car ce que nous bâtissons tous ensemble, c’est un héritage pour les générations futures, souligne Francis Morin, directeur général. »

Josée Arsenault, présidente du conseil d’administration de la Fondation IUCPQ
depuis plus de dix Ans, le nom de josée ArsenAult est A ssocié à l A f ond A tion iucpq p remière femme à présider le conseil d’AdministrAtion de l’orgAnisAtion, lA mission poursuivie pAr l’institut universitA ire de c A rdiologie et de pneumologie de québec l’interpelle personnellement. opérée à c Œ ur ouvert, elle A elle-même été pAtiente à l’iucpq, où elle A constAté lA quAlité des soins qui y étAient offerts.
« J’avais une condition congénitale qui a fait en sorte qu’on a dû me remplacer une artère et une valve pulmonaire, raconte Josée Arsenault. J’ai alors réalisé à quel point j’avais été bien prise en charge. La directrice générale de la Fondation, à l’époque, était l’une de mes amies, et c’est elle qui m’a convaincue de joindre le conseil d’administration. À ce moment-là, je siégeais au conseil du Palais Montcalm. J’ai donc fait le saut de la culture à la santé. »
Celle qui cumulera en mai trois années à la présidence du conseil d’administration de la Fondation IUCPQ en mai — et qui occupe également un siège au conseil d’administration d’établissement de l’Institut — s’est donné le mandat de « propulser l’IUCPQ à un autre niveau » , de « prendre ce lieu d’innovation et de faire une différence » . Elle désirait ardemment apporter quelque chose de nouveau. Josée Arsenault l’admet spontanément : ce qui l’allume, ce sont les défis. En fait, elle y carbure.
« Quand je suis entrée au conseil d’administration de la Fondation, expose-t-elle, j’ai tenté de voir où je pourrais donner mon temps — car nous sommes tous des bénévoles —, et j’ai finalement accepté la présidence du comité de la grande soirée de la campagne de financement annuelle. Au cours des dernières années, celle-ci est passée d’un revenu net de 350 000 $ à 1,25 M$. Pour arriver à ce résultat, il a fallu se réinventer, dépoussiérer la philanthropie. »

Chaque année, la Fondation IUCPQ hausse son objectif, puis élargit son marché dans sa quête de dons auprès de la communauté d’affaires, dans sa recherche de commandites et de partenaires. À ce chapitre, elle se doit de compter sur un conseil d’administration diversifié, qui réunit plusieurs expertises complémentaires parce que chacun a son réseau. L’esprit de collaboration et la culture de transparence qui définissent la Fondation assurent son succès.
« Très ouverte et à l’écoute, notre organisation allie tradition d’excellence et vision d’avenir. La pérennité de la Fondation IUCPQ passe, bien sûr, par une relève qui pourra continuer à incarner l’innovation, l’audace. Notre conseil d’administration cherche constamment de nouvelles ressources, à évoluer, puis à y intégrer des idées novatrices et des passionnés. Quiconque est intéressé par notre fondation est invité à nous contacter… »
Josée Arsenault, présidente du conseil d’administration de la Fondation IUCPQ
Mon épouse et moi serons toujours reconnaissants envers l’Institut universitaire de cardiologie et de pneumologie de Québec (IUCPQ), anciennement connu sous le nom d’Hôpital Laval. Au début des années 1980, mon épouse a eu de graves problèmes d’asthme et elle a été souvent hospitalisée. Grâce aux soins exceptionnels prodigués par l’équipe de pneumologie et aux avancées de la recherche, elle mène aujourd’hui une vie tout à fait normale.
C’est pourquoi je soutiens, depuis longtemps, la Fondation IUCPQ. Je suis bien conscient du rôle joué par l'organisme dans le financement de la recherche, de l’enseignement et de l’acquisition d’équipements de pointe. Et je sais que c’est grâce à cet appui que l’IUCPQ peut demeurer un chef de file mondial en cardiologie, pneumologie et obésité-métabolisme. Faire un don à la Fondation, c’est contribuer concrètement à sauver des vies.
En février 2022, c’était au tour d’un de mes meilleurs amis d’être opéré à cœur ouvert à l’IUCPQ. Heureusement, il s’est rétabli avec succès. Peu après, un autre ami m’a raconté qu’il avait lui aussi subi une importante chirurgie cardiaque malgré une excellente condition physique. Apprendre que sa maladie était d’origine génétique m’a profondément fait réfléchir. Il faut dire que, de mon côté, les maladies cardiovasculaires sont malheureusement bien présentes dans ma famille. Mon père est décédé à 63 ans d’un arrêt cardiaque, et mon frère à 56 ans. Je savais donc que mes risques d’être touché par une telle condition étaient élevés.
L’année suivante, j’ai été invité à participer à la soirée Au cœur de vos passions , ce que j’ai accepté avec plaisir en reconnaissance des soins reçus par mon épouse et par soutien envers mes amis récemment traités. Ce fut une magnifique soirée !
Jamais je n’aurais pu imaginer qu’un an plus tard, ce serait à mon tour de me retrouver sur la table d’opération. À l’été 2024, à la suite d’examens approfondis à l’IUCPQ, j’ai appris que je devais sans tarder subir un double pontage. J’éprouvais depuis quelque temps un essoufflement inhabituel, même lors de mes longueurs à la piscine. L’intervention s’est déroulée

avec succès le 1 er août 2024. Évidemment, ce fut un grand choc pour moi et mon entourage. Mais c’est à ce moment que j’ai véritablement pris conscience de l’expertise unique des équipes de l’IUCPQ.
En mai 2025, c’est avec fierté que j’ai accepté de collaborer à la soirée Au cœur de vos passions à titre de conseiller en vins. Fort de mes 50 ans d’expérience en sommellerie, c’était pour moi tout naturel d’offrir mes services à une cause aussi significative. Savoir que les fonds recueillis soutiennent des projets prioritaires de l’IUCPQ me touche profondément.
Et mon histoire avec l’IUCPQ n’est pas terminée. Depuis mon opération, j’ai la chance d’être suivi par l’équipe du Pavillon de prévention des maladies cardiaques (PPMC), qui a joué un rôle déterminant dans ma remise en forme. Le 7 septembre 2025, à peine un an après ma chirurgie, j’ai participé pour la première fois au Cyclo-Défi Fondation IUCPQ, en complétant un parcours de 50 km à vélo, un accomplissement dont je suis très fier ! Mon épouse m’accompagne désormais dans mes entraînements au PPMC et, ensemble, nous gardons la forme et savourons chaque moment.
L’été prochain, nous célébrerons notre 50e anniversaire de mariage, et nous savons que c’est en grande partie grâce à l’IUCPQ et à sa Fondation. Merci du fond du cœur, notre reconnaissance est infinie !
Il est des soirées qui marquent les esprits, des instants suspendus où l’humain se rassemble autour de ce qui compte vraiment. Dans la douceur d’un soir de mai, alors que la nature s’éveille pleinement, un bouquet de fraîcheur devient plus qu’un simple assemblage de fleurs : il incarne un élan collectif, une volonté partagée de faire éclore un avenir plus sain.
Chaque fleur offerte ce soir-là est un geste de philanthropie, une promesse faite à la vie. Derrière ce bouquet vibrant de couleurs et de parfums, c’est toute une communauté qui s’engage à investir dans la santé, à soutenir une Fondation dont la mission est aussi ambitieuse qu’essentielle : créer la médecine de demain, maintenant.
La santé, comme un jardin, se cultive avec soin, patience et vision. Chaque don devient une graine d’espoir, semée pour soutenir la recherche, améliorer les soins et encourager l’innovation. Et lorsque près de 1000 personnes se réunissent autour de cette cause, c’est tout un territoire qui vibre au rythme de la solidarité.
Ce grand moment de philanthropie, prévu le 29 mai prochain, s’annonce comme un rendez-vous unique. À la veille des Fêtes et de l’hiver, alors que l’année s’apprête à tourner une nouvelle page, la Fondation invite chacun à inscrire cette date à son calendrier. Ce sera une soirée à l’image de son Institut : innovante, rassembleuse, tournée vers l’avenir.

Pour en savoir davantage : Fondation IUCPQ info@fondation-iucpq.org | 418 656-4999 fondation-iucpq.org
AvA ntAgeusement loc A lisé, conçu pour répondre
Aux enjeux environnementAux tout en privilégiAnt lA quAlité de vie de ses occupAnts : tel est l’environnement locAtif que propose l’immeuble lAforest.

Alors que les premiers occupants sont attendus dès l’été 2026, le projet Laforest incarne la génération montante des bâtiments durables. Entièrement développé et géré par le Groupe Statera, l’immeuble locatif exprime la ferme volonté de l’entreprise de réduire son empreinte environnementale sans compromettre le confort. Chacune des décisions architecturales et énergétiques a été mûrement réfléchie et saura s’accorder avec les valeurs des futurs locataires.
« Le bâtiment atteindra une réduction énergétique de 42,5 %.
Près de 25 % de la superficie sera consacrée à des espaces verts grâce à une place publique végétalisée, à des arbres en façade, aux jardins de pluie et aux toitures vertes qui y seront aménagés. En utilisant des matériaux de structure à faible impact, le projet diminuera de 21,2 % l’intensité carbone par mètre carré de plancher », souligne le président du Groupe Statera, Nicolas Constantin.
é rigé d A ns le très prisé quA rtier sA int- louis-defrAnce, près des ponts et Avec une vue imprenAble sur le fleuve sAint-lAurent, le nouveAu complexe A vrAiment tout pour plAire !
Comptant 13 étages, le Laforest se démarque non seulement par sa structure unique faite de bois massif, mais aussi par son système de géothermie. Il vise d’ailleurs la prestigieuse certification BCZ (bâtiment à carbone zéro), rare au Canada. « C’est un immeuble qui se doit d’innover. Nous avons beaucoup investi pour paver la voie à d’autres projets dans l’industrie et aller dans la bonne direction à l’égard du développement durable », évoque le président.
Du 2 ½ au 5 ½, plusieurs unités du complexe résidentiel offrent une vue exceptionnelle. Si le majestueux fleuve en constitue la pièce maîtresse, les ponts de Québec et Pierre-Laporte, la canopée environnante, de même que les Laurentides au nord, permettront aux occupants de profiter d’un panorama enviable. Dans un quartier bien desservi par le transport collectif — dont le futur tramway — et de grands axes routiers, le Laforest donne accès à divers services.
/ JOHANNE MARTIN

« Au rez-de-chaussée de l’immeuble se trouvent une pharmacie Proxim, un restaurant La Piazzetta et le Salon Beauté Intégrale. À proximité, une multitude de commerces comblent les besoins essentiels sans devoir prendre le volant… pour un quotidien simplifié et plus vert, lance M. Constantin. Du côté des unités, il y en a pour tous les goûts et à l’intention d’une clientèle variée, notamment les propriétaires qui vendent leur maison et qui désirent faire la transition vers le tout-inclus dans leur secteur. »

Fonctionnel et lumineux, chaque logement est en effet livré avec une série d’inclusions qui assurent la tranquillité d’esprit dans une perspective de qualité. Cinq électroménagers sont compris dans le coût de location, tout comme le chauffage, la climatisation et l’électricité. Les aires communes, telles que les terrasses du 13e étage, la salle de réception, la piscine, le sauna et le gym apportent aussi une valeur ajoutée.
Pilotée par Alexandra Drolet-Blouin, l’équipe de gestion de l’immeuble Laforest mise sur une approche inspirée du milieu hôtelier axée sur le confort et le service offert aux résidents. « J’ai acquis une solide expérience dans le service client auprès de différentes clientèles. Mon intérêt pour les relations humaines découle de mes années passées dans la restauration, où j’ai développé une véritable passion à cet égard, explique-t-elle. Je m’occupe actuellement de la mise en marché et de la location, et dès juillet prochain, je prendrai également la responsabilité du bien-être des locataires, ainsi que de la coordination des équipes d’entretien afin d’assurer un service attentionné et cohérent au quotidien. »
Dédiée au Laforest, Mme Drolet-Blouin sera accompagnée par Mathyas Giguère, gestionnaire des opérations, qui assumera les tâches relatives aux demandes d’ordre technique. Jeune professionnel organisé et très rigoureux, il possède une expérience en administration et complète un MBA en gestion immobilière. « Nous sommes une équipe complémentaire au service des gens ! », confirme le président.
Nicolas Constantin ne manque pas de rappeler que le projet Laforest affiche sans équivoque les ambitions de développement durable de Statera et de ses partenaires, notamment Fondaction. « Il s’agit de notre vision, et, comme groupe intégré verticalement, nous intervenons de la conception d’un bâtiment jusqu’à sa gestion pour qu’il reflète nos valeurs. Groupe Statera est une entreprise pionnière et visionnaire ; le Laforest en la preuve ! », termine-t-il.
Pour en savoir davantage :
Groupe Statera - Projet Laforest 3100, rue de la Forest, Québec laforest.quebec@statera.dev | 418 658-2979 laforest.dev
depuis lA nAissAnce de lemAymichAud en 1979, l’Adn de lA firme est demeuré intA ct, se fA is A nt même A cronyme : Architecture, d esign… et le « nous » illustr A nt l’importA nce c A pitA le de l’hum A in. pA ssion et collégi A lité Au sein de l’équipe, écoute Attentive de lA clientèle et fructueuse complicité Avec les professionnels pArtenAires. « l’humAin est effectivement Au cŒur du processus cré Atif, insiste Alexi lemAy, Architecte Associé principAl. nous concevons pour — et Avec — des gens A fin de créer des univers qui vibrent Autrement et où on se sent profondément bien. décoder l’Adn de nos clients est donc notre g A ge de succès, cAr ceux-ci se reconnAissent d A ns les résult A ts. l es rel A tions d’AffAires de très longue dAte Avec notre firme — notAmment l A mAison simons — sont là pour en témoigner. »
L’histoire de LemayMichaud est jalonnée de relations d’affaires dont la profondeur a traversé le temps, et même les modes. « Mentionner tous les noms remplirait une page, précise M. Lemay, mais l'exemple de Simons, l’un de nos plus anciens clients, illustre particulièrement bien le genre de complicité que nous aimons établir et entretenir avec les entreprises qui nous honorent de leur confiance. » Tout a débuté en 1989 alors que Gordon Donald Simons a contacté Alain Lemay et Viateur Michaud pour leur soumettre des plans concernant un futur magasin à Place Ste-Foy. La réalisation terminée, l’homme d’affaires a de nouveau frappé à la porte deux ans plus tard avec un projet audacieux pour les Galeries de la Capitale, alliant l’inspiration de l’Antiquité aux tendances contemporaines. Toutes les autres adresses — 19 au total — ont suivi partout au Canada au fil des années, sans compter les réaménagements qui en découlent. « Bien au-delà d’une stricte relation fournisseur-client, continue l’archi-

Les associés du bureau de LemayMichaud à Québec : Assis à l’avant-plan : Hugues Voisine, architecte associé ; et Philippe Blais, architecte associé.
Rangée arrière : Katrine Beaudry, associée principale et B. Arch./designer ; Jérôme Henné, associé principal et architecte ; Marie-Christine Baillargeon, associée principale et architecte ; Pierre-Alexandre Davignon, associé principal et architecte ; Annie-Claude Gilbert, designer associée ; Jonathan Pelletier, architecte associé ; Alexi Lemay, associé principal et architecte ; et Kevin McCandless, associé principal et architecte.
tecte, nous privilégions plutôt un accompagnement ainsi qu'un véritable partenariat grâce auxquels nous pouvons mieux nous connaître et découvrir jusqu’où chacun est prêt à aller pour renouveler les concepts. Voilà ce que nous faisons de mieux. De l’innovation empreinte d’humanité, de rigueur et d’intégrité. Ce genre de relation permet d’atteindre une belle proximité. Voilà qui explique la pérennité de nos partenariats, qui se poursuivent même quand les entreprises connaissent un changement de dirigeants. »
Cette ouverture à ce qui sort des sentiers battus tend à rejoindre des clients visionnaires et engagés. Ainsi, le magasin Simons des Galeries de la Capitale a été porteur d’innovation en 2017 par sa capacité à atteindre la carboneutralité. « Nous avions testé ce concept au Londonderry Mall à Edmonton pour réduire de 40 % l’empreinte écologique, explique M. Lemay. À Québec toutefois, le nombre de panneaux photovoltaïques sur le toit et sur le stationnement génère autant d’énergie que ce que consomme le
magasin annuellement. Déjà en 2013, j’en parlais avec Peter Simons. Grâce à une collaboration étroite avec nos partenaires, dont les firmes d’ingénierie, nous avons su unir les bonnes expertises pour transformer cette vision en réalité. »
Ce qui distingue le plus LemayMichaud ?
« Au-delà des plus inspirants concepts d’architecture et de design, la qualité du service à la clientèle arrive en tête de liste, assure Marie-Christine Baillargeon, architecte associée principale. À nos bureaux de Québec, Montréal et Ottawa, cette façon de faire se manifeste naturellement, portée par une équipe qui, au quotidien, incarne pleinement notre philosophie : fournir le meilleur service possible. Ils savent qu’ils doivent y consacrer le temps voulu, car tout doit concourir au succès de chaque projet, qui n’est jamais le nôtre, mais d’abord celui du client, dont la satisfaction et la réussite passent bien avant les considérations d’égo.
C’est aussi une question de respect mutuel, d’écoute et d’empathie. Une sincérité et une transparence s’installent alors dans les relations, ce qui conduit à la réalisation de projets hautement personnalisés, et nous le faisons vraiment avec cœur, dans un esprit de service. Aussi, lorsque nous sommes invités à des inaugurations, nous prenons vraiment plaisir à célébrer avec nos clients. »
Simons Galeries d’Anjou, Montréal

Simons Galeries de la Capitale, Québec
Alexi Lemay rappelle à cet égard que, lorsqu’on lui demande quel est le style architectural qui caractérise le plus LemayMichaud, il répond sans hésiter : « Celui de nos clients ! » Marie-Christine abonde dans le même sens : « Par exemple, quand nous développons les concepts pour les magasins Simons, nous sommes à l’affût de détails et de raffinements qui collent à la marque, comme des éléments architecturaux rappelant les textiles ou des panneaux de façade faisant référence au tissage. On s’exprime d’autant mieux à cet égard que le client nous donne le feu vert. Et ce qui s’applique à Simons vaut pour chacun de nos clients. Nous pourrions aussi parler de Germains Hôtels, une entreprise avec laquelle nous entretenons une relation de longue date. Possédant lui aussi 19 établissements au pays, ce client aime qu’on intègre à ses projets une saveur locale. Ainsi, un Alt à Halifax sera différent d’un autre de la même chaîne à Montréal. C’est aussi à la demande de la famille Germain que nous avons commencé à réaliser au Canada des hôtels-boutiques, un concept qui avait vu le jour aux États-Unis. » D’ailleurs, le premier établissement de ce genre au pays porte la signature de LemayMichaud dans le Vieux-Québec. Le Groupe Strøm constitue un autre bel exemple de partenariat durable. Ce type de clientèle amène architectes et designers dans une autre réalité en matière de livrables, car il s’agit non seulement de satisfaire le client, mais de toucher également les personnes qui fréquentent ses établissements.
LA CROISSANCE SE POURSUIT
Étroitement lié à celui de sa clientèle, le succès de LemayMichaud continuera d’alimenter la croissance de la firme, qui lorgne du côté du marché ontarien à partir du bureau de la capitale fédérale. « Nous créons des espaces pour qu’ils soient vécus et suscitent un ressenti, conclut Alexi Lemay, tel est l’objectif ultime de nos créations. »
Pour en savoir davantage :

© Marc Cramer
LemayMichaud Architecture Design 111, rue Saint-Pierre, Québec quebec@lemaymichaud.com | 418 694-1010 lemaymichaud.com
BERNIER BEAUDRY
en 2025, le cAbinet bernier beAudry célèbre ses 75 Ans. cette longévité pourr A it en étonner cert A ins. comment un bureAu d’AvocAts et de notAires pourrAit-il être Aussi âgé que ses fondAteurs, roger beAudry et michel bernier ? comment, à ce jour, est-il toujours bien en vie et réussit-il à prendre encore de l’expAnsion ? ouvrons les portes de lA mAison pour le découvrir.

Roger est né en 1950, et Michel en 1949. En 1950, l’étude reçoit pourtant ses premiers clients. Cette coïncidence semble certes improbable. Voyons comment la réalité l’éclaire. L’équipe donne des conseils et trouve des solutions sous l’égide première de Cossette, Legendre et Lafrenière. À l’époque, il s’agit d’une société nominale au sein de laquelle les avocats exercent à leur compte. Le temps amène
son lot d’avocats dans la pépinière jusqu’au jour où Michel l’intègre comme étudiant, en 1970. Le bureau fonctionne alors sous la dénomination de Lafrenière, Maltais, Langlois, Loubier. En 1975, Roger le rejoint et, en cinq ans, son nom avait déjà évolué pour Lafrenière, Maltais, Langlois, Bernier et Associés, Michel occupant une place suffisamment importante pour voir son patronyme s’ajouter à ceux du cabinet.
La même année, Michel et Roger engagent la transformation de la firme en une société réelle d’avocats. Aujourd’hui, même si des joueurs ont tiré leur révérence, c’est toujours sous le vocable Bernier Beaudry que l’entreprise continue de prendre du galon dans le paysage juridique.

La firme a traversé plusieurs étapes depuis sa création, mais elle a gardé l’essence de ce qui la caractérisait alors : la proximité avec les clients et l’esprit entrepreneurial. En effet, elle adopte une vision et une gestion très proches de celles d’une PME, dont les rouages s’articulent autour de processus structurés, d’une gouvernance limpide et d’une approche proactive tournée vers la croissance.
« Nous gérons notre bureau comme une PME, avec les mêmes défis, les mêmes ambitions de développement. Le modèle d’affaires s’est construit hors des sentiers battus. Nous en avons hérité et nous le cultivons », explique Manon, directrice générale et avocate. Cette approche permet aux avocats et aux notaires de se mettre à la place de leurs clients, principalement les dirigeants de petites et moyennes entreprises et d’institutions financières. Ils comprennent les enjeux d’une société : les décisions rapides, la gestion des priorités et les solutions sur mesure.

C’est cette philosophie qui guide également l’organisation du bureau et la dynamique interne. Aujourd’hui, l’équipe compte 65 collaborateurs, disséminés dans cinq succursales (Sainte-Marie, Thetford Mines, Saint-Georges, Québec et Montréal). Le personnel, surtout jeune, est épaulé par les professionnels plus expérimentés. Mais ces jeunes ont quelque chose de singulier : une sagesse dont tous se réjouissent. « Nous avons une relève dotée d’une vieille âme, portée par 75 ans d’histoire. Je vois une grande force là-dedans et je l’apprécie chaque jour », exprime Manon.
Cette nouvelle génération est rapidement exposée aux réalités du métier. Dès son arrivée, elle peut développer sa propre clientèle et travailler avec les séniors auprès des clients existants de toute importance. « Les recrues sont dans le bain beaucoup plus vite que dans de grands cabinets, souligne Jérôme, président et avocat, et je crois que cette confiance accordée leur plaît beaucoup et les aide à développer leur pratique. » Cette combinaison de jeunesse et de sagesse n’est pas sans apporter la réflexion et la proactivité dans lesquelles l’organisation puise notamment sa force.
La collaboration est au cœur du mouvement vers l’avant de l’entreprise : les dossiers ne restent jamais cloisonnés. Les avocats en litige, en transactionnel, en droit immobilier ou en construction et les notaires travaillent de concert pour traiter les dossiers dans l’intérêt supérieur des mandants. Toutes les ressources requises sont ainsi mobilisées, qu’elles soient sises à l’une ou à l’autre succursale. « Nous travaillons pour le bureau, pas pour notre champ d’expertise. Nous allons chercher ce dont le client a besoin, même si ce n’est pas nous personnellement qui l’apportons. Nous souhaitons avancer en équipe et non en vase clos », précise Jérôme.
Cette transversalité permet non seulement d’optimiser le traitement des dossiers, mais aussi de renforcer la cohésion d’équipe et d’entretenir une proximité tangible avec les clients. Un dossier à Saint-Georges peut ainsi être suivi par un collègue basé à Québec ou à Thetford Mines, sans que le client ait à franchir un autre seuil que celui de sa succursale la plus proche.

VIVANTE ET CONVIVIALE
Chez Bernier Beaudry, la synergie de groupe se manifeste partout, dans les affaires sérieuses comme dans les occasions récréatives. Pour fêter les 75 ans de l’entreprise, le comité de direction a organisé une activité chaque mois, et les participants se sont pressés au portail. Party country, cabane à sucre, mois de la femme, sortie familiale aux Galeries de la Capitale, gala de reconnaissance et autres temps forts entre collègues ont ponctué l’année.
Pour marquer plus encore cet anniversaire, la firme a réservé surprises et attentions à ses employés : sac de voyage, hoodie, casquette, verre et bière BB spécialement brassée pour l’occasion. Alex Lapointe, humoriste, a animé les festivités en prenant les rênes du Bal de feu, entraînant tous les participants vêtus de rouge dans une soirée haute en couleur.
Cette effervescence sociale reflète l’esprit du groupe : convivialité, complicité professionnelle et ingéniosité. Elle met d’ailleurs les jeunes à l’aise pour proposer des projets ambitieux, comme le gym aménagé au bureau de Québec, conçu et réalisé par le comité des jeunes développeurs. La formation de ce comité découle d’une idée de Manon de faire participer la relève à l’essor de Bernier Beaudry. Engagés, ses membres se réunissent toutes les trois semaines pour discuter du développement des affaires.

Cette vitalité interne trouve naturellement son écho dans la manière dont la firme innove et s’adapte pour répondre aux besoins de ses clients. Dans cette optique, elle expérimente des solutions destinées aux entreprises d’aujourd’hui : tarification fixe, impartition de certains services, gestion moins hiérarchisée. « Le marché s’oriente vers des coûts fixes annuels, étant donné que le budget horaire est très difficile à prévoir, reconnaît Jérôme. Nous voulons accompagner nos clients pour qu’ils puissent relever leurs défis en toute confiance. » Ces formules sont particulièrement appréciées des clients, qui peuvent ainsi planifier leurs dépenses et recourir à des services juridiques pointus.
Les 75 ans de Bernier Beaudry sont loin d’enseigner le statu quo. Ils sont le signe d’un ancrage fort et d’une capacité à se réinventer dans le temps et au quotidien.
Pour en savoir davantage :
Bernier Beaudry bernierbeaudry.com
Québec 3340, rue de la Pérade, bureau 300, Québec | 418 652-1700
Saint-Georges 11505, 1re Avenue, bureau 480, Saint-Georges | 418 227-7776
Thetford Mines
21, Notre-Dame Est, Thetford Mines | 418 338-3666
Sainte-Marie
287, avenue Marguerite-Bourgeoys, bureau 201, Sainte-Marie | 418 387-2922
Montréal
465, rue Saint-Jean, bureau 910, Montréal | 514 933-0081

dAns l’univers des soins médico-esthétiques, rAres sont les cliniques qui pA rviennent à conjuguer rigueur médicAle, regArd Artistique et AccompAgnement profondément humAin. lA muse s’impose comme l’une de ces Adresses singulières, où l’excellence ne se proclAme pAs : elle se ressent dès les premiers instAnts pAssés entre ses murs.
La philosophie de La Muse s’articule autour d’une conviction simple : la beauté authentique naît de l’harmonie. Plus qu’un lieu de soins, la clinique s’affiche comme un espace où l’on cultive aussi le mieux-être intérieur. On n’y cherche ni l’excès ni la transformation radicale, mais plutôt l’art du naturel, cette subtilité qui révèle l’éclat unique de chacun. Les fondatrices se sont donné une signature claire : la précision, la nuance… et le respect absolu des traits.
Aux commandes de La Muse depuis le mois de mars, deux professionnelles chevronnées unissent leur expertise : Dre Dorothée Dufour, médecin omnipraticienne passionnée de médico-esthétique, et Khaoula Zahar, infirmière clinicienne d’expérience. « Ensemble, nous avons choisi de créer une clinique où chaque personne se sent accueillie, comprise, puis accompagnée avec bienveillance; ça fait partie de ce qui nous distingue », note Mme Zahar.
Dre Dufour a développé une approche délicate, où l’injection doit se fondre naturellement dans le visage. « J’observe attentivement les expressions, le mouvement, le rythme propre à chaque physionomie. Mon objectif consiste à raviver, adoucir, rafraîchir, tout en préservant l’authenticité des traits, dit-elle. Je prône aussi la prévention : intervenir tôt, judicieusement, permet de ralentir l’apparition des signes du temps et d’obtenir des effets plus durables… »
Khaoula Zahar, quant à elle, met à profit sa précieuse expertise clinique. Celle-ci lui confère une rigueur, une sensibilité et une compréhension globale du corps humain qui se reflètent dans sa démarche. Formée en médicoesthétique et titulaire d’un diplôme d’esthéticienne, elle propose une vision complète du soin anti-âge, misant sur la douceur, la progression et l’écoute. Sa quête d’excellence maintient La Muse à l’avant-garde des meilleures pratiques.
Si la clinique se démarque, c’est également par sa façon d’accueillir et d’offrir ses services à chaque personne. Absolument rien n’est laissé au hasard ! Tous les clients sont évalués dans leur globalité par Dre Dufour et Mme Zahar, qui élaborent ensuite un plan de traitement sur mesure, par ordre de priorité, en tenant compte des besoins réels, du rythme souhaité et du budget disponible. Il s’agit d’une démarche qui se différencie des pratiques bien souvent observées.
« Ajoutons que nous travaillons aussi en équipe : esthéticiennes, infirmières, médecin et massothérapeute, créant un écosystème de soins cohérent et hautement professionnel. Ici, nous prenons le temps de comprendre, de conseiller, d’expliquer, de rassurer. Le but n’est pas de multiplier les interventions, mais de proposer des solutions adaptées, intelligentes et réellement bénéfiques. Il n’y a pas une recette pour tous ! », fait valoir l’infirmière clinicienne.
La Muse présente une gamme étoffée de services, allant des soins esthétiques classiques – épilation laser, peelings, photorajeunissement, resurfaçage, facial, etc. – aux traitements médico-esthétiques parmi les plus avancés : agents de comblement, neuromodulateurs, skinboosters, stimulateurs de collagène, PRP pour la peau ou les cheveux, technologies de remodelage corporel et facial. Et chacun de ces soins est prodigué avec rigueur et maîtrise.
« Nous nous illustrons, en outre, par une expertise très rarement offerte dans les cliniques médico-esthétiques : la santé intime féminine, poursuit D re Dufour. Grâce à la technologie EmpowerRF, nous sommes ainsi en mesure de traiter des conditions comme la sécheresse vaginale, l’incontinence urinaire, la douleur lors des relations sexuelles ou les séquelles de cicatrices, redonnant ainsi confort, confiance et qualité de vie à de nombreuses femmes. »

La Muse Clinique s’impose par la qualité de sa prise en charge, le haut niveau d’expertise de son équipe et sa culture particulière. L’établissement fait corps avec l’élégance, le souci du travail bien fait et une vision authentique du soin esthétique. Il est un espace où la beauté retrouve toute sa noblesse, où chaque visite devient une expérience personnalisée, inspirée et inspirante… à l’image des Muses, ces divinités de la Grèce antique sources de création.
La Muse 1440, rue Cyrille-Duquet, local 140, Québec info@lamuseclinique.com | 418 476-6215 lamuseclinique.com


d’un côté, céline dion, pAul mccArtney, billie eilish et les cowboys fringAnts. de l’Autre, les rempArts, lA wwe, des chAmpionnAts de boxe, des foules record pour le volleybAll et le hockey junior. depuis son ouverture en 2015, le centre vidéotron s’est imposé comme le lieu où québec vit ses grAnds événements, peu importe le spectAcle ou le mAillot. et vous, quel moment mArquAnt gArdez-vous du centre vidéotron ?
À l’époque, on débattait de son coût, de l’absence d’une équipe de la LNH et de la pertinence d’un tel amphithéâtre. Aujourd’hui, la vraie question est plutôt : que ferions-nous sans lui ? « Aujourd’hui, il n’y a plus grand monde à Québec qui souhaiterait se passer du Centre Vidéotron. C’est devenu
un élément de fierté, les gens se le sont approprié », répond Martin Tremblay, président de Gestev et acteur clé du projet depuis les premières négociations avec la Ville.
Depuis dix ans, près de 8 millions de billets ont été vendus pour plus de 770 événements culturels et sportifs, dont 325 matchs des Remparts de Québec. La salle accueille plus de 18 000 personnes en hockey et plus de 20 000 en mode concert. Ces chiffres placent régulièrement le Centre Vidéotron parmi les amphithéâtres les plus actifs au pays. « Si on réussit à attirer les grandes tournées, c’est parce que le public suit, spectacle après spectacle », insiste Martin Tremblay.
16 septembre 2015. Le premier grand test survient : Metallica monte sur scène. Quelques jours après la fermeture définitive du Colisée, le groupe inaugure la scène et confirme la capacité du nouvel amphithéâtre à répondre aux exigences les plus élevées. Suivent Madonna, Pearl Jam, Elton John, Paul McCartney et bien d’autres. Billie Eilish choisit Québec pour lancer sa tournée mondiale Hit Me Hard and Soft le 29 septembre 2024, un lancement qui a attiré l’attention des médias spécialisés et des fans de l’artiste bien au-delà de Québec. « Très peu d’amphithéâtres peuvent se vanter d’avoir accueilli autant de premières mondiales en si peu de temps, souligne Tremblay. Chaque fois, le message est clair : les artistes savent qu’ils seront bien reçus et qu’ils peuvent nous faire confiance. »
La scène locale y trouve aussi sa place. Les Cowboys Fringants, Salebarbes, Roxane Bruneau, PA Méthot et plusieurs autres remplissent la salle, rappelant que cet équipement appartient autant aux artistes d’ici qu’aux grandes têtes d’affiche internationales.


Pour le hockey junior, le Centre Vidéotron est devenu l’une des forteresses marquantes au pays. Les Remparts y attirent des foules parmi les plus importantes de la Ligue canadienne de hockey, avec un sommet lors du parcours vers la Coupe Memorial 2023, disputé devant des salles combles. S’ajoutent à cela des matchs hors-concours de la LNH, douze galas de boxe, dont certains combats de championnat, des événements de basketball et de volleyball internationaux, ainsi que des passages répétés de la WWE, qui consolident le statut de Québec comme ville capable d’accueillir du sport de haut niveau.
Parmi les moments les plus chargés en symboles, Martin Tremblay cite le retrait du chandail de Guy Lafleur en 2021 : « La salle debout, Lafleur avec sa famille, l’émotion à fleur de peau… On savait que l’on vivait un moment qui dépassait le sport. »

Il ne faut pas l’oublier : le Centre Vidéotron est né dans le tumulte. Contestations juridiques, débats sur le montage financier, scepticisme autour du fameux « retour de la LNH » Dix ans plus tard, le récit a changé. Pour Martin Tremblay, cette légitimité ne tient ni aux promesses ni aux slogans : « C’est un événement à la fois, un souvenir à la fois. Quand les gens ressortent avec l’impression d’avoir vécu quelque chose d’important, ils reviennent. »
Le Centre Vidéotron joue aussi un rôle économique notable. Pour les grands spectacles internationaux, environ 30 % des spectateurs viennent de l’extérieur de la grande région de Québec, estime M. Tremblay. Hôtels, restaurants et commerces en profitent directement. C’est sans compter le rayonnement que procure chaque première mondiale, chaque événement télévisé, qui projette le nom de Québec bien au-delà du boulevard Wilfrid-Hamel.
L’amphithéâtre s’inscrit en outre dans une démarche de responsabilité sociale et environnementale : certification LEED, optimisation de la consommation d’eau et d’énergie, réduction des îlots de chaleur, ainsi que la redistribution de surplus alimentaires à des organismes comme La Tablée des Chefs et d’autres partenaires. Pour le président de Gestev, cette dimension fait partie du contrat moral avec la population : offrir des événements majeurs en limitant l’empreinte environnementale et en redonnant concrètement au milieu.
La relation avec le milieu des affaires de Québec contribue aussi à la pérennité du lieu. Loges, salons corporatifs et événements-bénéfice témoignent d’un appui assumé d’entreprises qui ont choisi de s’identifier à cet équipement majeur, non seulement pour la visibilité, mais aussi parce qu’elles y voient un outil structurant pour la région.
Les dix premières années auront servi à démontrer que Québec peut se mesurer aux grandes salles nordaméricaines. La suite vise à consolider cette position. Le Centre Vidéotron accueillera le Championnat du monde de hockey féminin en 2027, puis le Championnat mondial junior en 2029, deux vitrines internationales qui confirmeront son statut d’amphithéâtre de calibre mondial et mettront à profit l’expertise développée sur la dernière décennie. « Notre promesse, c’est de continuer à faire du Centre Vidéotron un lieu où les gens vivent quelque chose d’assez fort pour avoir envie de revenir », résume Martin Tremblay, rappelant que la crédibilité de l’endroit repose d’abord sur l’expérience offerte au public.
Une décennie après les premières foules, le Centre Vidéotron n’a pas effacé tous les débats qui l’ont vu naître. Mais il est devenu ce que ses défenseurs espéraient : un lieu phare de la vie culturelle et sportive, un levier économique pour Québec et le théâtre de moments qui s’ajoutent à la mémoire de la ville.

Pour en savoir davantage :
Centre Vidéotron
250, boulevard Wilfrid-Hamel, Québec lecentrevideotron.ca

entre chAlets illuminés, vin chAud épicé, ArtisAns d’ici et personnAges emblémAtiques folkloriques, le mArché de noël AllemAnd de québec confère à notre cApitAle, pendAnt tout le mois de décembre, lA mAgie des contes des frères g rimm. p our s A 18 e édition, l’événement déploie cinq sites, 125 exposAnts et plus de 200 AnimAtions grAtuites.
Le Marché de Noël allemand de Québec (MNAQ) s’impose aujourd’hui comme l’un des plus beaux marchés du genre en Amérique du Nord. Pour son 18e anniversaire, il revient au cœur du Vieux-Québec avec une programmation bonifiée, cinq sites à distance de marche l’un de l’autre et une signature claire : faire vivre, ici même, l’authenticité des grands marchés de Noël européens, en harmonie avec le charme historique de notre ville.
Place d’Youville : on s’immerge dans le Berg Dorf, le « village de montagnes », avec le téléphérique des jouets, une ambiance alpine et un Alpenbar animé. Le site donne le ton avec ses chalets chaleureux, ses airs festifs et son atmosphère conviviale, juste aux portes des remparts.
Aux jardins de l’Hôtel-de-Ville, plus grand site du marché, on retrouve les emblématiques cabanes typiques de la Bavière, une sélection d’artisans locaux, le Winter Bar, le calendrier de l’Avent, l’arbre à souhaits et des cartes postales géantes évoquant les Noëls d’antan. Les familles s’attardent naturellement au Kinder Chalet et devant le théâtre de marionnettes extérieur.
Sur la place de l’Hôtel-de-Ville, les visiteurs s’immergent dans les produits typiquement allemands : glühwein (vin chaud épicé, blanc ou rouge), stollen (gâteau de Noël allemand), bretzels, saucisses, pains d’épices et spécialités régionales. Un rendez-vous idéal pour les épicuriens qui souhaitent vivre un marché de Noël aux saveurs européennes, et ce, au cœur de la capitale québécoise.
Cette année, la rue Sainte-Anne se réinvente partiellement sur le terrain de la cathédrale Holy Trinity, transformé en petit village sous un ciel étoilé. Le décor soigné, intimiste et photogénique, invite à la flânerie, surtout en soirée.
Enfin, à la place d’Armes, le château du père Noël devient le royaume des enfants, où des éléments décoratifs colorés parsèment le parcours d’une touche féerique, invitant petits et grands à s’émerveiller. « L’important à retenir, c’est que le Marché de Noël allemand de Québec est tout simplement un événement qui fait du bien à tous », souligne la directrice générale, Olivia Lexhaller.

Olivia Lexhaller, directrice générale du Marché de Noël allemand de Québec

GUIRLANDE D’EXPOSANTS ET UNE EXPÉRIENCE GOURMANDE
Avec 125 exposants répartis sur ses différents sites (sauf à la place d’Armes), le MNAQ attire un nombre record de participants. L’événement met en valeur les artisans et producteurs du Québec tout en intégrant des produits allemands authentiques, créant un pont naturel entre terroir local et tradition européenne.
Objets faits main, décorations typiques de Noël, produits fins, créations d’ici, gourmandises européennes : le MNAQ est le lieu parfait pour trouver des cadeaux originaux, voire uniques, ou pour compléter vos achats du temps des Fêtes.
SAINT-NICOLAS, KRAMPUS ET CHRISTKIND : LA MAGIE EN MOUVEMENT
Ces personnages issus de la plus authentique tradition allemande animent les lieux et marquent l’imaginaire. Aux incontournables Saint-Nicolas et Krampus s’ajoute cette année la grande vedette : le Christkind , intégré comme troisième personnage phare dans la Marche des marionnettes géantes et qui se retrouve aussi au cœur d’une nouvelle histoire jouée au théâtre de marionnettes.


L’ambiance musicale suit cette montée en puissance : au Krampus Band, trio festif déjà connu, s’ajoute une formation féminine rock inspirée du Christkind. Trois musiciennes aux costumes colorés qui insufflent une énergie contemporaine et festive exceptionnelle.
Le Marché de Noël allemand propose également l’expérience Québec s’illumine, un circuit lumineux qui relie les sites et prolonge naturellement la visite vers le VieuxQuébec, le quartier du Petit-Champlain et le Vieux-Port. Lanternes, guirlandes et mises en lumière orchestrent une scénographie hivernale qui invite à poursuivre la découverte durant toute la saison froide.
COMMENT PROFITER PLEINEMENT DU MARCHÉ DE NOËL ALLEMAND DE QUÉBEC
Voici quelques recommandations visant à optimiser votre expérience.
/ Planifier votre visite : consultez le site Web officiel, les médias sociaux ou l’application mobile afin de repérer plus de 200 performances artistiques gratuites offertes sur l’ensemble des sites.
/ Choisir votre ambiance : pour une atmosphère festive et animée, privilégiez les samedis et dimanches, parfaits pour les bains de foule ; pour une expérience plus intime et tranquille, propice aux échanges avec les artisans, optez pour les jeudis et vendredis.
Marché de Noël allemand de Québec
Le Marché de Noël allemand de Québec est un rendez-vous à ne pas manquer du 20 novembre au 23 décembre 2025.
Place de l’Hôtel-de-Ville, Jardins de l’Hôtel-de-Ville, Place D’Youville et rue Sainte-Anne, Québec G1R 4S9
info@mnaq.ca | mnaq.ca
dAns un monde où le métier de préposé à l’entretien ménAger trAîne certAins préjugés, yAnn rAtiveAu vient ch A nger l A donne. c e b reton d’origine désormAis enrAciné Au québec A emmené Avec lui sA conception du ménAge de quAlité hôtelière, Après Avoir trAvAillé pour d’illustres entités, dAns le luxe et Auprès des meilleurs.
Yann commence sa vie professionnelle en expérimentant divers boulots avant d’embrasser la restauration. D’apprenti serveur, il passe chef cuisinier. Il dirige alors un restaurant sur la symbolique promenade des Anglais, sur la Côte d’Azur, que fréquentent nombre de touristes. Ce type d’établissement exige rigueur et souci du détail, qualités qui lui serviront à bon escient.
Sa première incursion dans le nettoyage n’est pas planifiée. Il rencontre à Nice celle qui deviendra sa femme, et l’entreprise pour laquelle elle travaille nécessite du renfort en conciergerie. Yann, déjà connu comme « le fou du propre », se porte volontaire. Jour et nuit, il s’affaire avec le même enthousiasme et la même minutie qu’en cuisine.
« Tandis que je frottais la porte extérieure d’un appartement, un concierge, qui connaissait bien son métier, m’a demandé pourquoi je m’attardais à cette zone en particulier. Je lui ai répondu que c’est l’endroit où le client pose d’abord le regard, que la première impression est capitale. »
Conquis, il n’est pas le seul. Tous les clients le sont, impressionnés par son œil affûté et sa main précise. Loko Clean, son entreprise du temps, va plus loin encore dans sa prestation. Yann accompagne même ses clients à l’aéroport, les guide vers les restos, bref, demeure à leur disposition.

Le couple décide ensuite de poser ses valises au Québec avec ses enfants, Ryan et Kylan, un rêve de longue date que caresse sa femme. « Je me sens attirée par le Québec. Je suis bien ici », confie-t-elle. Yann reprend son métier sur ce nouveau sol, et une cliente lui demande un jour ses numéros de taxes pour formaliser son administration. Cette requête fait naître officiellement Tsé Net en tant qu’entreprise.
Le nom choisi est une astuce linguistique et affectueuse venant de l’expression québécoise « t’sais ». Cette touche locale plaît instantanément aux clients, dont plusieurs le sollicitent pour cette marque d’appartenance. Yann débute modestement, avec deux clients par jour, mais sa réputation de méticulosité et de fiabilité se répand rapidement.
« Je ne tourne pas les coins ronds dans le ménage et je communique toujours avec mes clients. Quand on ne parle pas, le vase déborde » , explique-t-il. Pour Yann, chaque commentaire est un signal bienvenu dans une visée de perfectionnement.
C’est dans cette logique de doigté et d’amélioration que Yann adopte la « marche en avant », sa méthode fétiche de nettoyage. En suivant un ordre strict, il ne revient jamais sur ses pas, nettoyant chaque pièce de A à Z, du haut vers le bas. Il s’assure ainsi que rien — ni même les boutons de la cuisinière — n’est oublié.
Lorsqu’il fait une soumission, Yann apporte son matériel et prend le temps d’expliquer son utilisation, les étapes du processus d’assainissement ainsi que les aspects auxquels il accorde attention : « Alors que je quittais sa résidence, la cliente s’est exclamée : “Wow, tu as même lavé derrière les toilettes !” Spontanément, je lui ai répondu : “Wow, vous avez même vérifié derrière les toilettes !” », relate-t-il en riant.

FAIRE PLAISIR AUX AUTRES
Pour Yann, le ménage n’a rien à voir avec une corvée : c’est un acte de bienveillance. « Faire le ménage, ça fait du bien aux autres. J’aime faire plaisir à quelqu’un et le décharger d’une lourde tâche. » Cette philosophie, il l’applique à tous les clients, peu importe leur statut ou leur budget. « Je leur parle de la même manière, je fais le ménage de la même manière, avec le même soin », énonce-t-il. Avec plus de dix ans d’expérience dans le nettoyage de qualité hôtelière, Yann fixe des standards d’exception et n’oublie jamais le joli pli des serviettes.
Pour en savoir davantage :
Tsé Net 1097, rue des Gadelles, Lévis ryann3113@gmail.com | 581 909-4117 entretienmenagertsenet.ca
SILENCIEUX GOSSELIN

d epuis 1957 , s ilencieux g osselin s’impose comme un Atelier reconnu dAns le domAine de l’entretien et de l A répArAtion de systèmes d’échAppement à q uébec. e n 2024 , trois pA rten A ires d’ A ffA ires ont repris les commAndes de l’entreprise instAllée sur le boulevArd centrAl, Aux Abords de l’Autoroute r obert- b our A ss A . l eur intention : préserver les vA leurs d’honnêteté et de tr A nspA rence qui ont fAit lA réussite de l’entreprise, tout en bonifiAnt l’expérience client, tAnt des pArticuliers que pour lA
clientèle commerciAle. mArc-vincent girArd, pierreo livier mA rcotte et v incent Aucl A ir ont investi un million de doll A rs pour demeurer à l’ AvA ntgArde : identité visuelle ActuAlisée, sAlle d’Attente réAménAgée, site web revisité et prise de rendezvous en ligne, imAge d’équipe hArmonisée Avec des vêtements Aux couleurs de l’entreprise, nouveAu service de remise en étAt des filtres à pArticules diesel pour véhicules lourds, les AméliorAtions ne mAnquent pAs.
Propriétaire de l’entreprise depuis ses 22 ans, Marc Gosselin cherchait une relève depuis un certain temps. Bourreau de travail, attaché à son équipe et à sa clientèle, il a voulu prendre le temps de trouver des repreneurs de confiance. Voyant le potentiel du garage, les trois entrepreneurs en quête d’une occasion d’affaires stimulante entament des discussions avec lui et en viennent à sceller l’entente. « C’est une transaction que nous avons tricotée avec lui, souligne Marc-Vincent Girard. Nous avons fait des calculs rapides : avec un parc automobile qui ne cesse de vieillir, et malgré la présence de plus en plus grande de véhicules électriques sur les routes, nous étions convaincus d’avoir assez de travail pour au moins les trente prochaines années. »
Les nouveaux acquéreurs ne sont pas issus du domaine de l’automobile. Durant la première année, ils prennent le temps d’effectuer une transition naturelle et de s’approprier le fonctionnement de l’atelier avant d’y apporter des changements. En effet, ils ont déjà des idées d’amélioration en tête. Marc Gosselin n’est pas très loin : il les accompagne durant les premiers mois, le temps de les laisser voler de leurs propres ailes. L’équipe en place est composée d’une quinzaine de personnes expérimentées, dont la plupart y travaillent depuis plusieurs années. Ils ont les valeurs de Silencieux Gosselin « tatouées sur le cœur » : honnêteté, transparence et travail bien fait.
L’équipe de Silencieux Gosselin
Rapidement, les propriétaires découvrent la popularité du « sans rendez-vous », qui existe depuis les tout débuts de l’enseigne. Chaque jour, du lundi au vendredi, les clients peuvent se présenter à l’atelier de 8 h à 10 h 30 pour y faire réparer leur véhicule. Le bruit causé par une partie endommagée d’un système d’échappement impose souvent d’agir rapidement. Doté de sept baies de service, l’atelier est en mesure d’effectuer les travaux en moins d’une heure dans la grande majorité des cas.
Pour ceux qui le préfèrent, il est désormais possible de planifier un rendez-vous par téléphone, sur le site Web ou au moyen de l’application mobile. Des plages horaires sont disponibles à partir de 10 h 30. « Planifiée ou non, chaque visite doit mener à la satisfaction du client » , mentionne Marc-Vincent Girard. La formule instaurée par Marc Gosselin demeure : « Si une pièce doit être remplacée, nous la remplaçons. Mais si nous pouvons la réparer, nous le ferons. C’est ce qui fait notre force et fait en sorte qu’en fin de compte, le client économise de l’argent et repart satisfait. » Et un client satisfait en parle inévitablement à d’autres. « Le bouche-à-oreille demeure toujours notre stratégie de communication la plus payante, ajoute Vincent Auclair. C’est la preuve que nos clients nous font confiance. » Membre du réseau de garages recommandés par CAAQuébec depuis plus de quarante ans, l’atelier privilégie l’utilisation de pièces de qualité, dont celles de la marque Walker, garanties à vie.

L’équipe ne répare pas seulement les systèmes d’échappement des véhicules des particuliers. Marc-Vincent Girard souligne l’importance de la clientèle commerciale, nommant au passage plusieurs entreprises connues de la région, autant privées que publiques, qui lui confient leur parc de véhicules. Attentive à leurs besoins, l’équipe a lancé le 1er septembre dernier Entretien DPF Québec — DPF pour Diesel Particle Filter (filtre à particules diesel).

Captant la suie et les particules fines émises par le moteur diesel des véhicules lourds, ce dispositif a pour fonction de réduire les émissions polluantes. Avec le temps, l’accumulation de dépôts de suie l’empêche de fonctionner correctement, nuisant au fonctionnement du véhicule. Afin de corriger la situation, Entretien DPF Québec propose une solution qui a fait ses preuves : le nettoyage à l’eau.
Neuf, un système DPF peut coûter, selon le modèle, de 5 000 $ à 20 000 $. « Le nettoyage que nous effectuons permet à nos clients de réaliser des économies majeures. Il leur en coûte de quatre à quinze fois moins qu’un remplacement de la pièce », indique Marc-Vincent Girard. Contrairement au nettoyage à l’air, le procédé à l’eau retire les dépôts dans les moindres recoins. « Nous fournissons au client un rapport de conformité qui lui indique l’état du filtre avant et après le nettoyage », ajoute Vincent Auclair. Le nettoyage est généralement effectué en 24 heures. L’étape de séchage est la plus longue : elle nécessite huit heures. Les éléments du filtre endommagés par la corrosion sont également réparés. Faisant appel à des équipements à la fine pointe de la technologie provenant de l’Italie et de la Californie, l’atelier aménagé dans les locaux de Silencieux Gosselin redonne une nouvelle vie aux filtres. Il offre également le service de cueillette et de livraison.
L’intégration de ce nouveau service aura nécessité un an de préparation et un investissement d’un demi-million de dollars. Entretien DPF Québec devient ainsi le seul atelier dans l’est du Québec, de Drummondville jusqu’au Bas-SaintLaurent, à offrir le nettoyage de filtres à particules diesel au moyen du procédé à l’eau. Désormais, les composantes n’ont plus à être expédiées à Montréal : le travail est réalisé sur place. « Pour les entreprises, la perte d’un camion durant une semaine coûte cher, affirme Vincent Auclair. Comme elles n’ont pas toujours la possibilité de garder des filtres à particules neufs sur leurs tablettes, nous voulons leur offrir le service rapidement. »
En ajoutant Entretien DPF Québec pour le nettoyage des filtres à particules diesel, Silencieux Gosselin répond désormais à l’ensemble des besoins de la clientèle commerciale en matière de réparation et d’entretien de système d’échappement, y compris la fabrication de pièces sur mesure pour les véhicules lourds.

Lionel Gosselin, soudeur de métier, a fondé Silencieux Gosselin en 1957. Après avoir été le roi du ring comme lutteur professionnel, il devient le roi du muffler. Situé sur le boulevard Langelier, entre la côte Salaberry et le boulevard Charest, l’atelier s’enracine rapidement dans le paysage automobile de Québec malgré une vive compétition dans ce secteur d’activité. Au début des années 1970, Marc, son fils, alors âgé de 22 ans, en devient l’acquéreur. Suivant les traces de son père, un homme travaillant et innovateur, il fait de l’honnêteté envers les clients la valeur qui lui a valu leur fidélité durant des décennies. En 1972, l’atelier fait partie des premiers membres du réseau de garages recommandés par CAA-Québec. Depuis plusieurs années, toutes les activités de Silencieux Gosselin sont réunies sur le boulevard Central.
Marc Gosselin peut continuer de savourer sa retraite. Soutenue par une équipe compétente, la nouvelle équipe de direction assure la continuité du commerce qu’il a dirigé pendant plus de cinquante ans avec la volonté ferme d’en préserver le statut de référence dans son domaine à Québec.

Pour en savoir davantage :
Silencieux Gosselin 1530, boulevard Central, Québec reception@silencieuxgosselin.ca | 418 688-1076 silencieuxgosselin.com

fondée en 1988, locAtion d’outils beAuport ( lob ) s’est imposée comme le princip A l A cteur indépend A nt d A ns le dom A ine de lA locAtion d’outils et d’équipements. bien enrAcinée dAns lA grAnde région de québec, l’entreprise est devenue une référence incontournAble pour les pArticuliers comme pour les professionnels. comptAnt plusieurs points de service strAtégiquement situés et forte d’une récente implAntAtion à troisrivières, l’orgAnisAtion ouvre un nouveAu ch A pitre de son histoire : une expA nsion provinci A le réfléchie et A mbitieuse. lob entend déployer son s Avoir-f A ire et s A réputAtion de fi A bilité sur un territoire plus vAste, tout en mAintenAnt l’excellence du service qui lui vAut sA renommée depuis près de quArAnte Ans.
UNE HISTOIRE D’ANCRAGE ET DE DÉVELOPPEMENT LOCAL
LOB a débuté comme un petit comptoir familial, attentif aux besoins des entrepreneurs et des particuliers de l’est de Québec. Au fil des décennies, l’entreprise a évolué en une référence régionale grâce à une approche centrée sur l’accompagnement client, la proximité et la fiabilité. Son expansion, d’abord organique, s’est étendue de Beauport à l’ensemble de la Capitale-Nationale et aux régions avoisinantes.
L’inventaire diversifié — du petit outil spécialisé à la machinerie lourde, nacelles, chariots élévateurs et engins d’excavation — reflète la volonté de LOB de répondre à tous les besoins, qu’il s’agisse de projets résidentiels, commerciaux ou industriels. Cette diversité d’équipements permet de s’adapter à chaque situation, tout en offrant aux clients un accès immédiat à des solutions fiables.

L’implantation à Trois-Rivières, concrétisée en janvier 2025, constitue une étape stratégique pour LOB. Grâce à un partenariat avec SLM Équipement, qui exploite un centre de mécanique pour machinerie lourde sur la rue Thibault, l’entreprise bénéficie d’un point d’ancrage opérationnel où elle déploie ses propres équipements et tient un comptoir de service dédié.
Cette initiative répond à un besoin exprimé par les clients eux-mêmes : de nombreux chantiers s’étendent au-delà de Québec, et ils souhaitaient continuer à travailler avec une équipe qu’ils connaissent et en laquelle ils ont confiance. « Nos clients peuvent désormais louer leurs équipements habituels, avec le même accompagnement, même loin de la région de Québec », souligne Sylvain Dea, directeur général et associé.
LOB se déploie ainsi progressivement en Mauricie, une région en plein essor dans la construction commerciale, de La Tuque à Louiseville, en passant par Saint-Tite et Bécancour. Dans un marché déjà dominé par de grands acteurs nationaux et régionaux, l’arrivée d’un opérateur indépendant apporte une nouvelle dynamique : proximité, rapidité de réaction et personnalisation du service.
Mais l’ancrage trifluvien ne se limite pas aux activités professionnelles. L’acquisition des Aigles de Trois-Rivières, équipe professionnelle de baseball de la Ligue Frontière, illustre la philosophie de LOB : contribuer activement à la vie locale et soutenir les jeunes générations. « En plus de servir nos clients, nous accompagnons les organisations sportives régionales, des jeunes joueurs aux équipes de calibre junior », précise M. Dea.
Sylvain Dea, directeur général et associé

LOB se distingue par sa capacité à concilier excellence technique et expérience client irréprochable. Chaque projet bénéficie d’une approche personnalisée : maintenance préventive, suivi proactif et intervention rapide en cas de besoin. La maintenance préventive ne se limite pas à de simples vérifications : elle anticipe les pannes, réduit les risques et garantit la disponibilité optimale de chaque équipement, qu’il s’agisse de nacelles, de chariots élévateurs ou d’engins de chantier. Pour compléter cette vigilance, la compagnie met en œuvre un service mécanique mobile : deux unités circulent sur les chantiers pour intervenir rapidement, minimisant toute interruption et assurant la continuité des activités. Une équipe de cinq représentants parcourt également la région pour maintenir un contact direct avec les clients, renforçant ainsi la relation de confiance qui fait la réputation de l’entreprise.

Remi Dubé, directeurs des opérations et associé ; Nicolas Rhéaume, représentant ; Serge Duplain, superviseur du bureau de commandes.
Au fil des années, LOB a démontré que son véritable atout ne réside pas seulement dans la qualité de ses machines, mais dans l’attention portée à chaque client et dans sa capacité à combiner excellence technique, adaptabilité et service personnalisé. Chaque projet bénéficie d’un accompagnement sur mesure, où la réactivité, la maintenance préventive, le suivi constant et le service mécanique mobile assurent la réussite des chantiers.
Cette combinaison de proximité, d’expertise, de fiabilité et d’engagement communautaire constitue un atout durable pour l’entreprise. Celle-ci ne se limite pas à fournir des outils performants : elle accompagne ses clients de manière attentionnée, en s’assurant que les équipements sont toujours disponibles et prêts à l’usage, et en réagissant rapidement aux besoins spécifiques des chantiers. Cette approche, constante et rigoureuse, fait de LOB un acteur respecté dans le secteur de la location d’outils et d’équipements, reconnu pour sa capacité à allier performance technique et service adapté à chaque projet.

Même dans un secteur traditionnel, LOB s’appuie sur la technologie pour soutenir sa croissance et améliorer l’expérience client. Ainsi, les systèmes de gestion d’inventaire sophistiqués, intégrant l’analyse de données, permettent d’anticiper la demande, de fluidifier la rotation des équipements et de garantir la disponibilité des outils les plus sollicités. Cette modernisation permet à l’entreprise de croître sans compromettre la qualité du service, offrant aux clients fiabilité et réactivité à chaque étape de leurs projets.
L’implantation trifluvienne illustre parfaitement cette philosophie : à juste une heure de Québec, elle facilite la logistique tout en maintenant la même qualité de service, desservant efficacement Portneuf, Lotbinière et la rive sud. Cette expansion s’appuie sur le dynamisme local : essor industriel et immobilier, infrastructures clés — voies ferroviaires et maritimes, élargissement de la route 55 et jonction stratégique des autoroutes 20 et 40 — qui contribuent à fluidifier les opérations et accroître la proximité avec la clientèle.
L’AMBITION DE LOB POUR 2027
« Cette expansion pave la voie au marché montréalais, affirme M. Dea. Nous avons déjà des occasions d’affaires, mais nous avançons de manière réfléchie et mesurée, sur les deux rives du Saint-Laurent. » L’objectif est clair : être solidement implanté à Québec, Trois-Rivières et Montréal d’ici 2027, tout en maintenant l’excellence du service et la confiance de la clientèle. Selon le directeur général et associé, la clé du succès réside dans la proximité avec les clients, la rapidité d’intervention et l’accès simplifié aux équipements. Avec fierté et détermination, il conclut : « Notre service est votre meilleur outil ! »

Pour en savoir davantage :
Location d’Outils Beauport locationbeauport.com
Québec
312, rue Seigneuriale, Québec 418 664-1902
Lévis
47, route du Président-Kennedy, Lévis 418 837-3686
Trois-Rivières
2440, boulevard Thibeau, Trois-Rivières 819 944-4086
en 2027, drolet ressorts célébrerA 100 Ans d’histoire, d’expertise, d’innovAtion et de pAssion Au service des propriétAires de véhicules lourds. depuis 1927, l’entreprise fAmiliAle dessert lA région de québec
Avec lA même énergie qu’Au premier jour — tout en repouss A nt s A ns cesse ses limites. c e pA rcours, trois générAtions de lA fAmille bAker l’ont fAçonné. de john à steve, puis à williAm et élisAbeth en 2020, chAcune A su fAire évoluer l’orgAnisAtion en mAriAnt
sAvoir-fAire trAditionnel et modernité. Aujourd’hui, les jeunes dirigeAnts, respectivement président et vice-présidente, reprennent fièrement le flAmbeAu. l oin des ressorts d’ A utrefois, l’entreprise est Aujourd’hui plus prospère que jAmAis, Avec trois entités corporAtives — drolet ressorts, vAnbec et services routiers r s. — représentAnt un rouAge essentiel de l’industrie locAle du véhicule lourd.

William et Élisabeth Baker, copropriétaires
Tout comme son père, William a fait ses débuts dans l’entreprise à l’âge de 15 ans, avant d’en gravir tous les échelons. Quant à sa sœur Élisabeth, elle s’est jointe à l’équipe en 2012. Les deux incarnent une relève solide et se complètent à merveille : William carbure à la gestion des opérations tandis qu’Élisabeth s’occupe de l’administration. Leur père est décédé en 2024, alors que, même retraité, il continuait à fréquenter ce lieu où il aura passé la majeure partie de sa vie. « Nous sommes extrêmement reconnaissants envers lui pour les valeurs qu’il nous a transmises en affaires, notamment la confiance en soi et la
liberté d’essayer, insiste Élisabeth. Il croyait que la meilleure école, c’était d’oser. » Son frère ajoute que cette latitude paternelle leur a donné beaucoup d’assurance, comme lorsqu’il a décidé d’ouvrir un nouveau centre de carrosserie. « Voilà pourquoi nous sommes toujours prêts à aller de l’avant avec de nouveaux projets, qui n’ont effectivement pas manqué dans les dernières années. En effet, faire progresser l’entreprise familiale a toujours été notre plus grande priorité, et cette croissance passe par la satisfaction de notre clientèle. Notre plus récente acquisition, Services Routiers R. S., le démontre bien. »

Succéder à son père a toujours été une évidence pour William. Passionné de moteurs et de mécanique, il ne s’est pas fait prier pour s’apprivoiser à l’atelier. « J’ai vraiment commencé au bas de l’échelle et j’ai exploré tous les aspects de l’entreprise, se souvient-il. Déjà, adolescent, j’assumais des responsabilités pendant mes études secondaires. J’ai aussi eu la chance de profiter des conseils d’un mentor, qui m’a appris à tirer mon épingle du jeu dans le monde des affaires, ce qui a davantage éveillé mon intérêt pour de nouvelles idées, et mon père m’a toujours soutenu dans mes décisions. » Quant à Élisabeth, c’est la commercialisation de la mode qui l’attirait. « Pendant mes études dans ce domaine, j’ai eu la piqûre pour la gestion et la comptabilité. À l’âge de 20 ans, alors que je venais de terminer le collège, ma mère, qui assistait le contrôleur à l’époque, m’a demandé de lui prêter main-forte… et je ne suis jamais repartie ! J’ai moi aussi commencé au bas de l’échelle et fait mes preuves par mon sérieux. En 2018, tout en travaillant à temps plein, j’ai entrepris des études en comptabilité, déterminée à assurer la direction du service et à contribuer activement, avec mon frère, à la croissance de l’entreprise. »
Face aux besoins croissants de la clientèle, Drolet Ressorts a créé en 2017 une division spécialisée en carrosserie de fourgons et de poids lourds située au 225, rue SaintSacrement, à proximité du siège social du parc industriel Saint-Malo. Cette initiative stratégique permet d’élargir la gamme de services offerts en y intégrant une expertise pointue en carrosserie spécialisée pour véhicules lourds, tout en maintenant les standards de qualité et de rapidité qui font la réputation de l’entreprise. La superficie de 4000 pi2 et les deux portes de service sont vite devenues insuffisantes. « En 2021, en pleine pandémie, et face à une demande toujours croissante, nous avons agrandi le centre, raconte William. Baptisée Vanbec, la filiale compte désormais 10 000 pi2 de superficie et six baies de service, sous la direction de Jérôme Alain, un ami d’enfance et un partenaire qui a toute ma confiance. Ayant aussi travaillé chez Drolet Ressorts pendant plusieurs années, il connaît donc très bien notre vision d’un service de qualité. »

Puis, en octobre 2025, Drolet Ressorts franchit une nouvelle étape dans sa croissance avec l’acquisition de Services Routiers R. S., un atelier de la rue Philippe-Paradis reconnu à Québec pour son expertise en carrosserie et en entretien de remorques et semi-remorques. Tout comme Drolet Ressorts, il s’agit d’une entreprise familiale ancrée dans des valeurs de respect, de rigueur et de qualité de service. « Ce sont désormais trois entreprises distinctes qui unissent leurs forces afin de diversifier nos services et de mieux servir notre clientèle », précise William. Pour les propriétaires, cette acquisition marque une étape clé dans la progression du groupe, par l’intégration de trois piliers complémentaires unis par la même vision.
Cette récente acquisition a porté à près de 60 le nombre d’employés, dont une quarantaine de mécaniciens répartis aux trois adresses. Chez Drolet Ressorts, deux quarts distincts s’étendent de 7 h 30 jusqu’à 2 h 30 du matin, du lundi au jeudi, et de 7 h 30 à 17 h le vendredi, avec deux directeurs de service. « En étant ouverts 19 heures par jour, on s’assure de donner une flexibilité d’horaire hors pair et un service rapide et clés en main adapté à la réalité des clients, dont le véhicule est leur gagne-pain, souligne Élisabeth. Nous en sommes conscients, et c’est pourquoi nous mettons tout en œuvre pour offrir un service rapide, complet et irréprochable, qu’il s’agisse d’inspection, de réparation, d’entretien, d'alignement ou de carrosserie. »
Drolet Ressorts se spécialise dans l’entretien et la réparation de flottes de véhicules pour nombre d’entreprises importantes dans une foule de secteurs d’activité qui requièrent l’utilisation de camions. Quand nos clients en possèdent des dizaines, nous les voyons plusieurs fois par année, de sorte que nous développons avec eux une certaine proximité qui va au-delà du lien d’affaires, explique William. Ça nous permet de bien les connaître et de leur fournir un service hautement personnalisé. Notre mot d’ordre : un parcours sans faute. Tous les travaux effectués dans notre atelier sont donc systématiquement revérifiés afin de prévenir les erreurs et d’offrir une garantie d’un an — pièces et maind’œuvre — sur la plupart des interventions. »

En 2013, William a obtenu de la Société de l’assurance automobile du Québec le mandat autorisant Drolet Ressorts à effectuer les inspections mécaniques annuelles de véhicules lourds. Hautement réglementée, cette responsabilité exige une rigueur absolue, tant dans les vérifications que dans les réparations effectuées à l’atelier. « Mon implication directe dans les opérations assure une qualité irréprochable et contribue directement à la sécurité routière, dit-il, car nous vérifions chaque année près de 3000 véhicules. Cela dit, même si la compagnie grandit, mon bureau demeure au cœur des opérations, ce qui me permet de rester sur le terrain, près de notre équipe et de nos clients. »
Élisabeth pilote également la présence de Drolet Ressorts et Vanbec sur les principales plateformes numériques, une initiative qui se démarque dans un secteur où peu d’ateliers de mécanique de véhicules lourds sont aussi actifs sur les réseaux sociaux. « C’est une façon de promouvoir notre expertise, de nous distinguer et d’aller à la rencontre de notre clientèle », explique-t-elle. Cette stratégie, combinée à la rigueur et l’expérience des équipes en atelier, a d’ailleurs valu à l’entreprise le prix Choix du Consommateur en 2024 et 2025, dans la catégorie Garage de mécanique et suspension de véhicules lourds à Québec.
Au cœur des valeurs de l’entreprise, le respect arrive en tête de liste. « Mon père a tout le temps eu une excellente réputation en affaires, explique William, car il était un homme de valeur. Nous avons grandi dans cette ambiance, de sorte que nous vivons une belle proximité avec nos clients, nous réglons les choses humainement. Voilà ce que nous avons notamment transmis à notre directeur du service, Philippe Bureau, un autre ami d’enfance, qui fait partie de l’équipe depuis deux ans. Ma porte est toujours ouverte, comme celle d’Élisabeth, nous saluons chaque employé par son prénom. Notre père nous a montré la voie, il avait ce don de se faire aimer et respecter, au-delà des mots. Parce qu’il était quelqu’un de bon. »

Le frère et la sœur sont unanimes, affirmant n’avoir jamais dirigé une si belle équipe avec autant de performance et de synergie. « Les gens qui nous accompagnent dans cette aventure, qu’ils soient directeurs, mécaniciens, contremaîtres, livreurs, responsables de chaque centre ou autres, conclut Élisabeth, participent avec bonheur aux activités que nous organisons en dehors de l’entreprise. Tout le monde est heureux de travailler ici. Et ça, nos clients le ressentent. »
Pour en savoir davantage :
Drolet Ressorts, Vanbec et Services Routiers R. S. 1275, rue de l'Ancienne Cartoucherie, Québec info@droletressorts.com | 418 687-5222 droletressorts.com

EMBLM
l ’époque covidienne et l’inévitA ble phénomène du télétr AvA il qui en A résulté étA nt derrière nous, pl A ce Au retour du bAlAncier ! Ainsi, nombre d’entreprises sont en mode séduction pour que leurs employés rentrent Au berc A il. s ouvent choyés à domicile, ceux-ci se feront tirer l’oreille si l’environnement qui les y A ttend souffre de l A compArAison. c’est ici qu’intervient emblm, leAder québécois en AménAgement de milieux de trAvAil commerciAux depuis 50 Ans. en quelques mots, on y fournit Absolument tout… sAuf le personnel ! l'objectif : fAire du bureAu une AttrAyAnte destinAtion.
Mobilier intérieur et extérieur, produits acoustiques, ergonomie, murs architecturaux, systèmes de cloisons et cabines, rangement, éclairage, espaces lounge, technologies multimédias collaboratives et art mural, la liste des champs d’expertise a de quoi impressionner. L’offre est résolument globale, ce que le président de l’entreprise, Éric Lavoie, qualifie d’approche à 360 degrés, qui va bien au-delà du mobilier traditionnel.
Cette transformation est portée non seulement par une équipe de direction engagée, mais surtout par les femmes et les hommes — plus de 110 employés — qui sont présents sur le terrain dans cinq régions du Québec. Chez EMBLM (prononcez EMBLÈME), la croissance passe par la mobilisation des talents et une culture d’entreprise axée sur le respect, l’engagement et le plaisir de travailler ensemble. « Comme le bureau doit de nouveau attirer les travailleurs, explique M. Lavoie, c’est dans cet esprit que nous développons, de pair avec des architectes, des designers et des dirigeants d’entreprise, des environnements adaptés aux nouvelles tendances, des zones de concentration aux aires de collaboration en passant par des espaces ouverts à la créativité et au bien-être. »
EMBLM tire son origine de MAB Profil, entreprise fondée en 1975 à Québec et dirigée jusqu’à tout récemment par Patrick Morissette. En 2017, l’homme d’affaires a mis sur pied, grâce à des acquisitions stratégiques, un regroupement de distributeurs de mobilier de bureau. Outre MAB Profil, la nouvelle entité inclut Bureautique N. Maltais (Sherbrooke), Solutions Zoom (Laval), Buromax (Trois-Rivières) et une succursale à Saint-Georges, en Beauce. Pour M. Morissette, aujourd’hui retraité, mais qui préside toujours le conseil d’administration en plus d’agir comme mentor, la raison sociale illustre « l’emblème » que représente l’entreprise pour ses clients ainsi que la synergie issue de l’union des forces. « Nous combinons d’une part un enracinement local permettant une très grande proximité avec nos clients, explique Éric Lavoie, et d’autre part, une couverture provinciale grâce à laquelle nous accompagnons des organisations ayant pignon sur rue à plusieurs adresses. C’est notamment le cas de Canam,

BRP et Soprema, ou encore du cabinet albertain de fiscalité et comptabilité MNP, qui a des bureaux au Québec, car nous sommes le seul distributeur de mobilier commercial à couvrir les principales régions de la province. Nos clients sont non seulement des petites, moyennes et grandes entreprises, mais aussi des institutions et organismes publics. Cela dit, les trois quarts des produits que nous incluons dans nos projets d’aménagement sont québécois et canadiens, qu’il suffise de mentionner Artopex — notre principal fournisseur et leader de notre industrie. »


Puisque l’expérience directe vaut plus que tout parce que les gens aiment mettre à profit leurs cinq sens, EMBLM a complètement repensé et réaménagé sa salle d’exposition de la rue Jean-Perrin pour rendre la visite la plus immersive possible. Une refonte signée par la firme d’architecture et design LemayMichaud.
« L’objectif était d’illustrer concrètement notre offre globale au-delà du simple étalage de mobilier et d’accessoires afin de mieux correspondre à la réalité de nos clients, que ce soit en matière de technologies, d’ergonomie et d’acoustique, précise M. Lavoie. L’impressionnant mur de verre incurvé signé par le fabricant italien Adotta et ceinturant la salle de conférence insonorisée a été un véritable coup de cœur lors de l’inauguration, l’automne dernier, qui marquait à la fois notre 50e et notre vision tournée vers demain. L’ambiance feutrée, l’aménagement ouvert et la division naturelle de l’espace ont également attiré l’attention. Il ne reste plus qu’à passer nous voir ! »
La nouvelle salle d’exposition, dont un espace de réunion a été baptisé Patrick Morissette en hommage au fondateur, comporte en outre un lieu de cocréation, où les clients sont invités à contribuer, en présence du designer, à l’élaboration de leur futur aménagement. « L’objectif est de faire en sorte qu’ils repartent avec leur plan idéal, poursuit Éric Lavoie. À l’aide de nos outils, ils peuvent ainsi tout modifier, les superficies, les teintes, les finis. En effet, comme ce sont eux qui vont habiter leur environnement, leur participation est essentielle, nous permettant ainsi de répondre au mieux à leurs attentes, et même de les surpasser. Il s’agit d’un service qui nous distingue vraiment. Nous invitons également nos clients à visiter les salles d’exposition de nos fournisseurs pour faciliter leur choix. » Au moment d’écrire ces lignes, le même exercice était en cours à la salle d’exposition de Laval, dont le lifting sera terminé au début de 2026. Toujours en mode développement, EMBLM lorgne à l'heure actuelle du côté d’Ottawa et Gatineau, ainsi que vers le centre du Québec et d’autres régions afin de couvrir au maximum le territoire.


Comme nous l’avons constaté, le télétravail a changé la donne dans les préférences des employés quant à l’atmosphère au bureau. « Ils souhaitent obtenir autant — et même plus — de points positifs qu’à domicile, notamment sur le plan de la tranquillité, indique M. Lavoie. Nous offrons donc à cet égard des solutions acoustiques de pointe. Pour séduire les télétravailleurs, nos environnements doivent favoriser la concentration, la collaboration ainsi que l’utilisation d’outils technologiques qui leur manquent à distance. » À l’ère du travail hybride, EMBLM est là pour outiller ses clients afin qu’ils puissent concurrencer le confort chez soi. « Voilà pourquoi nous parlons de solutions à 360 degrés permettant de stimuler le travail individuel autant que les interactions en groupe, bref, de dynamiser les équipes. » Pour ce faire, une entreprise de Québec, GPHY, a conçu une plateforme intelligente et intuitive de gestion de l'espace de travail hybride. Cette innovation permet aux employés de réserver en ligne des espaces au bureau et de synchroniser ainsi leur présence avec celle de leurs collègues. La technologie au service de l’humain.
Pour explorer ainsi les voies de l’innovation, les designers de l’entreprise sont alimentés d’abord par les fournisseurs, déjà très à l’affût des nouveautés du marché. « Nous participons également aux expositions majeures, comme NeoCon, à Chicago, le plus gros rendez-vous des acteurs de notre domaine en Amérique du Nord, mentionne Éric Lavoie. Et comme nous sommes davantage des experts en solutions d’aménagement, il nous faut la collaboration des professionnels que sont les architectes et les designers. Cela dit, ce qui rend notre offre unique au Québec, outre notre couverture provinciale, c’est notre offre et notre accompagnement complets pour nos clients de toutes tailles. »
Projet compagnie d'assurances de Québec
Cet enracinement local s’accompagne en outre d’un engagement social bien concret. Dans chacune des régions où elle est implantée, EMBLM soutient des initiatives qui contribuent directement au mieux-être des jeunes et des familles, qu’il s’agisse de Ski Ta Vie (Estrie), du Club des petits déjeuners (Montréal) ou des clubs Kiwanis (Québec). L’entreprise s’implique également au sein de l’École d’Entrepreneurship de Beauce, notamment à travers le Défi communautaire, qui mobilise les entrepreneurs pour financer des projets jeunesse. EMBLM offre par ailleurs à ses 110 employés une journée de bénévolat rémunérée afin qu’ils puissent s’engager auprès d’un organisme de leur choix. Enfin, sur le plan environnemental, l’organisation priorise les fabricants québécois et canadiens — dont Artopex — reconnus pour leurs pratiques exemplaires en matière d’ESG (environnement, social et gouvernance).
En bref, EMBLM s’inspire des tendances fortes pour créer des aménagements qui attirent, fidélisent et dynamisent les équipes. « Chaque projet est pensé pour être unique, humain et durable, conclut le PDG, et livrer une véritable valeur ajoutée. »
Pour en savoir davantage :
EMBLM
2800, rue Jean-Perrin, bureau 200, Québec info@emblm.com | 418 842-4100 emblm.com
CHRONIQUE
Assurances et gestion de risques
dAns un monde de plus en plus numérique, lA cybersécurité est devenue essentielle pour Assurer l A résilience des org A nis Ations. c ’est d A ns cette perspective que j ulie b éd A rd souh A ite nous introduire l’expertise de wAlid khAyAte, directeur de prAtique nAtionAle — cyberrisques et gestion intégrée des risques, bfl cAnAdA.
En matière de gestion des risques, il est possible d’atténuer, d’éviter, d’accepter ou de transférer ces risques. La cyberassurance relève de cette dernière approche : elle offre une protection financière contre les conséquences d’un incident de cybersécurité.
QU’EST-CE QUE
La cyberassurance est une police conçue pour soutenir les organisations lors d’incidents informatiques. Elle couvre généralement deux volets : les pertes directes subies par l’entreprise (première partie) et la responsabilité envers des tiers (troisième partie).
Les garanties portent souvent sur les violations de données, les rançongiciels, les interruptions d’activité, la cyberextorsion et les enquêtes réglementaires (Loi 25, LPRPDE).
Cependant, certaines exclusions s’appliquent : actes de guerre, terrorisme, incidents antérieurs, dommages matériels ou corporels, pertes causées par des systèmes obsolètes ou un manque de sécurité.
Pour obtenir une couverture avantageuse, il faut démontrer une hygiène numérique solide. Les assureurs évaluent attentivement les pratiques de sécurité : plan de réponse aux incidents, sensibilisation des employés, authentification multifacteur, sauvegardes et maturité des contrôles. Une entreprise bien préparée bénéficie de
primes plus faibles et d’une couverture plus complète. La cyberassurance ne remplace donc pas la prévention, elle la renforce.
Plusieurs idées erronées subsistent...
/ Premièrement, une cyberassurance ne couvre pas tout : des exclusions et conditions précises s’appliquent toujours.
/ Deuxièmement, elle ne concerne pas uniquement les grandes entreprises : les PME sont souvent les plus vulnérables et ciblées.
/ Enfin, elle ne dispense pas d’investir en cybersécurité. Au contraire, les assureurs exigent des preuves de contrôles adéquats avant de souscrire. La comparaison avec l’assurance de biens est révélatrice : la majorité protège ses immeubles ou équipements, mais néglige ses actifs numériques, pourtant tout aussi précieux.
L’EXPOSITION PERSONNELLE AUX CYBERRISQUES
Les cybermenaces touchent aussi les particuliers. Appareils intelligents, domotique et services infonuagiques créent de nouveaux points d’entrée pour les cyberattaquants. Beaucoup pensent que leur environnement domestique est plus sûr que leur lieu de travail, alors qu’il est souvent moins protégé. Les cybercriminels exploitent cette faiblesse, ciblant notamment les individus fortunés dont la sécurité numérique est insuffisante.
La cyberassurance agit à la fois comme bouclier financier et levier stratégique. Elle offre non seulement une indemnisation, mais aussi un accès à des experts judiciaires, à des spécialistes en communication de crise et à des équipes d’intervention. Intégrée dans une stratégie globale, elle favorise la prévention, renforce la préparation et accélère la reprise après incident.
Les cyberattaques ne sont plus hypothétiques, mais inévitables. Les organisations qui combinent pratiques de sécurité rigoureuses et couverture adaptée protègent efficacement leurs actifs, leurs opérations et leur réputation dans un environnement numérique en constante évolution.


julie bédArd ll b, mbA, Asc Vice-présidente, positionnement stratégique et relations d’affaires — Province de Québec
wAlid khAyAte Vice-président, directeur de pratique nationale — Cyberrisques et gestion intégrée des risques
CHRONIQUE
Entrepreneuriat
lA réussite en AffAires n’est pAs nécessAirement réservée Aux entreprises qui détiennent les meilleurs produits ou les mArges bénéficiAires les plus solides, mAis à celles qui inspirent le plus lA confiAnce, non seulement chez leurs clients et pArtenAires, mAis Aussi Au sein de leurs propres ressources humAines. si nous remontons jusqu’à l’origine l Atine, le terme « confiAnce » est une déclinAison du mot fides, qui signifie notAmment fidélité. ce lien pArticulier de confiAnce, ressource plus rAre de nos jours, ne sAurAit exister sAns cette prémisse fondAmentAle qu’est lA trAnspArence et son ingrédient principAl : une communicAtion ouverte. c’est Ainsi que cette trAnspArence, Au-delà d’un simple enjeu de vAleurs, devient un moteur importAnt de performAnce orgAnisAtionnelle, un Actif strAtégique. elle crée un climAt Au sein duquel les employés comprennent les décisions, les clients ressentent de lA crédibilité derrière chAque Action, et les pArtenAires font confiAnce Aux intentions.
Dans toute organisation, une communication interne transparente est synonyme de mobilisation et d’engagement, car des employés qui saisissent le pourquoi des décisions sont plus enclins à s’y rallier. Cela nourrit le sentiment d’appartenance ainsi que la responsabilité individuelle et collective, alors que des zones d’ombre suscitent immanquablement méfiance et démobilisation. Comme tout part de soi, la confiance interne dans une organisation est la source première de sa performance durable. Chez les dirigeants, le leadership transparent exige du courage, certes, mais contribue à faire de la vérité un outil de croissance. Nombre d’études le confirment : une culture de transparence améliore la rétention du personnel tout en réduisant les conflits internes et les erreurs décisionnelles, et accroît sensiblement la productivité et la satisfaction de la clientèle. Cela ne tombe-t-il pas sous le sens ?
Dans cette ère de surinformation, les clients, partenaires et investisseurs détectent rapidement toute incohérence entre ce qu’une entreprise affirme et les gestes qu’elle pose. Ainsi, les organisations qui communiquent clairement et en toute sincérité les défis auxquels elles font face affichent davantage de crédibilité. La transparence externe est non seulement un gage de fidélité, mais elle attire des partenaires partageant des valeurs similaires.
Puisque toute vérité n’est pas bonne à dire, la transparence stratégique repose sur une maîtrise du message, en sélectionnant les informations pertinentes selon le destinataire et en choisissant le moment opportun pour livrer l’information en y ajoutant des faits, des données et des perspectives d’action. En d’autres termes, il s’agit de démontrer que l’on contrôle les enjeux tout en gardant un équilibre entre omettre et trop communiquer.
En définitive, c’est en misant sur un dialogue clair, authentique et cohérent, à l’interne comme à l’externe, que les organisations se positionneront comme les leaders de demain. En tant qu'entrepreneure, je peux en témoigner : à performance égale, la confiance fera toujours la différence.


un thème de plus en plus souvent Abordé sur les médiAs sociAux est celui de l’AssurAnce mAlAdies grAves en propriété pArtAgée. cette strAtégie permettrAit, pour les entrepreneurs et professionnels incorporés, de retirer des sommes libres d’impôt de leur compAgnie et de réAliser Ainsi un rendement « sAns risque » intéressAnt. si l’AssurAnce mAlAdies grAves est tout à fAit légitime et peut combler des besoins bien réels, cette strAtégie, elle, est loin d’être sAns risque.
QU’EST-CE QUE L’ASSURANCE MALADIES GRAVES ?
L’assurance maladies graves offre une protection financière à l’assuré en cas de diagnostic d’une maladie spécifiquement couverte par le contrat (cancer, AVC, infarctus, etc.).
Lorsqu’une telle maladie est diagnostiquée et que l’assuré survit pendant la période exigée pour celle-ci, l’assureur verse un montant forfaitaire non imposable au bénéficiaire, qui peut l’utiliser à sa discrétion.
Un avenant de remboursement de primes peut être inclus et permet, si l’on n’a pas fait de réclamation, de se faire rembourser l’ensemble des primes payées après un certain délai (normalement 15 ans ou plus), ce qui met fin au contrat. En somme, cela revient à prendre une seconde assurance contre le « risque que la première assurance ne paie pas », ou contre le « risque de ne pas être atteint d’une maladie couverte ». Notez que les primes de l’avenant vont souvent du simple au double de celles du contrat de base.
FONCTIONNEMENT DE LA STRATÉGIE ET PROBLÉMATIQUE
La stratégie consiste à souscrire l’assurance par l’entremise de la société, mais à faire payer l’avenant par le particulier (d’où l'appellation « propriété partagée » ). En cas de non-réclamation, les primes seront remboursées à ce dernier, permettant
de contourner l’impôt qui aurait dû être payé sur un salaire ou un dividende. Or, malgré le fait que certains conseillers en sécurité financière en parlent comme si elle était « secrète » et « inconnue des fiscalistes », il n’en est rien. Ces derniers sont plutôt conscients du fait que les lois fiscales canadienne et québécoise ne traitent pas de l’assurance maladies graves, qu’un flou fiscal existe, et que les autorités pourraient adopter une position hostile à cette stratégie sans préavis.
Oui, certains fiscalistes y sont favorables, mais d’autres estiment qu’elle conduit à l’appauvrissement de nombreuses compagnies, ce qui expose leurs propriétaires — selon des dispositions actuelles — à une double imposition (avantages imposables pour les particuliers, non déductibles pour leurs sociétés), ainsi qu’à des pénalités et intérêts. Cela, sans compter les honoraires de leurs fiscalistes pour gérer les dégâts. Le fait que la stratégie n’ait pas été contestée par les autorités jusqu’à maintenant n’est pas une garantie pour l’avenir, surtout avec l’évolution des outils d’analyse de données grâce à l’intelligence artificielle, et lorsqu’on considère son horizon à long terme.

D’autre part, le fait de comparer cette stratégie à du revenu fixe pour la vendre aux clients comme un placement fiscalement avantageux — alors que leurs comptes enregistrés ne sont parfois même pas maximisés — est pour le moins douteux. La décision de souscrire l’avenant en est une distincte de celle de souscrire le contrat de base. C’est donc dire que « l’investissement » dans l’avenant a une probabilité non négligeable d’être une perte totale, en cas de survenance d’une maladie couverte, et qu’il ne s’agit pas d’un placement sans risque, même sans tenir compte du risque fiscal.
L’objectif de cette chronique n’est pas de fournir une réponse définitive sur le traitement que pourraient appliquer les autorités fiscales à cette stratégie dans le futur, mais plutôt de mettre en garde les investisseurs contre le risque auquel ils s’exposent s’ils la mettent en place. Ce choix est leur prérogative, mais il devrait être fait en toute connaissance de cause et en profitant de l’accompagnement d’un fiscaliste.





Aurélie Boutet, Anne Turcotte et Alexandre Boutet
« l’essence même de lA profession de courtier immobilier, c’est une présence r A ssur A nte et professionnelle à toutes les étApes d’une trAnsAction et une écoute sAns compromis des besoins du client », témoigne Anne t urcotte, qui, chez engel & völkers, trAvAille en équipe Avec ses deux fils, AlexAndre et Antoine boutet,
Ainsi que sA fille Aurélie boutet. c’est d’Ailleurs Anne que l’Agence AvAit choisie pour ouvrir le bureAu de québec en 2017. selon cette courtière Au long pArcours, ce genre d’AccompAgnement requérAnt plusieurs hAbiletés relAtionnelles ne fAit pAs bon ménAge Avec les considérAtions de volume. lA quAlité plutôt que lA quAntité.
Forts de leurs expériences client, de leur formation continue en droit immobilier, en architecture et en nouvelles technologies, et recherchant constamment l’excellence, Anne, ses fils et sa fille se sont taillé une place privilégiée à Québec dans la vente de propriétés haut de gamme. En 2024, la courtière a célébré à la fois quatre décennies comme designer et 20 ans dans le courtage immobilier. Sa carrière a débuté dans le design d’intérieur, puis s’est poursuivie par la signature de centaines de projets de rénovation et de construction résidentiels et commerciaux sans compter la promotion immobilière. Une réussite qui, à ses yeux, repose sur trois grands principes : authenticité, professionnalisme, travail. « À ce jour, j’ai vendu au moins une propriété par semaine depuis 2004, pour près d’un milliard de dollars en volume de ventes. L’an dernier, notre famille a totalisé quelque 125 millions en transactions, et 2025 s’annonce encore meilleure ! Ce résultat ne se conjugue nullement avec le “paraître”, car nous privilégions l’être. Si plusieurs sont de passage dans l’immobilier, il s’agit pour ma part d’une véritable vocation, une passion qui est celle d’une vie entière, et que j’ai transmise à Alexandre et Aurélie. Tous deux courtiers résidentiels, ils partagent la même éthique de travail et le même professionnalisme. Je n’envisage donc aucune retraite pour le moment, alors que je me trouve en pleine saison des récoltes à la suite de tout ce que j’ai semé depuis 1984. »
En regardant par-dessus son épaule tout le chemin parcouru, Anne Turcotte aimerait d’abord remercier ses fidèles clients pour leur indéfectible confiance. « Notre profession demande un don de proximité permettant de bien comprendre les gens, d’être empathiques tout en conservant notre équilibre pour mener à bien un processus qui remue souvent beaucoup d’émotions. Nous devenons donc des confidents, presque des psychologues, ce qui explique pourquoi nos clients préfèrent s’ouvrir à une personne de confiance. C’est d’autant plus vrai que beaucoup d’entre eux, fortunés, souhaitent demeurer très discrets, notamment par l’entremise de Private Office, dont je fais partie avec quelque 300 autres courtiers Engel & Völkers dans le monde et qui dessert une clientèle de haut niveau pour des transactions qui demeurent souvent anonymes. C’est sur la confiance que j’ai construit mon réseau, une transaction à la fois, une référence à la fois, en appliquant jour après jour mes valeurs. »

Mme Turcotte tient aussi à remercier tous les professionnels qui partagent le quotidien des courtiers. « Notre réseau est vraiment impressionnant, dit-elle. Inspecteurs, conseillers financiers, avocats, notaires, arpenteurs, experts en bâtiment, spécialistes en environnement et en qualité d’air, promoteurs immobiliers, transporteurs et autres, sans lesquels nous serions incapables d’exercer notre profession. Ils m’ont accompagnée dans tous mes secteurs d’activité, de sorte que je dispose aujourd’hui d’une liste exhaustive de références privilégiées à fournir à mes clients, car l’édifice a été érigé sur le long terme, les liens sont tissés très serré, et la générosité circule dans les deux sens. »
D’une génération à l’autre, cet héritage immobilier s’est transmis tout naturellement. « Je ne les ai jamais considérés comme acquis à ma cause, leur désir de travailler avec moi est venu d’eux-mêmes, après avoir exploré d’autres avenues de carrière, explique Anne Turcotte. Je me sens privilégiée d’être aussi bien entourée et de pouvoir partager avec eux au quotidien toute une carrière en immobilier ! »
Premier à s’être lancé, Alexandre Boutet, diplômé en sciences de la consommation, exerce cette profession depuis 2015 après avoir travaillé pendant des années pour l’une des plus grandes compagnies technologiques au monde. Sa plus grande force est sa persévérance : « Je n’arrête pas tant que nous n’avons pas trouvé la meilleure solution possible », assure-t-il.
Quant à sa sœur Aurélie Boutet, elle agissait comme adjointe exécutive de sa mère depuis près de quinze ans lorsqu’elle a complété sa formation en 2022. Diplômée en psychologie et en administration des affaires, elle se démarque par une implication sans

égale auprès de sa clientèle. Enfin, Antoine Boutet assume depuis 2018 la responsabilité du volet marketing numérique. « C’est incroyable de constater à quel point nos clients disent avoir l’impression de faire partie de notre famille, exprime Aurélie. On a, je pense, outre le savoir-faire, une chaleur humaine intrinsèque qui les met rapidement en confiance. » Comme les trois courtiers vivent chacun dans un secteur différent de la ville, celui-ci est devenu leur territoire de prédilection. Aurélie à Saint-Augustinde-Desmaures et Cap-Rouge, Alexandre dans Montcalm/VieuxQuébec et Anne dans Sillery–Sainte-Foy, sans oublier tous les clients privilégiés qui proposent leur maison de vacances en périphérie. « Je suis tellement fière de constater à quel point Aurélie et Alexandre réussissent aussi bien dans cette profession qui m’est chère, je n’ai aucune inquiétude pour la suite », complète Anne.
Travailler ainsi en famille comporte un avantage certain, car cela maximise l’accessibilité. Chaque membre de l’équipe peut en remplacer un autre au besoin. « Nous sommes tous au courant des détails de chaque dossier », raconte Alexandre. « L’une de nos plus grandes forces, insiste Anne, c’est justement le fait que nos clients peuvent nous rejoindre en tout temps. Je n’ai pas de secrétaire ou d’adjointe pour filtrer mes appels, je préfère répondre directement sur mon cellulaire, sinon je texte pour informer que je vais rappeler rapidement. Voilà ce à quoi notre clientèle a été habituée, et cela vaut pour nous quatre. Nous sommes tous les idéateurs du service que nous offrons, et nous prenons toujours nos décisions en famille pour offrir la plus belle expérience possible. La magie, c’est de s’adapter, se réinventer. Voilà pourquoi j’ai joint Engel & Völkers, car son propriétaire au Québec, Patrice Groleau, incarnait le mieux ce vent de renouveau que je souhaitais depuis plusieurs années dans le monde de l’immobilier à Québec. Une bannière conçue pour un service fourni par la même personne, dans un accompagnement de A jusqu’à Z. J’ai adoré le concept à partir du début. »
Aurélie Boutet, courtier immobilier résidentiel ; et Alexandre Boutet, courtier immobilier résidentiel
Pour en savoir davantage : Engel & Völkers anneturcotte.evquebec.com aurelieboutet.evquebec.com alexandreboutet.evquebec.com

c e bien immobilier d’exception, présentement mis en vente pAr Anne turcotte, courtière Agréée en immobilier de luxe résidentiel et commerciAl chez engel & völkers, AurAit pu fAire l’objet d’un Article de notre historien jeAn-mArie lebel tellement son histoire, qui remonte à 1885, est riche et fAscinAnte.
b ienvenue A u c hâte A u du fA ubourg, un hôtel pArticulier qui comprend 33 mAjestueuses pièces complètement restA urées pA r son propriétA ire Actuel Afin de lui redonner son style frAnçAis du second empire.
D’ABORD,
Au fil d’une promenade au cœur du quartier Saint-JeanBaptiste, impossible de ne pas tomber sous le charme de cette demeure à l’architecture hors du commun. Dessinée par Joseph Ferdinand Peachy pour la famille Dussault, propriétaire de la compagnie Tabac Houde − Dussault et Cie, qui deviendra l'Imperial Tobacco Company of Canada, elle nous rappelle l’histoire de la haute bourgeoisie de Québec inspirée par l’élégance française. À l’instar des hôtels particuliers que l’on trouve encore de nos jours à Paris, une famille riche de Québec se devait, à l’époque, de posséder une grande demeure citadine luxueuse, bâtie pour n'être occupée que par un seul propriétaire et ses domestiques.
Durant plusieurs générations, cette propriété, digne d’un château de l’Hexagone, restera dans le giron familial jusqu’à son rachat, en 1940, par les Sœurs de Jeanne d'Arc. Par la suite, plusieurs propriétaires successifs transformeront le château en logements quelque peu négligés. « Lorsque le propriétaire actuel l’a racheté en 1999, les plafonds avaient été abaissés et cachaient ses magnifiques moulures, raconte Anne Turcotte. Malgré tout, le coup de cœur a été immédiat. Il y a vu une double vocation, résidentielle et commerciale : son pied-à-terre entre deux voyages d’affaires, un bed & breakfast durant ses absences prolongées, mais aussi un endroit incroyable pour accueillir ses clients et organiser des événements. »

Depuis son acquisition, il y a 26 ans, le propriétaire a entrepris une restauration complète et authentique afin de redonner ses lettres de noblesse à ce lieu unique à Québec. « Tous les meubles antiques, tous les objets et les œuvres d’art qui créent cette ambiance feutrée d’hôtel particulier du Second Empire sont ses trouvailles », poursuit la courtière immobilière d’expérience, à qui l’on a confié le mandat de trouver le prochain propriétaire. Signe de l'attrait exceptionnel et rare de ce bien immobilier classé historique, des clients sérieux ont déjà manifesté l’intérêt de l’acquérir dès son inscription sur le marché.



La chambre principale
Vendu avec tout son ameublement, le Château du Faubourg comprend cinq chambres somptueuses avec salle de bain attenante, dont deux suites privées, ainsi que deux petits appartements de fonction. L’un d’eux est d’ailleurs occupé par le concierge (ou le majordome, si vous préférez) qui prend soin de la maison.

La bibliothèque Peachy (du nom de l’architecte) avec son lit escamotable
Qui plus est, l’immeuble comprend deux commerces au rez-de-jardin (un salon de coiffure et une mercerie pour hommes) qui permettent de cumuler des revenus, en plus de ceux générés par le gîte du passant. Sise sur un terrain abritant une cour intérieure paysagée de toute beauté et deux terrasses à l’avant, la maison comprend également trois garages; « un atout qui vaut de l’or dans ce quartier qui détient peu d’espaces de stationnement », ajoute Anne Turcotte. Enfin, bien que son décor nous ramène à une époque lointaine, la résidence est équipée de toutes les commodités modernes, dont la climatisation et le Wi-Fi. « Il s’agit non seulement d’une œuvre d’art architecturale raffinée, digne d’un château en France, mais aussi d’un investissement profitable et paisible situé à quelques pas des grandes attractions de la ville », conclut la spécialiste en immobilier de luxe chez Engel & Völkers.
Le Château du Faubourg situé au 425-441, rue Saint-Jean, en face de l’église Saint-Jean-Baptiste anneturcotte.evquebec.com
CHRONIQUE Électronique
cette Année, le prix des téléviseurs de 100 pouces offrAnt un bon tAux de contrAste, une fréquence de r A fr A îchissement r A pide et des connectiques modernes est pA ssé sous l A b A rre des 8 000 $ chez les grAndes mArques comme sAmsung, lg et sony. ce formAt vient désormAis concurrencer sérieusement les projecteurs, qui étAient jusqu’à mAintenAnt lA solution privilégiée pour obtenir une imAge de 100 pouces et plus.

Alors, face à un tel choix, quelle est la meilleure solution pour un grand écran : un projecteur ou un téléviseur ?
Pour vous aider à prendre la décision la plus éclairée, voici les principaux avantages et inconvénients de chaque technologie.
On pourrait facilement penser que les téléviseurs de 100 pouces offrent une qualité d’image supérieure à celle d’un projecteur standard de prix équivalent. Cependant, grâce aux avancées des dernières générations de projecteurs laser 4K, notamment chez Epson, JVC et Sony, cette affirmation n’est plus tout à fait vraie.
Bien entendu, dans un environnement lumineux, le téléviseur de 100 pouces reste le plus performant : il surpasse
les projecteurs standard en matière de clarté et son image ne souffre pas autant de la lumière ambiante. L’option des projecteurs à courte portée focale, placés à moins de deux pieds de l’écran, offre également une image plus lumineuse qu’un projecteur standard dans une pièce éclairée. Cependant, en ce qui a trait au contraste, ils restent inférieurs aux projecteurs standard ainsi qu’aux téléviseurs de 100 pouces.
Dans une pièce où l’obscurité totale est possible, les projecteurs laser 4K surpassent les téléviseurs de 100 pouces abordables en matière de fidélité des couleurs. De plus, leur image se rapproche davantage de l’expérience visuelle que l’on retrouve dans une véritable salle de cinéma. Pour les amateurs de sport, qu’il s’agisse d’un téléviseur ou d’un projecteur, les fréquences de rafraîchissement sont
désormais suffisamment rapides pour assurer une restitution précise des mouvements rapides.
Une grande image mérite une qualité sonore à la hauteur, ce que les hautparleurs intégrés d’un téléviseur de 100 pouces ou d’un projecteur ne peuvent généralement pas offrir. Avec un téléviseur, plusieurs possibilités s’offrent à vous : un système de cinéma maison traditionnel, comprenant un amplificateur et des enceintes séparées, ou un système de cinéma maison sans fil, avec une barre de son, un caisson de basses et des enceintes arrière connectées en Wi-Fi.
Pour un projecteur, l’utilisation d’une barre de son sans fil est toutefois moins recommandée. En effet, le projecteur étant généralement installé
à une certaine distance de l’écran, cela complique le raccordement du câble HDMI vers une barre de son placée sous l’écran. Dans ce cas, un système de cinéma maison traditionnel est la solution la plus efficace. Il est également conseillé de placer les sources et l’amplificateur à proximité du projecteur afin de minimiser la longueur des câbles HDMI, car une trop grande distance peut parfois causer des problèmes.
On pourrait penser que le coût d’installation d’un projecteur est toujours plus élevé que celui d’un téléviseur, mais ce n’est pas forcément le cas pour un modèle de 100 pouces.
Il est fortement recommandé de confier l’installation d’un téléviseur de 100 pouces à des professionnels. Ces appareils sont lourds, leurs cadres sont très fins et leurs écrans sont sensibles à la pression. Afin d’éviter tout dommage, il faut généralement quatre personnes pour manipuler un tel téléviseur. Cela dit, les téléviseurs de 100 pouces, comme les autres formats, peuvent être installés sur un meuble ou fixés au mur.
Les projecteurs, quant à eux, nécessitent une installation plus planifiée, idéalement avec l’aide d’un installateur spécialisé. Pour obtenir les

meilleures performances, les fabricants recommandent de respecter certaines distances en fonction de la taille d’image souhaitée. Par exemple, pour une image de 120 pouces, le projecteur doit être installé au plafond, à une distance d’environ 13 à 14 pieds de l’écran. L’avantage du projecteur est qu’il peut être utilisé pour différentes tailles d’image, allant de 100 à 150 pouces, voire jusqu’à 300 pouces pour certains modèles. Un téléviseur, lui, est limité à sa taille fixe de 100 pouces. Le coût du projecteur ne varie pas en fonction de la taille de l’image, seul le prix de la toile augmentera si vous optez pour une plus grande taille.
Si vous recherchez la polyvalence en matière de choix d’installation et de système de son, ainsi qu’une solution offrant une belle image même en journée dans une pièce éclairée, le téléviseur de 100 pouces est sans aucun doute le meilleur choix.

En revanche, si vous souhaitez une expérience se rapprochant le plus possible de celle d’une véritable salle de cinéma et que votre installation le permet, rien n’égale un projecteur. La douceur de son image et la fidélité de la reproduction des couleurs offrent une expérience de visionnement unique, différente de celle d’un téléviseur. N’hésitez pas à opter pour une taille d’écran de 120 pouces ou plus, l’immersion sera d’autant plus grande.
Nous espérons que ces conseils vous auront éclairé dans votre choix pour un futur achat de téléviseur ou projecteur. Pour une approche plus personnalisée et une expérience clés en main de l’achat à l’installation, contactez les experts de Maison Adam ou rendez-vous au 710, rue Bouvier afin de planifier vos prochains projets de divertissement avec une équipe de passionnés.
Maison Adam 710, rue Bouvier, Québec 418 628-9000 | maisonadam.ca


Adam
Plus value d'une designer DOSSIER
vous cAressez un projet de construction ou de rénovAtion, et vous vous demAndez si les services d’un(e) designer d’intérieur sont vrAiment nécessAires ? Après tout, vous vous inspirez depuis des mois, voire des Années, des idées qui circulent sur le web et les réseAux sociAux. vous vous sentez donc Apte à gérer vous-même ce volet créAtif. or, AvAnt de vous improviser designer d’intérieur, voici quelques points à considérer, qui vont bien Au-delà de l’Aspect esthétique.
1. LES CONNAISSANCES
« On ne s’improvise pas designer d’intérieur » , précise d’entrée de jeu Nancy Ricard, une professionnelle d’expérience, également copropriétaire de la firme de design et de la boutique Un Fauteuil Pour Deux. Le ou la designer possède, en premier lieu, des connaissances sur les matériaux et les normes de construction, ce qui lui permet de conseiller judicieusement ses clients. À titre d’exemple, les choix ne seront pas les mêmes pour une résidence principale avec des enfants et un chien que pour un condo locatif. Le ou la designer est aussi à l’affût des nouveautés et des tendances, et sait exploiter le plein potentiel de chaque espace en optimisant le rangement. « Je suis là, essentiellement, pour proposer des idées innovatrices auxquelles mes clients n’auraient pas pensé et ainsi créer l’effet wow et une valeur ajoutée à la propriété », résume la spécialiste.


Un autre avantage majeur d’engager un ou une designer d’intérieur est la gestion des soumissions. Premièrement, les plans professionnels dessinés par le ou la designer appartiennent au client, ce qui n’est pas le cas si l’on fait soimême affaire avec un sous-traitant. Donc, une fois les plans réalisés, ils sont envoyés à deux ou trois sous-traitants de confiance, « ce qui permet ensuite de comparer des pommes avec des pommes », explique la designer. Au terme de l’exercice, le client peut vraiment choisir la soumission la plus avantageuse. « À cette étape, très souvent, les honoraires professionnels liés au service d’un ou d’une designer sont récupérés grâce aux économies réalisées sur les travaux » , confirme Nancy Ricard.
Enfin, au-delà du fait que le ou la designer permet à ses clients de faire des choix éclairés et des économies parfois substantielles sur les travaux, son mandat consiste aussi à assurer la surveillance du chantier, à anticiper et à résoudre les problèmes, évitant ainsi des retards et des coûts supplémentaires. « À combien de reprises ai-je dû reprendre des travaux qui avaient mal tourné parce que les clients n’avaient pas fait affaire avec un professionnel au départ », confie la designer. Autrement dit, il vaut mieux payer quelques milliers de dollars en honoraires plutôt que des dizaines de milliers de dollars en erreurs coûteuses. « Faire affaire avec un ou une designer d’intérieur, c’est donc acheter la paix d’esprit » , conclut la professionnelle, qui possède plus de 30 ans d’expérience dans son champ d’expertise.
L’Europe en exclusivité


Plus value d'une designer
fAire AffAire Avec une firme qui offre sous un même toit les services de construction, d'Architecture et de design semble, à première vue, une idée AlléchAnte. mAis concrètement, cette Approche gArAntit-elle le succès du projet ? et permet-elle de gAgner du temps et de l’Argent ?
« C’est la première question à laquelle nous devons répondre, explique Judy-Ann Ross, présidente d’Atelier Avant-Garde. Parfois, le client arrive avec son projet déjà bien avancé et il découvre avec déception qu’il n’est pas conforme à la réglementation municipale, aux contraintes environnementales ou aux exigences liées aux bâtiments patrimoniaux. Dans une approche intégrée, nous demandons le certificat de localisation et nous évaluons tous ces aspects avec l’aide du département d'architecture. Ainsi, nous nous assurons de la faisabilité du projet et, surtout, qu’il démarre du bon pied. »

CETTE APPROCHE FAIT-ELLE GAGNER DU TEMPS ?
« Si le projet a bien été planifié au départ, et qu’il est bien coordonné, étape par étape, la réponse est oui, poursuit Judy-Ann. Travailler en synergie, avec un point de contact unique plutôt que plusieurs interlocuteurs, fait assurément gagner en efficacité. La communication est plus fluide et certaines décisions peuvent être prises plus rapidement. Toutefois, la planification d’un projet et son exécution demandent un certain temps, surtout s’il s’agit d’un projet d’envergure. Il n’est jamais agréable de travailler sous pression, autant pour la firme que pour le client. »
ÉCONOMISE-T-ON SUR LES COÛTS
DU PROJET AVEC UNE SEULE FIRME ?
« Le client qui recherche le prix le plus bas n’y trouvera pas nécessairement son compte, exprime la présidente d’Atelier Avant-Garde. Une approche intégrée permet surtout de recevoir un accompagnement de qualité. Néanmoins, le fait de regrouper l’architecture, le design et la construction sous un même toit permet d’assurer une bonne maîtrise budgétaire du projet et ainsi éviter des coûts imprévus. Les architectes et les designers travaillent de concert avec les estimateurs de la construction. Ils ont une connaissance précise et actualisée des coûts de construction. »
ENFIN, EST-IL POSSIBLE POUR LE CLIENT DE FAIRE SOUMISSIONNER À L’EXTERNE, MÊME DANS UNE APPROCHE INTÉGRÉE ?
« C’est possible, et nous le faisons nous-mêmes auprès de plusieurs sous-traitants de confiance, histoire d’obtenir le meilleur prix, mais nous privilégions pour notre part l’approche intégrée, reconnaît Judy-Ann. Il importe pour le client de savoir qu’en cas de problèmes, seule une approche intégrée garantit une tranquillité d'esprit totale tout au long et après la réalisation du projet, puisque la firme assume l’entière responsabilité du projet. C’est un avantage indéniable pour le client. »

d epuis le début des enjeux commerci A ux Avec les étAts-unis, lA petite feuille d’érAble vAut plus que j A m A is son pes A nt d’or. e lle est le symbole d’une n Ation qui s’Affirme fAce à l A concurrence de nos voisins du sud. le secteur de l’hAbitAtion, confiAnt dAns lA quAlité de ses produits et sûr de son sAvoirfAire, se positionne Avec force sur le mArché « mAde in cAnAdA ». deux entreprises de lA région de québec nous expliquent en quoi elles se démArquent à cet égArd.


MA CUISINISTE : ENCOURAGER
Copropriétaire de l’entreprise Ma Cuisiniste, Jessie Fréchette confirme que les clients sont de plus en plus soucieux de l’origine des produits qu’ils achètent et souhaitent encourager les entreprises d’ici. « Et cette tendance s’est accentuée avec les enjeux économiques et environnementaux des dernières années, ajoute-t-elle. Les clients comprennent qu’en choisissant Ma Cuisiniste, ils investissent non seulement dans un projet de qualité, mais aussi dans des emplois et un savoir-faire local qui font rayonner le Québec à travers le Canada. Le fait de travailler avec des fournisseurs et des fabricants québécois nous permet également d’assurer une constance dans la qualité et les délais de livraison; un avantage majeur dans un contexte mondial encore instable. »
Récipiendaire d’un Prix Nobilis 2025 de l’APCHQ dans la catégorie « Cuisine neuve ou rénovée de plus de 75 000 $ » , Ma Cuisiniste a également choisi de s’associer à un partenaire québécois pour la fabrication de ses armoires. Située à Saint-Anaclet, au Bas-Saint-Laurent, l’usine de Miralis est reconnue, depuis plus de 45 ans, pour son savoirfaire, son innovation et son respect de l’environnement. Le tandem Ma Cuisiniste−Miralis permet ainsi d’offrir design sur mesure, qualité et durabilité. « En privilégiant des matériaux laminés fabriqués ici et une production régionale, nous réduisons considérablement notre empreinte écologique et favorisons la consommation responsable, conclut Jessie. Sans mentionner le fait que cette approche assure un meilleur contrôle de la qualité, des délais de production fiables et un service après-vente personnalisé, le tout en soutenant activement l’économie locale. »

ARMOIRES AD+ :
L'EXPERTISE FABRIQUÉE AU CANADA
La tendance au local se confirme aussi chez Armoires AD+, entreprise québécoise fondée en 1993 et aujourd’hui bien établie, avec trois succursales modernisées : Québec, Lévis et Sainte-Marie. « Les clients veulent savoir si leurs matériaux sont réellement fabriqués au Canada, et c’est une question qu’on nous pose de plus en plus souvent, affirme Sylvie Baillargeon, designer-cuisiniste sénior. Chez AD+, nous identifions clairement les produits 100 % canadiens et nous privilégions des fournisseurs d’ici pour le quartz, le granit, la mélamine, le bois et l’aluminium.
Le Québec et le Canada possèdent des ressources naturelles exceptionnelles, alors pourquoi aller ailleurs ? »

Autre force majeure : Armoires AD+ possède sa propre usine manufacturière, dotée d’équipements technologiques de pointe, ainsi qu’un département complet de finition et de teinture, à moins de 20 minutes des ponts. Cette intégration a valu à l’entreprise le prix « Manufacturier innovant » aux Fidéides en 2024, et le prix « Performant PME » aux Pléiades 2025, soulignant l’avant-garde de son modèle. Résultat : une rapidité et un respect remarquables des délais d’exécution, ainsi qu'une constance exemplaire dans la qualité. « Et lorsque les matériaux proviennent d’ici plutôt que d’outremer, la stabilité et les délais sont encore meilleurs », ajoute la professionnelle.
Enfin, AD+ innove avec un concept unique au Canada : l’Espace 24 h. Cette salle de montre intelligente, accessible jour et nuit sur rendez-vous, permet de générer une première esquisse de votre projet d'armoires en toute autonomie. Une preuve supplémentaire que l’ingéniosité québécoise repousse encore les frontières de l’expérience client.



u n vent de renouve A u souffle sur l A fl A mme de l’entreprise montigo, fondée en 1976 dAns l’ouest cAnAdien. forgé pAr près de 50 Années d’expérience, le fAbricAnt de foyers Au gAz se tAille une plAce de choix sur le mArché grâce à ses conceptions sur mesure et ses innovAtions en mAtière d’efficAcité énergétique. à ces deux forces s’Ajoute un Autre
AvAntAge : lA cApAcité d’émettre une certificAtion cs A de ses produits, l’ A ccent étA nt mis sur l A recherche et le développement.
L’ART DE MARQUER L’IMAGINAIRE
De retour d’une visite à l’usine de Montigo en ColombieBritannique, Célina Fontaine, copropriétaire de l’entreprise
Les Cheminées Gamelin, reconnaît avoir été impressionnée par le savoir-faire et l’avant-gardisme de ce fabricant. Sur place, elle a pu admirer un modèle hors norme qui s’étirait sur neuf pieds de hauteur et une dizaine de pieds de largeur, équipé d’une bûche gigantesque et capable de libérer 175 000 BTU de puissance. « Peu de fabricants font ce genre de foyers sur mesure » , confirme Célina, qui a d’ailleurs appris que Montigo a conçu un foyer entièrement personnalisé pour la superstar Beyoncé. Au-delà des styles variés (contemporain, traditionnel, panoramique), l’entreprise se distingue aussi par ses options de brûleurs et de bûches. Des modèles marquent l’imaginaire, comme le foyer en forme de L inversé qui génère une flamme verticale, ou encore cet autre modèle dont le brûleur crée un spectaculaire tourbillon de flammes semblable à une tornade.
Bien que le design soit primordial, Montigo se démarque surtout grâce à l’efficacité énergétique supérieure de ses foyers. « De plus en plus de gens souhaitent que leur foyer au gaz agisse un peu comme un chauffage central, explique la spécialiste. Même si le foyer demeure un chauffage d’appoint, celui de ce fabricant offre une innovation clé en matière de gestion de la chaleur. » Cette technologie intelligente (Cool Wall Advantage) distribue et redirige efficacement la chaleur, offrant un confort maximal et permettant d’installer sans risque un téléviseur au-dessus du foyer.

Autre atout majeur de ce fabricant : il possède les installations et l’expertise reconnues par les organismes de certification pour homologuer lui-même ses produits. « C’est plutôt rare dans l’industrie, nous informe Célina. Cette attestation certifie que les foyers Montigo respectent des normes très strictes en matière de sécurité, de fiabilité et de performance. »
Enfin, pour pousser l’expérience à un autre niveau, Montigo s’est tournée vers la réalité virtuelle. « Les gens peuvent désormais visualiser à quoi ressemblera leur foyer dans leur demeure et leur décor selon le modèle et les options qu’ils ont choisis », conclut la copropriétaire des Cheminées Gamelin. Magasiner son foyer n’aura jamais été aussi simple et agréable !



DOSSIER
Essai Routier

GENESIS GV70 ÉLECTRIFIÉ 2026
à première vue, difficile de croire que ce gv 70 est électrique. genesis A choisi de conserver l’Allure de l A version à essence plutôt que de tomber dAns le spectAcul Aire. derrière ce style volontAirement discret se cAche une motorisAtion à zéro émission pourtAnt très performAnte. cette discrétion soulève toutefois une question : A pporte-t-elle un plus à l’expérience derrière le volAnt ou risque-t-elle de le l Aisser dAns l’Angle mort d’un mArché très sensible Au pArAître ?
À bord, le GV70 électrifié assume pleinement ses ambitions haut de gamme. Des bandeaux lumineux intégrés aux portières créent une ambiance agréable. La qualité de l’assemblage mérite d’être soulignée, tout comme le choix des matériaux, bien assortis et mis en place avec soin. Deux livrées sont offertes : Advanced et Prestige. La première propose déjà un équipement généreux. La seconde pousse plus loin la présentation avec, notamment, des sièges garnis de cuir nappa, un ciel de toit en microfibre de suède et un système audio Bang & Olufsen.
La recherche d’une position de conduite naturelle ne pose aucun défi. Le conducteur peut compter sur de multiples ajustements électriques du siège et du volant. La visibilité de côté vers l’arrière demeure toutefois perfectible en raison de la lunette basse et des montants arrière imposants. On se fie alors davantage aux systèmes d’aide à la conduite pour compenser ce point faible. À l’avant comme à l’arrière, l’espace disponible correspond à ce que l’on attend d’un VUS compact de luxe. Les passagers profitent d’un dégagement convenable et l’ambiance générale reste accueillante.


Désormais dominée par un grand écran OLED de 27 po, la planche de bord regroupe les données de conduite et le système d’infodivertissement. L’affichage est précis, les cartes de navigation se lisent facilement et la logique des menus facilite la prise en main. L’ergonomie se montre convaincante, à condition d’accepter une courte période d’adaptation. L’écran, un peu éloigné, n’est pas idéal pour manipuler les commandes tactiles, et la proximité de la molette d’infodivertissement avec le sélecteur de vitesses rotatif peut créer une certaine confusion au début. Genesis a toutefois eu l’heureuse idée de conserver un bloc de commandes distinct pour le chauffage et la climatisation.
La nouveauté la plus importante concerne la batterie, dont la capacité passe de 77,4 à 84 kWh. Selon Ressources naturelles Canada, l’autonomie officielle grimpe ainsi de 380 à 402 km. Le gain n’est pas exceptionnel, mais il place le véhicule dans une fourchette comparable à celle de plusieurs concurrents européens et japonais. Il doit néanmoins souffrir la comparaison avec la Tesla Model Y Longue autonomie, dont la portée atteint 526 km. Selon les données du constructeur, sa technologie de 800 volts lui permet de passer de 10 à 80 % en environ 19 minutes sur une borne de 350 kW. Sur une borne rapide plus courante de 50 kW, il faut plutôt compter un peu plus d’une heure pour atteindre le même résultat. Le modèle 2026 est désormais équipé d’un port NACS, donnant ainsi accès au réseau de bornes Tesla compatibles, et livré avec un adaptateur CCS pour l’utilisation des autres infrastructures de recharge rapide.
Le GV70 électrifié dispose de deux moteurs électriques qui, conjointement, développent 429 chevaux. En appuyant sur le bouton Boost monté sur le volant, la puissance grimpe à 483 chevaux durant quelques secondes pour offrir une poussée maximale lors d’une forte accélération ou d’un dépassement. En situation normale, la motorisation tire profit d’un couple de 516 lb-pi, suffisant pour assurer des accélérations vigoureuses et des reprises convaincantes, de quoi le placer parmi les VUS électriques les plus performants de sa catégorie. Ironie du sort, c’est la variante la plus discrète qui est aussi la plus explosive : en accélérations comme en reprises, l’électrique prend le dessus sur le GV70 à essence.
Sur le plan technique, le GV70 électrique profite pour 2026 de réglages de châssis et de suspension retravaillés. Ces rehaussements ne le transforment pas pour autant en Porsche Macan électrique, mais lui permettent de s’imposer comme un VUS électrique procurant une douceur de roulement impressionnante. La direction, légère mais précise, et la suspension, bien calibrée pour absorber les irrégularités, contribuent à une impression de grande sérénité. L’insonorisation, particulièrement réussie, renforce ce sentiment. Chaussé de roues de 20 pouces dans la version Prestige, il reste bien campé sur la chaussée. Comme il se doit dans ce créneau, il embarque un ensemble complet d’aides électroniques à la conduite, en plus du rouage intégral qui gère efficacement la puissance disponible.

Le message lancé par Genesis est clair comme de l’eau de roche : son GV70 à motorisation électrique met l’accent sur le luxe discret plutôt que sur un style tapageur. Conduite paisible, présentation sérieuse, silence de fonctionnement et intégration réussie de la technologie composent un ensemble cohérent et crédible dans le segment des utilitaires électriques de luxe. L’expérience d’achat comprend aussi cinq ans d’entretien sans frais et un service de voiturier, ce qui nuance son prix d’achat élevé.
Prix de départ : 78 500 $
Prix du véhicule essayé : 89 000 $ (couleur : 500 $)
Autonomie : 402 km
Concurrence principale : Audi Q4 e-tron, Audi Q6 e-tron, BMW iX (selon la version), Cadillac Lyriq, Genesis GV60, Lexus RZ, MercedesBenz EQE (VUS), Porsche Macan électrique (selon la version), Tesla Model Y.
Pour en savoir davantage :
Genesis de Québec 515, rue Clemenceau, Québec 418 666-9000 genesisdequebec.ca
DOSSIER
Essai Routier

LEXUS RZ 450 E 2026
loin des démonstrAtions tApe-à-l'Œil, le rz propose une silhouette soignée et une interprét A tion mesurée du vus électrique hAut de gAmme. premier modèle 100 % électrique de lexus vendu Au pAys, il pArtAge son Architecture de bAse Avec les toyotA bz4X et subAru solterrA, tout en s’en distinguAnt p A r une c A rrosserie propre et une exécution intérieure fidèle à lA signAture lexus. critiqué pAr le pAssé pour son rAyon d’Action limité, le millésime 2026 corrige le tir en AllongeAnt l A portée et en simplifiAnt lA rechArge, ce qui le repositionne plus AvAntAgeusement dAns son créneAu.
À l’intérieur, Lexus mise sur le confort. Les sièges avant soutiennent correctement, la position de conduite est naturelle, avec une assise légèrement haute qui procure une bonne visibilité. Les commandes principales tombent sous la main, même si certaines touches montées sur le volant demandent un temps d’adaptation. Une fois lancée, l’interface centrale de 14 po est claire et réactive. Point fort : la climatisation conserve des commandes visibles en tout temps à l’écran. La finition est soigneusement exécutée : ajustements précis, matériaux sérieux. Mais elle ne crée
pas le « coup de cœur » ressenti dans les intérieurs les plus raffinés, comme celui du Genesis GV70. À l’arrière, deux adultes voyagent à l’aise, même si l’assise un peu basse limite le soutien des cuisses et que la place centrale sert surtout d’appoint. Le coffre convient au quotidien et aux escapades, sans viser le record de la catégorie. Détail intéressant sur la version « Executive » : le toit panoramique se teinte pour calmer l’éblouissement sans utiliser de rideau mécanique.

Pour 2026, le RZ gagne du terrain en matière d’efficacité énergétique. C’est la meilleure nouvelle que Lexus pouvait annoncer. Équipé de roues de 20 po, le modèle 450 e 2025 pouvait parcourir 315 km selon les données officielles. Le remplacement de la batterie de 71,4 kWh par une nouvelle de quelque 77 kWh a cependant changé la donne : cette fois, la configuration équivalente peut en parcourir 415, soit 100 km de plus. Dans le cas du 450 e muni de roues de 18 po, la portée a augmenté d’une soixantaine de kilomètres, atteignant désormais 418 km. Les plus longs trajets demandent ainsi moins de planification. Et, comme au Québec, l’électrique se mesure à l’hiver, les gains réalisés ne peuvent être que salutaires.
Autre mise à jour positive : la recharge a été revue. Sur une borne rapide, la batterie passe, selon Lexus, de 10 à 80 % en environ 30 minutes dans des conditions idéales. Le RZ 2026 adopte aussi la prise NACS, donnant accès aux bornes Tesla compatibles et ouverte aux autres marques. Et le chargeur embarqué passe à 11 kW sur une borne de niveau 2, ce qui accélère les recharges à domicile ou au travail.
Ces évolutions s’accompagnent d’un repositionnement tarifaire : les prix du modèle 450 e ont augmenté d’environ 2 600 $ à 7 000 $ selon la version. Cette année, la marque ajoute le RZ350 e, un modèle à traction affichant une latitude de déplacement de 478 km et un prix autour de 63 000 $, qui était celui du RZ450 e de base en 2025. Elle accueille également le RZ550 e F SPORT, une livrée plus sportive qui offre une centaine de chevaux de plus que le RZ450 e, au prix d’une autonomie inférieure (369 km).
Prix de départ : 70 065 $
Prix du véhicule essayé : 87 388 $ (Executive)
Autres modèles offerts : 350 e et 550 e AWD
Autonomie : 415 km (avec roues de 20 po)
Concurrence principale : Audi Q4 e-tron, Genesis GV60 et GV70, Mercedes-Benz EQE (VUS), Volvo EC40 et EX40
Note : Essai réalisé au volant du modèle 450e 2025 ; l’analyse tient compte des mises à jour 2026 sur l’autonomie et la recharge, les autres aspects demeurant sensiblement inchangés.
Le RZ donne l’impression d’un véhicule bien élevé, qui adoucit les imperfections de la chaussée et garde son aplomb. Les accélérations sont franches au départ, ce qui rend les entrées sur l’autoroute faciles, sans toutefois tomber dans l’excès. Le châssis inspire la confiance et le comportement demeure prévisible. En manœuvre d’évitement ou en freinage d’urgence, on sent que les pneus et la calibration privilégient la sécurité et le confort plutôt que la sportivité pure. Résultat : une expérience cohérente avec l’image de Lexus, mais moins engageante que ce que proposent certains VUS électriques de la catégorie. Le RZ450 e est équipé de série du rouage intégral. Pour l’année 2026, ce système nommé DIRECT4 bénéficie d’améliorations qui le rendent, selon la firme, plus efficace lors du démarrage et de l’accélération en ligne droite, ainsi que dans les virages.
Pris dans son ensemble, le RZ 2026 est fidèle à la promesse Lexus : un utilitaire serein, facile à vivre, rassurant. Il plaira à l’acheteur qui priorise la quiétude, le service après-vente et une expérience de conduite coulée. Les gains en matière d’autonomie et de vitesse de recharge le placent dans une bien meilleure posture qu’auparavant face à la concurrence.

Pour en savoir davantage :
Boulevard Lexus 122, rue du Marais, Québec 418 681-2121 boulevardlexus.com


110
RESTAURANT 1668
114
DOSSIERDÉJEUNERS ET DÎNERS D'AFFAIRES

ouvrir un restAurAnt en 2021, en plein cŒur de lA pAndémie, demAndAit du courAge, de lA déterminAtion et une bonne dose de confiAnce ! c’est pourtAnt ce qu’ont Accompli Ariël cArdinAl-petit et sA femme rAchel quirion, Ainsi que leurs collègues kevin grondin et pier-olivier thompson. tous issus de lA restAurAtion, ces Amis pAssionnés, inspirés pAr les sAveurs locAles qui n’ont rien à prouver, ont enrichi sAint-georges, en beAuce, d’une gAstronomie si riche et délectAble qu’elle se sAvoure les yeux fermés. le restAurAnt 1668 est une perle de hAute cuisine Au milieu d’une offre plutôt stAndArdisée. fAire l A route jusqu’à cette destinAtion culinAire promet déjà plAisir gustAtif et véritAble enchAntement.

Dès le départ, ils ont envisagé de travailler avec des produits québécois, uniquement québécois. Ariël et son équipe souhaitaient faire de la gastronomie locale un art de haute voltige pouvant rivaliser avec les grandes tables d’illustres restaurants d’ici et de l’étranger. « On rêve que le Québec ait sa propre identité culinaire, on est fiers de notre nation ! », partage Ariël, enthousiaste.
Ils n’ont donc pas forcément cherché à remplacer les ingrédients importés, bien que le safran parfume à l’occasion les plats… mais il s’agit d’un safran du Québec ! Par exemple, ils ne cuisinent pas avec le citron, ni ne cherchent à le substituer. Ils privilégient plutôt d’autres produits, non pas comme simples palliatifs, mais comme substances uniques qui méritent d’être découvertes et savourées. La benoîte urbaine, une petite fleur jaune au goût de clou de girofle et de sauce barbecue, ainsi que les herbes boréales font notamment partie de ces condiments hors du commun qui subliment les plats à merveille.
La majorité des aliments proviennent de régions se trouvant à l’intérieur d’un rayon maximal de 250 km du restaurant. Ce choix, s’il exprime la noble intention de valoriser le terroir et les producteurs de chez nous, est aussi motivé par la qualité et la fraîcheur. « L’asperge à 20 minutes est plus belle qu’à 7 h de route ! », énonce Ariël avec évidence. Les contraintes locales sont cependant présentes, mais s’y adapter permet à l’équipe d’utiliser une rare palette aromatique et de gâter ainsi ses convives. La saisonnalité, l’une de ces contraintes, devient au Restaurant 1668 non plus un obstacle, mais un levier pour ajouter encore davantage de nuances à la carte et de plaisir en bouche.


Au Restaurant 1668, la saison dicte par conséquent le menu. La plupart des fruits et légumes sont croqués en saison, alors que leur goût culmine. Pas le choix : la carte évolue toutes les six à huit semaines en raison de la disponibilité des produits locaux. « On mange ce que la nature offre au moment opportun. On se bourre la face quand c’est le temps ! Mais on ne veut bousculer aucune habitude commune. On veut plutôt rendre nos démarches et notre philosophie positives, faire en sorte que notre restaurant en soit un de pur plaisir et de délices », explique Ariël.
Cette approche permet de créer des plats qui exhalent la fraîcheur et font éclater les saveurs. À ce rythme de création, les plats signatures se font volontiers oublier. Chaque recette est en réalité une découverte à la fois pour les cuisiniers et les invités à table, et n’apparaît jamais deux fois au menu !

Néanmoins, pour prolonger l’expérience gustative audelà des périodes de récolte — car il faut bien manger des légumes en dehors de l’automne ! —, l’équipe recourt à des techniques ancestrales de conservation, comme le cannage ou la fermentation. Quant aux légumes de garde (carottes, patates, choux, oignons, etc.), ils sont soigneusement entreposés en cellier à température contrôlée. Ces bonnes vieilles méthodes préservent les saveurs naturelles des aliments, en accord avec le principe de saisonnalité et de fraîcheur du moment. Cette préparation minutieuse exige du temps et un grand soin, mais elle est au cœur de la vision gastronomique des propriétaires.
Cette rigueur dans le choix et la préparation des produits incite naturellement à l’inventivité. Lorsqu’il faut composer avec les saisons et la disponibilité des ingrédients, ceuxci deviennent une source d’idées surprenantes, parfois farfelues, toujours suaves. L’association des goûts est réinventée ; une sauce tomate se transforme en une sauce aux fraises pourtant relevée avec les mêmes condiments !
Ce processus créatif s’opère en outre face à la variabilité des stocks. Chaque menu constitue alors un réel exercice d’ingéniosité. De là naissent des combinaisons inattendues et des harmonies renversantes.
Cette créativité débordante ne se limite toutefois pas aux saveurs. Elle guide également la manière dont les plats sont présentés aux gourmets : à l’aveugle ! En menu dégustation 4 ou 7 services, les repas sont au choix de la cuisine. « On fait des exercices d’équilibre de saveurs. Ce qu’on prépare, c’est ce qu’on offre avec assurance » , confie Ariël.
Les portions sont légèrement plus généreuses qu’une entrée. Les clients peuvent de la sorte expérimenter une multitude de saveurs et se laisser tenter. La petite carte servant d’appoint propose également cette formule appréciée.
La carte des vins est élaborée en parfaite cohérence avec la volonté des associés de mettre en lumière les producteurs d’ici : elle est 100 % québécoise ! Les plus de 80 produits qu’elle réunit — blancs, orangés, rosés, mousseux et vins fortifiés — ont aussi été sélectionnées pour leur qualité (aucun vin d’entrée de gamme n’est servi) et pour leur rareté. « Par exemple, nous sommes les seuls au Québec à proposer le cabernet franc de l’Orpailleur. Si on n’encourage pas les producteurs d’aujourd’hui, on n’en aura pas demain. C’est un investissement pour le futur », souligne Ariël.
De 80 à 90 % des vins servis au Restaurant 1668 ne figurent pas sur les tablettes de la SAQ. C’est pourquoi la presque totalité des clients accompagnent leur repas d’un vin qu’ils n’auraient jamais découvert autrement !


Le Restaurant 1668 n’est pas seulement un endroit où se sustenter : c’est une destination en soi. « Si jadis le souper n’était qu’une introduction à la soirée, il en devient aujourd’hui le point culminant. Ça met la barre haute ! Mais nous croyons avoir réussi à faire de notre établissement un attrait en lui-même. La clientèle de Saint-Georges est fidèle et très heureuse que nous ayons donné à la ville une autre option. Quant aux clients de passage, ils ont désormais accès à une table remarquable qui peut même changer leur voyage ! Puis, il y a les clients de destination, ceux de l’extérieur, qui viennent exprès pour goûter nos mets. Nous en voulons toujours plus, nous sommes accueillants ! Et, de toute façon, il y a toujours une bonne raison d’aller en Beauce ! », expose Ariël, prêt à ouvrir la porte à tous.
Installé dans un local exigu et semi-équipé entre 2021 et 2023, le Restaurant 1668 a ensuite emménagé dans des installations plus vastes, à même l’édifice de l’École d’Entrepreneurship de Beauce, qui l’a aussi intégré comme traiteur de prédilection.
En toutes circonstances, l’expérience culinaire vécue dépasse le simple repas. C’est une célébration des saveurs locales, un laboratoire de créativité et un lieu phare de la cuisine québécoise. Faire le détour à Saint-Georges pour y manger justifie pleinement les kilomètres parcourus sur les routes pittoresques de la Beauce.
Pour en savoir davantage :
Restaurant 1668
18235, boulevard Lacroix, Saint-Georges info@restaurant1668.com | 418 228-1668
restaurant 668.ca
DOSSIER / MARIE-JOSÉE TURCOTTE
Déjeuners et dîners d'affaires
p our nouer une nouvelle rel A tion d’ A ffA ires, remercier un client fidèle, signer une entente m A jeure ou simplement célébrer un pA rten A ri At, le choix du lieu est primordi A l. v oici
l A destin Ation pA r excellence pour un déjeuner ou un lunch d’ A ff A ires qui lAisserA un souvenir impérissAble à vos invités : fAirmont le châteAu frontenAc.
Son cadre historique, son élégance intemporelle et sa vue inspirante sur le majestueux fleuve
Saint-Laurent… Difficile de résister au charme de ce lieu emblématique, qui offre le décor parfait pour transformer un simple repas en succès d’affaires. Au-delà de sa réputation de classe mondiale, Fairmont Le Château
Frontenac a néanmoins su conserver son ambiance à la fois chic et décontractée, si bien que vos invités s’y sentiront immédiatement à l’aise et irrévocablement privilégiés.
PLACE DUFFERIN : POUR UN DÉLICIEUX
Dès 7 h, et ce, tous les jours de la semaine, le restaurant Place Dufferin est le lieu tout désigné pour déguster le premier repas de la journée avec, en toile de fond, le fleuve et la terrasse Dufferin. Le menu de type buffet est si varié qu’il s’apparente à un brunch, mais il est aussi possible de commander à la carte. Pour des discussions nécessitant plus de discrétion, certaines sections dans la magnifique verrière offrent des coins propices aux échanges privés.
BISTRO LE SAM : POUR UN LUNCH MÉMORABLE
Après le déjeuner à Place Dufferin, le Bistro Le Sam prend la relève pour le dîner dès 11 h 30 tous les jours de la semaine. Ce bistro évolutif, qui met en vedette les meilleurs ingrédients locaux du Québec, vous garantit un repas d’affaires savoureux dans un cadre élégant qui n’a pourtant rien de guindé. Le menu propose d’ailleurs des formules à partager conviviales. Enfin, pour garantir la confidentialité de vos discussions, vous pouvez demander des places plus en retrait. Les banquettes en velours, avec leur haut dossier, créent un effet de « cocon » qui assure un cadre plus intime et privé pour conclure vos affaires en toute tranquillité.

« Se rendre au Château est compliqué » : FAUX !
Grâce au service de voiturier offert, vos invités et vous bénéficiez d'un accès facile et rapide à l’établissement.
Et pourquoi pas un « Afternoon Tea » ?
Vous souhaitez sortir des sentiers battus et offrir une expérience distinctive à vos invités ? Optez pour l’heure du thé à Place Dufferin. Nul doute que ce rituel authentique, offert dès 14 h (du jeudi au samedi), marquera les esprits de vos (futurs) clients ou partenaires d’affaires.

DOSSIER
Déjeuners et dîners d'affaires
pour un rendez-vous d’AffAires réussi, quoi de mieux qu’un endroit où on se sent bien, où le service est efficAce et où lA nourriture fAit le bonheur de tous ? voilà ce que propose Au petit chAlet sous un même toit. que ce soit pour un déjeuner d’équipe ou un dîner entre collègues, c’est l’Adresse idéAle pour jAser AffAires dAns une AmbiAnce chAleureuse et conviviAle.
Dès l’entrée, le décor unique rappelle une cabane à sucre moderne. Bois rond, lumière douce et odeur de café frais : le ton est donné. Confortable et sans prétention, parfait pour créer une atmosphère détendue propice aux discussions de travail ou aux rencontres entre partenaires.
Ce qui distingue vraiment Au Petit Chalet, c’est son offre de déjeuners servis en tout temps. Même l’après-midi, vous pouvez savourer vos classiques préférés ! Et si vous avez envie d’un plat qui sort de l’ordinaire, l’assiette « Flamboyant » vaut le détour : pain doré Madagascar garni de fraises fraîches, accompagné d’un œuf bénédictine au jambon à l’érable. Un mélange sucré-salé qui fait l’unanimité !
À la recherche d’un bon repas rapide ? Le déjeuner express est tout indiqué : deux œufs brouillés, succulent bacon du Chalet et pommes de terre signature. Le déjeuner le moins cher et le plus rapide en ville !
Impossible de parler de l’établissement sans mentionner ses fameuses patates maison. Coupées à la main chaque matin et assaisonnées d’un mélange secret d’épices, elles sont devenues une signature de la maison, servies à volonté afin d’éviter le gaspillage.

Pour les rendez-vous d’affaires du midi, les amateurs de dîners plus traditionnels ne seront pas en reste. Le restaurant se distingue par ses burgers gourmets, savamment composés et préparés avec des ingrédients de qualité, alliant fraîcheur, goût et générosité. Chacun d’eux reflète le savoir-faire de la maison et l’attention portée aux détails qui font toute la différence. Par ailleurs, les spécialités — comme la salade César au poulet croustillant, la lasagne ou encore le poulet parmigiana — confirment la réputation d’une cuisine réconfortante, préparée avec soin et servie dans une ambiance à la fois conviviale et raffinée.
Au Petit Chalet, le service est attentionné, rapide et souriant, parfait pour les horaires chargés. Peu importe la raison de votre visite, l’équipe vous mettra à l’aise. Bref, pour vos déjeuners et dîners d’affaires, ne cherchez pas plus loin ! Entre son décor chaleureux, ses plats réconfortants et son ambiance authentique, Au Petit Chalet combine parfaitement le plaisir de bien manger et l’efficacité d’un lieu pensé pour les professionnels. On y vient une fois… et on y retourne souvent !

DOSSIER
Déjeuners et dîners d'affaires
é tA blissement emblém Atique du pAys Age hôtelier de québec, l’hôtel le bonne entente s’impose comme une Adresse privilégiée pour les dirigeAnts, cAdres supérieurs et pArtenAires d’AffAires en quête d’un lieu où déjeuners et dîners se déroulent dAns un cAdre élégAnt, discret et Authentique.

Site iconique, cet hôtel contemporain met plus de soixantedix ans de savoir-recevoir au service de sa clientèle d’affaires. Ici, le prestige n’est jamais ostentatoire : il rassure. Dès l’arrivée, le ton est donné : accueil personnalisé, équipes professionnelles et attentionnées, le tout porté par l’énergie chaleureuse d’une entreprise familiale. On s’y sent rapidement en confiance, qu’il s’agisse de recevoir un client stratégique, un partenaire international ou un conseil d’administration.
Pour un déjeuner d’affaires à Québec ou un rendez-vous à l’heure du midi, le MC Lounge et le Monte Cristo, plus intime, ponctué d’alcôves, forment le cœur névralgique et gourmand des rencontres corporatives. Leur carte évolutive met en valeur des produits soigneusement sélectionnés, en collaboration avec des artisans et fournisseurs québécois. Petits-déjeuners corporatifs, déjeuners stratégiques ou dîners d’influence : chaque proposition culinaire est pensée pour soutenir l’échange, sans voler la vedette aux enjeux discutés. Service et rythme adaptés aux agendas chargés, confort acoustique, présentation impeccable : tout est calibré pour favoriser les décisions.
Pour les entreprises à la recherche de salles de réunion à Québec, l’hôtel Le Bonne Entente propose une offre modulable à la hauteur des attentes : salons privés pour comités exécutifs, espaces polyvalents pour lancements, conférences de presse ou sessions de planification, équipements technologiques performants et accompagnement événementiel aguerri. Réunions, présentations et dîners d’affaires s’enchaînent sous un même toit, avec la possibilité de prolonger le tout par un séjour haut de gamme, notamment par un passage à l’Amerispa. Aux beaux jours, jardins et terrasse offrent une continuité naturelle aux échanges, dans ce resort urbain unique à Québec.
Pour les organisations en mode productif : le service de boîtes à lunch « bento box » et de menus d’affaires sur mesure est également disponible. Idéales pour les retraites de travail, les formations intensives ou des rencontres en continu, ces propositions gastronomiques permettent de maximiser chaque minute tout en conservant le raffinement de la maison. Fraîches, élégantes, faciles à servir en salle de réunion ou dans un espace privé, elles reflètent le même niveau d’exigence que la table du MC Lounge.
Finalement, si l’hôtel Le Bonne Entente reste l’une des adresses les plus prisées pour les déjeuners et dîners d’affaires à Québec, c’est parce qu’il conjugue ce que recherchent les décideurs : le prestige d’une institution, la chaleur d’une hospitalité sincère et une expérience complète, pensée pour les affaires.




DOSSIER / CENDRINE
Déjeuners et dîners d'affaires
un subtil équilibre entre Art de recevoir et effic A cité professionnelle : ici, les rencontres se déroulent d Ans un c A dre de villégiAture exclusif, sublimé pAr une g A stronomie r A ffinée, des esp A ces de réunion pA rfA itement A mén A gés et une équipe A ttentionnée qui personn A lise chAque détAil.
Dans les Cantons-de-l’Est, peu d’adresses réunissent autant d’atouts pour un dîner d’affaires réussi que le Ripplecove. Inauguré en 1945 au bord du lac Massawippi, ce lieu emblématique a su conserver les charmes de villégiature tout en se dotant d’installations résolument modernes. On y vient pour travailler autrement, dans un décor qui favorise les échanges, et pour offrir à ses invités une expérience inoubliable.
Le premier avantage du Ripplecove demeure son cadre enchanteur : vue directe sur le lac, lumière naturelle, ambiance feutrée et sentiment d’intimité. C’est exactement ce qu’apprécient les professionnels en quête d’un environnement inspirant. Pour un dîner d’affaires plus formel, on choisira Le Riverain, une table raffinée au foyer chaleureux où chaque détail a été pensé pour favoriser la convivialité et mettre les invités à l’aise. Avec sa vue imprenable, le Bistro Le Cove accueille de son côté les 5 à 7 plus décontractés ou les cocktails de fin de journée. Il devient ainsi le lieu tout désigné pour resserrer les liens d’équipe.

L’une des grandes forces de l’établissement réside dans sa capacité à transformer chaque rencontre en expérience sur mesure. Menus personnalisés selon le déroulement de la journée, collations santé, boîtes à lunch raffinées aux saveurs du terroir et cocktails signatures : l’équipe culinaire s’adapte avec finesse au rythme et aux besoins de chaque entreprise. Pour enrichir l’expérience, il est aussi possible d’organiser une dégustation de vins en cellier ou un atelier chocolaté exclusif animé par la chocolatière. Autant d’attentions qui laissent une impression durable et signent l’art de recevoir du Ripplecove.
Grâce à ses infrastructures modernes, le Ripplecove met à disposition 5 300 pi2 d’espaces de réunion, répartis en six salles modulables et un espace foyer idéal pour les regroupements. Équipées d’une technologie de pointe, ces installations se prêtent parfaitement aux présentations, formations ou retraites de direction. Parce qu’un environnement de travail inspirant passe aussi par la détente, l’hôtel propose une gamme d’activités à la carte — fat bike électrique, expériences bien-être ou activités sur mesure orchestrées par son service de conciergerie. Le tout forme le parfait équilibre entre performance et ressourcement, pour des équipes pleinement épanouies.
Incontestablement, le Ripplecove s’affirme comme une destination d’affaires raffinée et complète : lieu inspirant, gastronomie élégante, activités mémorables et service d’une grande souplesse. En un mot comme en cent, il s’avère l’adresse idéale pour recevoir avec panache… tout en demeurant efficace.



DOSSIER
Déjeuners et dîners d'affaires
Ancien cAfé-théâtre devenu restAurAnt de quArtier Au chArme indémodAble, le hobbit offre Aux gens d’AffAires un cAdre chAleureux, un brin Artistique, où l’on peut discuter sérieusement… sAns se prendre trop A u sérieux. u n lieu p A rfA it pour mél A nger business, Authenticité et bonne tAble.
Né en 1976 au cœur du faubourg Saint-Jean, le Hobbit a d’abord été un café-théâtre prisé des artistes de Québec. Robert Lepage, Guylaine Tremblay, de nombreux musiciens et comédiens, et parfois même Jean Leloup, y ont laissé leur empreinte. Ce lieu mythique doit son charme à cette histoire unique, tout en conservant un atout précieux : on y vient pour se sentir bien, échanger et créer.
C’est ce qui fait du Hobbit une adresse particulièrement prisée pour les rencontres d’affaires. Ici, tout est simple et authentique : dès qu’on franchit la porte, l’accueil est chaleureux, le service professionnel et l’atmosphère naturellement décontractée. La « cravate imaginaire » tombe immédiatement, laissant place à des échanges sur les chiffres, les projets ou la culture d’entreprise… tout en restant profondément humains. Dans un monde professionnel où tout va vite, cette authenticité est un véritable atout.
Le restaurant est ouvert 7 jours sur 7, matin, midi et soir, avec un brunch proposé tous les jours — un atout considérable dans la ville de Québec, où il n’est pas toujours facile de trouver des horaires aussi flexibles. C’est un avantage précieux pour la clientèle d’affaires : on peut y programmer un rendez-vous tôt le matin avant le bureau, un lunch à horaire souple ou un souper plus intime avec un invité externe. La cuisine, à la fois accessible et savoureuse, séduit autant les résidents du quartier que les professionnels : on y déguste de bons plats à prix raisonnable, avec ce petit côté réconfortant qui met chacun à l’aise et facilite les échanges.

L’histoire du Hobbit continue de s’écrire sous la direction des nouveaux propriétaires depuis cinq ans : le chef Rémi Harvey, sa conjointe Danie Ouellette, et Jocelyne Veillette, dite Jojo, pilier et mémoire du lieu depuis une vingtaine d’années. Ils ont ajouté un espace pouvant accueillir une trentaine de personnes, privatisable pour des événements. Un atout pour les petites entreprises du centre-ville, les agences ou les firmes en croissance souhaitant rassembler leur équipe hors du bureau, dans un décor chargé d’histoire. Un service traiteur sur mesure est également proposé, toujours dans cette volonté de proximité et de convivialité.
Mais ce qui distingue vraiment le Hobbit, c’est son supplément d’âme. Le nom emprunté à l’œuvre de Tolkien, l’origine de l’établissement comme café-théâtre, l’esprit de quartier, ces vieilles pierres qui ont tout entendu… tout cela crée un climat où les échanges sont plus riches, plus vrais. On y vient pour faire avancer un dossier, oui, mais on en ressort en ayant aussi consolidé une relation. Pour des rencontres d’affaires alliant authenticité et convivialité, c’est ici que l’énergie se crée et que les échanges prennent vie.




DOSSIER / PAMÉLA
Déjeuners et dîners d'affaires
derrière lA fAçAde discrète du cercle de lA gArnison de québec se cAche un environnement exclusif propice Aux réunions d’AffAires. cet Ancien club militAire propose un cAdre feutré où élégAnce, intimité et g A stronomie s’unissent pour créer un endroit pArfAitement AdApté Aux échAnges confidentiels.
Le Cercle abrite quatorze salons portant le nom d’un régiment en l’honneur de l’héritage des lieux. Loin de l’austérité que l’on pourrait craindre en raison de ses origines militaires, chaque salon dégage une ambiance unique et raffinée permettant d’accommoder les membres et leurs invités. « La diversité des salles offre une flexibilité très appréciée auprès de la clientèle, mentionne Maude Chayer, coordinatrice aux réservations et événements. Qu’il s’agisse d’un repas en petit comité ou d’une assemblée de soixante personnes, nous pouvons adapter les lieux. » Les portes closes assurent la confidentialité des discussions, tandis que le service attentionné de l’équipe garantit un déroulement fluide pendant l’événement.
Pour les équipes en quête de réflexion stratégique ou de cohésion, le forfait lac-à-l’épaule offre une solution clés en main sans l’isolement des retraites traditionnelles en région éloignée. Ainsi, une journée complète au Cercle de la Garnison comprend la collation matinale, le repas du midi, la pause gourmande en après-midi et l’apéro avec des bouchées imaginées par le chef. Habituellement, deux salons sont réservés pour ce genre d’événement : l’un pour les sessions de travail intensives, l’autre pour les moments de détente et d’échanges informels. Chaque forfait est par ailleurs modulable selon les besoins de la clientèle, la disposition de la salle en passant par les menus personnalisés, ou encore le respect d’un horaire serré pour recevoir un conférencier. « Nos clients aiment ce format puisqu’ils n’ont rien à organiser, précise Mme Chayer. Tout est pris en main et adapté dans les moindres détails. » Cette souplesse fait partie de l’ADN du Cercle, où chaque rencontre se déroule à l’image de l’entreprise qui l’organise.

Quant à l’offre alimentaire, elle reflète la créativité de la jeune brigade. On y trouve une cuisine actuelle, soignée et accessible, avec une attention particulière aux restrictions alimentaires. Une formule sur mesure s'impose naturellement pour les grands groupes. C’est toutefois le menu à la carte, renouvelé chaque semaine, qui fait la signature du lieu. Par ailleurs, une fois par mois, un repas thématique est concocté pour faire voyager les convives tout en conservant un ancrage sur les produits locaux. Tour à tour, les gens ont pu déguster des saveurs marocaines, italiennes ou autochtones. « Notre chef aime sortir de sa zone de confort, mais c’est toujours une œuvre collective, souligne Maude Chayer. Chaque plat porte la signature du Cercle, pas d’un seul individu. »
Le Cercle de la Garnison est un lieu où se mêlent tradition et distinction. Porté par une petite équipe agile et dévouée, il offre à sa clientèle d’affaires un environnement où chaque détail est pensé pour favoriser les échanges. Plus qu’un espace de réunion, c’est un cadre d’exception où l’on travaille, partage et s’inspire en toute élégance et confidentialité.

DOSSIER / CENDRINE CHÉNEL
Déjeuners et dîners d'affaires
d eux A dresses bien situées, un service fluide, des menus midi Accessibles et une constAnce depuis près d’un quArt de siècle, kimono sushi bAr s’impose comme une vAleur sûre pour les entreprises de lA région de québec.

25 ans
En 2025, Kimono Sushi Bar célèbre un jalon majeur : ses 25 ans. Dans le monde de la restauration, c’est un gage de constance et d’expertise; dans le monde des affaires, un signe de fiabilité et de confiance.
Kimono Sushi Bar fait partie de ces adresses que la clientèle d’affaires adopte instantanément. Pourquoi ? Parce qu’on y retrouve trois ingrédients désormais incontournables dans le monde professionnel : accessibilité, efficacité et constance dans la qualité. Le tout s’exprime dans une atmosphère élégante, inspirée de l’Asie contemporaine, où chaque détail contribue à une expérience à la fois raffinée et décontractée.
Depuis plus de 20 ans, Kimono Sushi Bar s’impose comme une adresse de choix pour les rendez-vous d’affaires. Avec ses deux établissements, l’enseigne offre une grande flexibilité pour planifier un lunch, un dîner de travail ou opter pour la livraison de boîtes-repas raffinées. À Sainte-Foy, le stationnement gratuit et souterrain ajoute une touche de praticité, idéale pour des rencontres à la fois efficaces et agréables.
Atout indéniable pour les entreprises, Kimono Sushi Bar se démarque par son offre du midi abordable, alliant qualité et efficacité, avec la possibilité de commander à l’avance. Les boîtes pour emporter s’adaptent parfaitement aux réunions en salle de conférence, aux rencontres hybrides ou aux équipes en télétravail de passage au bureau. Pour les occasions spéciales ou les repas d’équipe, un service traiteur avec livraison vient compléter cette offre pratique et savoureuse.
La succursale de Charlesbourg offre une salle privée pouvant accueillir jusqu’à 30 personnes, idéale pour une présentation, un repas de fin de trimestre ou un comité d’équipe, dans une atmosphère à la fois zen et contemporaine. À Sainte-Foy, le décor transporte en Asie grâce aux lanternes chinoises, aux teintes chaleureuses et aux néons colorés.
La carte du Kimono Sushi Bar séduit par sa richesse et son raffinement : sushis classiques, créations originales du chef et plats chauds savamment préparés. Chaque assiette témoigne d’un savoir-faire précis et d’un souci du détail qui plaira autant aux amateurs de cuisine japonaise qu’à ceux en quête d’une expérience gastronomique raffinée. Une adresse qu’on recommande sans hésiter à un client.


DOSSIER / CENDRINE CHÉNEL
Déjeuners et dîners d'affaires
un décor chAleureux, une cuisine exotique créAtive et un service d’une gr A nde souplesse, pour que les entreprises puissent recevoir Autrement. o n pArle strAtégie en dégustAnt un tAtAki, on signe un contrAt Autour d’un curry pArfumé… et l’on repArt Avec l’impression d’Avoir vécu une expérience.
Dirigé par la cheffe-propriétaire Thi Cam, femme passionnée et inspirante, le bistro propose une cuisine d’inspiration asiatique qui puise avec finesse dans plusieurs traditions : Japon, Vietnam, Corée, Thaïlande… en intégrant çà et là des accents occidentaux ou méditerranéens. Résultat : un menu créatif, coloré, qui devient rapidement un sujet de conversation pour entamer une réunion et conclure des ententes.
Situé dans le quartier Lebourgneuf, Thi Cam Bistro se donne comme vocation d’être à l’écoute de sa clientèle d’affaires. Un seul objectif : adapter, créer une expérience à l’image de l’entreprise, à ce qu’elle souhaite et veut partager avec ses clients pour trouver le bon rythme entre efficacité et plaisir de la table. On peut ajuster les portions ou le dosage des épices et prévoir des options végétariennes ou sans allergènes. La cheffe souhaite avant toute chose le succès de son client et fait en sorte que le moment soit toujours agréable.
Avec une capacité d’environ cent places, Thi Cam Bistro peut accueillir de grands groupes pour un dîner d’affaires. La force de l’établissement : la rapidité du service, qui permet de respecter l’horaire de travail, même à l’heure du midi. Pour les rencontres plus confidentielles, une salle privée d’une vingtaine de personnes est disponible, équipée du matériel nécessaire aux réunions. On peut donc y faire une présentation, une projection… puis passer directement au repas.
Du menu midi, en salle, pour les professionnels, au 5 à 7 pour célébrer une signature, en passant par les boîtes à lunch livrées au bureau, sans oublier l’option traiteur pour une rencontre de CA : le service s’adapte aux réalités de chaque entreprise. L’équipe chevronnée livre un service impeccable et sur mesure. Le Thi Cam Bistro peut donc être ajouté à votre carnet d’adresses pour vos prochaines rencontres professionnelles, car rares sont les établissements où l’on peut parler business… tout en partageant le plaisir d’un menu exotique et personnalisé.


DOSSIER / LAURENCE BRIÈRE
Déjeuners et dîners d'affaires
orgAniser un dîner d’AffAires réussi, c’est trouver l’équilibre pArfAit entre efficAcité, confort et rAffinement. voilà ce que propose steAk Avenue, un étAblissement prisé des professionnels souhAitAnt conjuguer
AffAires et gAstronomie.
Avec son menu midi soigneusement conçu pour les rendez-vous d’A ffA ires, le restA ur A nt offre l’expérience idé A le pour éch A nger, négocier et conclure A utour d’un repAs à lA fois rApide et sophistiqué.
Situé stratégiquement sur le boulevard des Galeries, au cœur d’un immeuble de bureaux, Steak Avenue permet d’éviter tout déplacement inutile. L’endroit conjugue ambiance feutrée, service attentionné et décor élégant, des atouts propices aux discussions confidentielles et aux ententes importantes.

Chez Steak Avenue, l’importance accordée aux ingrédients de qualité se ressent dans chaque assiette. Seules des coupes de qualité supérieure sont sélectionnées, et soigneusement vieillies dans une chambre de vieillissement sur place pour atteindre une tendreté et un goût exceptionnels. Que vous optiez pour nos steaks grillés à la perfection, nos carpaccios finement tranchés, nos tartares ou même notre steak haché, chaque bouchée témoigne du respect du produit et du savoir-faire des chefs.
Lors de vos dîners, le menu midi propose une sélection équilibrée de plats alliant qualité, fraîcheur et saveur. On y retrouve un choix d’entrées incluses dans le prix du repas : potage du jour, salade verte du chef ou légère salade de chou. Impressionnez vos convives en leur offrant l’une de nos incontournables entrées signées Steak Avenue, telles que le carpaccio de bœuf Wagyu, nos sashimis d’exception ou encore notre cocktail de crevettes d’Argentine.
En plat principal, le vaste choix vous épatera, que vous ayez envie d’un classique filet mignon, d’un plat plus raffiné, tel que notre unique poisson du marché ou encore de notre Poutine Surf & Turf Thermidor. Et laissez-vous séduire par notre carte de cocktails Signatures.
Adapté à l’agenda des professionnels, le service du midi est à la fois rapide et personnalisé, au cœur d’une atmosphère élégante et d’un décor chic et chaleureux où il fait bon discuter et bien manger.
Pour prolonger le plaisir après vos rencontres d’affaires, profitez de l’occasion pour vous procurer sur place nos steaks de qualité supérieure à la boucherie Steak Avenue. De quoi impressionner à la maison vos invités !
Steak Avenue demeure donc une destination incontournable pour vos rencontres professionnelles, en plus d’être un lieu d’exception que tous apprécieront.



134
CHRONIQUE SANTÉ
136
SIGNATURE OLFACTIVE
138
DOSSIERCHIRURGIE ESTHÉTIQUE ET LIFTING SANS CHIRURGIE
depuis longtemps, le l Aser Au dioxyde de cArbone (co 2) occupe une pl Ace de choix en esthétique dAns les interventions non invAsives pour rAjeunir lA peAu et corriger les imperfections cutAnées. rAppelons son fonctionnement : le lAser émet une lumière infrArouge qui est Absorbée pAr l'eAu contenue dAns les tissus, provoquAnt une vAporisAtion contrôlée des couches superficielles de lA peAu. celA fAvorise le renouvellement cellulAire et lA stimulAtion du collAgène. ses ApplicAtions sont principAlement le rAjeunissement cutAné, le trAitement des cicAtrices et des lésions bénignes, l A correction des tAches pigmentA ires et l’ A mélior Ation du relâchement cutA né. l es nouve Aux lAsers co2 sont Appelés frActionnés, cAr ils ne trAitent qu’une frAction de lA surfAce de lA peAu. les AvAntAges de cette technologie : polyvAlence, précision élevée, résultAts rApidement visibles et temps de récupérAtion Accéléré.
DES INTERVENTIONS
PERSONNALISÉES
Chez Eye Am Soins oculaire et médicoesthétiques, nos techniciennes qualifiées personnalisent les traitements selon la nature des problèmes, l’étendue de la zone à traiter et le temps dont les personnes disposent. Quelqu’un qui souhaite redonner de l’éclat à son visage à l’occasion d’un événement spécial — Noël approche ! — peut venir nous voir une semaine avant, et la récupération ne prendra que quelques jours. Cela dit, pour des ridules plus profondes, par exemple en péribuccal ou pour des pattes d’oies, on peut opter pour un seul traitement plus intense si le temps de récupération n’est pas un enjeu. En revanche, si on souhaite retourner rapidement au travail ou à ses activités, l’approche sera différente, et un nombre plus élevé de séances espacées de quelques semaines pourra être suggéré. En effet, l’intensité variable de l’appareil nous permet de nous adapter à toutes les situations et les attentes. De façon générale, plus l’imperfection à traiter est importante, plus le temps de récupération s’allongera. Une chose est sûre, nous prenons le temps de bien analyser chaque cas et de recommander la meilleure marche à suivre en prenant soin de personnaliser le traitement pour une satisfaction accrue. Une crème anesthésiante sera appliquée au préalable pour les séances plus intenses afin d’augmenter le confort.

Étant donné que le laser crée des microcanaux à la surface de la peau, il est intéressant d’en profiter pour compléter le traitement par l’application d’exosomes. En effet, ces ouvertures favorisent la pénétration de ces minuscules vésicules extracellulaires, qui agissent comme des messagers entre les cellules. Celles-ci transportent des protéines, des lipides et des acides nucléiques pour communiquer des informations importantes, favorisant des processus comme la régénération cellulaire, la production de collagène et la réparation des tissus, améliorant la texture de la peau et réduisant le temps de récupération. Les exosomes aident aussi à réguler la production de mélanine pour traiter les taches pigmentaires. Ceux que nous utilisons sont extraits de la rose et sont spécifiquement conçus pour un usage cutané. Évidemment, les précautions concernant l’exposition au soleil sont
de mise, avant et après une séance, des recommandations qui sont toujours communiquées à notre clinique. En effet, il est courant d’avoir des rougeurs, un léger gonflement ou une légère desquamation de l’épiderme, des symptômes qui s’estompent en quelques jours.
Bref, le laser au CO2 est un outil précieux. Son efficacité, sa précision et sa polyvalence en font un choix privilégié pour quiconque souhaite améliorer son apparence de façon durable et sécuritaire.

dre mAude lebel
MDCM, MU
Omnipraticienne Eye Am Soins oculaires et médico-esthétiques


l e concept de « sign Ature olf A ctive » g A gne en populArité, à l’heure où les pArfums font tourner les têtes et les cŒurs plus intensément que jAmAis. mAis qu’est-ce qu’une signAture olfActive ?
C’est un vecteur invisible de communication et de déclenchement d’émotions. Une personne, comme un lieu, peut se parer d’une signature olfactive qui laisse une trace durable dans les esprits en stimulant le cerveau limbique, siège de la mémoire et de l’émotion. Autrement dit, il ne s’agit pas d’une simple odeur agréable ; c’est la traduction olfactive d’une identité ou d’une projection, et un message transmis aux autres.
SIGNATURE OLFACTIVE PERSONNELLE :
RÉVÉLATION OU PROJECTION
Il existe de nombreuses raisons pour qu’un individu désire sa propre signature olfactive, et elles se multiplient de décennie en décennie !
Une signature olfactive peut donc annoncer des intentions variées et surprenantes. Elle peut être authentique et refléter ainsi la personnalité de quelqu’un le plus fidèlement possible. Par exemple, une personne discrète, mais chaleureuse, pourrait choisir des notes boisées et enveloppantes, associées à un tendre accord floral.
Elle peut être également aspiratoire et projeter une image idéalisée. Un timide au cœur doux pourrait se tourner vers un parfum audacieux, incarnant la confiance en soi, composé à partir d’agrumes pétillants, d’épices vibrantes et de fleurs opulentes.
Enfin, elle peut être compensatoire et moduler certains traits de caractère. Une personne au tempérament nerveux pourrait privilégier des notes vanillées, poudrées ou ambrées, favorisant le calme et laissant présager une assurance tranquille.
SIGNATURE OLFACTIVE DES LIEUX : OUTIL MARKETING ET EXPÉRIENTIEL
La magie de l’olfaction ne se limite pas aux individus. Les espaces aussi — boutique, hôtel et autres — peuvent tirer profit de l’effet envoûtant des odeurs. La signature olfactive d’un lieu plonge ses visiteurs dans un univers subtil qu’ils associeront à leur passage.
Si leur immersion est positive (c’est, évidemment, ce qui est souhaité), ils seront enclins à revenir faire escale à cette adresse. L’odeur définira l’endroit et le distinguera de tous les autres. L’odeur deviendra synonyme d’expérience et de souvenir. La signature olfactive d’un lieu est sans conteste un outil marketing et expérientiel puissant, conçu pour fidéliser la clientèle et, plus encore, la charmer astucieusement.
Pour donner vie à une signature olfactive réussie, le parfumeur, en plus de puiser dans son orgue à parfums, doit conjuguer méthode et techniques, intuition, connaissances, mémoire olfactive, prodigieuse patience… et essais-erreurs en quantité parfois impressionnante !

Plusieurs boutiques exclusives et de grandes marques telles que Apple, Aritzia, Birks, Boss, Lululemon, Marc Cain, Maska, Sephora et Simons.
DOSSIER / MAUDE
Chirurgie esthétique et lifting sans chirurgie
l es temps évoluent, et notre mAnière de prendre soin de lA peAu Aussi. Aujourd’hui, lA beAuté ne se mesure plus à lA perfection, mAis à l’hArmonie et à lA confiAnce que l’on dégAge. de plus en plus de gens recherchent des solutions douces, voire nAturelles, pour rAffermir et redéfinir le visAge sAns recourir Au bistouri. c ’est d A ns cet esprit qu’émerge une technologie novAtrice : le lifting s A ns chirurgie emfA ce , une méthode non invA sive qui promet un effet de fermeté et de tonus visible, sAns Aiguilles ni douleur.
UNE SYNERGIE ENTRE PEAU
EMFACE se distingue par sa capacité à agir simultanément sur deux composantes essentielles : la peau et les muscles. En combinant la radiofréquence, qui stimule la production de collagène et d’élastine, et la technologie HIFES (HighIntensity Facial Electrical Stimulation), qui tonifie les muscles faciaux en profondeur, cette synergie redonne au visage sa fermeté et ses contours d’origine. Les résultats sont naturels et progressifs : rides atténuées, peau plus ferme, joues redessinées, regard plus ouvert. Contrairement aux interventions chirurgicales ou aux injections, EMFACE ne fige pas les traits et ne modifie pas les expressions — il révèle plutôt la beauté authentique de chacun.
Ce soin s’adresse autant aux femmes qu’aux hommes, qu’il soit utilisé à titre préventif, pour maintenir la tonicité de l’épiderme, ou curatif, pour corriger les signes perceptibles du relâchement cutané. Son grand avantage : aucune période de récupération n’est nécessaire. En seulement une trentaine de minutes, on retrouve un teint visiblement plus frais et une peau éclatante.

Derrière cette technologie de pointe se trouve une philosophie claire : prodiguer des traitements respectueux du corps et du bien-être, sans compromis sur les résultats. Le lifting sans chirurgie s’inscrit dans une approche globale où douceur et innovation accompagnent naturellement le passage du temps en remplaçant les techniques plus invasives.
Comme l’explique la propriétaire de la Clinique Ekinoxe, Émilie Beaulieu, ce progrès représente l’aboutissement d’une quête d’excellence : « Depuis des années, mon rêve était d’offrir une possibilité sans intervention chirurgicale, sans injection et sans inconfort. EMFACE incarne cette vision d’une beauté authentique, efficace et soutenue par la science. »
Le message est clair : prendre soin de sa peau n’a jamais été aussi simple, sécuritaire et harmonieux. EMFACE ne se résume pas à une prouesse technologique, c’est une nouvelle façon de redonner aux tissus cutanés la fermeté, l’éclat et la vitalité qu’ils méritent — pour traverser le temps avec confiance et légèreté.


CHRONIQUE
Éducation
comme je l’Ai mentionné dAns lA précédente chronique, mon but est de renforcer lA collAborAtion entre l’école et les fAmilles en vous permettAnt de mieux comprendre lA réAlité quotidienne de lA vie scolAire. dAns ce texte, je vous propose un Aperçu du milieu dAns lequel votre enfAnt évolue chAque jour, Ainsi que quelques précisions sur les moyens de communiquer Avec l’enseignAnt. à l’Approche du temps des fêtes, il me semble égAlement opportun d’Aborder lA question des Absences en clAsse liées Aux voyAges fAmiliAux.
LA COMPOSITION
D’UNE CLASSE AUJOURD’HUI
Voici un aperçu réaliste de la composition d’une classe dans plusieurs milieux scolaires. Dans certains secteurs du Québec, la situation peut même être encore plus complexe.
D’abord, il faut savoir que le gouvernement fixe un nombre maximal d’élèves par classe, selon le niveau scolaire, le type de classe (régulière ou en adaptation scolaire) et la cote de défavorisation du milieu. Le nombre varie entre 20 et 26 élèves.
EXEMPLE :
UNE CLASSE DE 24 ÉLÈVES.
Voici, à titre d’exemple, à quoi peut ressembler la composition d’une classe ordinaire de 24 élèves au secteur public.
/ 7 élèves ayant un plan d’intervention pour des besoins particuliers :
1 élève présentant un trouble du spectre de l’autisme (TSA) ;
4 élèves avec de grandes difficultés d’apprentissage (DA), dont 2 qui n’ont pas acquis les notions de 2e année et qui se retrouvent en situation d’échec ;
1 élève avec un trouble déficitaire de l’attention avec hyperactivité (TDAH) et un trouble d’opposition (TO) ;
1 élève souffrant d’un trouble anxieux sévère.
/ 4 élèves à profil moyen-faible, sans plan d’intervention, mais à surveiller de près, car ils sont à risque d’échec.

/ 6 élèves dans la moyenne, sans besoins particuliers.
/ 2 élèves à profil moyen/fort.
/ 3 élèves forts, toujours à jour dans leurs travaux, qu’il faut stimuler davantage pour maintenir leur motivation.
/ 1 élève à haut potentiel (douance), qui connaît déjà toute la matière actuelle et à venir, s’ennuie profondément et ne veut plus venir à l’école.
/ 1 élève nouvellement arrivé au Québec, ne parlant pas français, bénéficiant de seulement quelques heures de francisation par semaine. Le reste du temps, l’enseignante doit lui préparer des activités de niveau de première année pour l’aider à acquérir les bases de la lecture.
En résumé, dans cette classe de 24 élèves, 16 présentent des besoins particuliers, soit plus des deux tiers du groupe. Seuls 8 élèves fonctionnent de manière réellement autonome, sans soutien ni plan d’intervention. Malheureusement, qu’il s’agisse d’un élève en difficulté ou d’un élève qui s’ennuie, les besoins sont tout aussi importants.
Bien que les services aux élèves soient moins présents, étant donné les coupes budgétaires, je vous assure que les enseignants sont pleinement conscients de la réalité et qu’ils mettent tout en œuvre pour répondre aux besoins de leurs élèves afin que chacun se sente encadré et soutenu. Tous ont profondément à cœur le bien-être de leurs élèves, même si cela représente chaque jour un véritable tour de force.
COMMUNIQUER
AVEC L’ENSEIGNANT
Les imprévus et les rendez-vous
Il arrive fréquemment que des parents envoient un courriel pour signaler un rendez-vous médical ou familial, puis se présentent à l’école pour chercher leur enfant sans avoir reçu de confirmation.
Résultat : l’enfant n’est pas prêt, l’enseignant n’a pas vu le message et peut être pris par surprise. Cela peut causer des retards ou des oublis, par exemple, comme de remettre un devoir ou un document important avant le départ. Pour éviter ces situations, un appel à la secrétaire demeure la méthode la plus fiable. Selon la nature du message que vous souhaitez faire parvenir, il est important de savoir quoi faire pour vous assurer que l’enseignant reçoive bien le message.
Les courriels et les délais de réponse
Certains parents qui ont des questions durant la période des devoirs et des leçons écrivent à l’enseignant et s’attendent à une réponse rapide, et ce, même durant la soirée. Or, il faut savoir que tous les enseignants ne consultent pas nécessairement leurs courriels en dehors des heures de travail.
/ Certains le font de façon volontaire et répondent en soirée ou tôt le matin.
/ D’autres préfèrent attendre leur arrivée à l’école pour le faire.
L’enseignant n’est pas tenu de répondre à ses courriels en dehors de ses heures de travail.
Les absences non motivées
J’aimerais aborder un sujet bien présent dans nos écoles : l’absence des élèves en raison d’un voyage.
Tout d’abord, je crois qu’aucun enseignant ne s’opposera à ce qu’un enfant parte en voyage avec ses parents. En revanche, aucun d’eux ne peut accorder d’autorisation pour motiver l’absence d’un élève. De votre côté, il est important de réfléchir à l’impact que ces journées d’absence peuvent avoir sur le parcours scolaire de votre enfant. En effet, il faut savoir que si des évaluations sont prévues durant cette période, l’enseignant n’est pas tenu de les lui faire reprendre. Dans le cas d’un élève en difficulté, il est fortement déconseillé de lui faire manquer des journées de classe, car chaque heure d’enseignement compte. Plus l’enfant est exposé aux notions et a l’occasion de les pratiquer, mieux il consolide ses apprentissages.
Les absences ont également un impact significatif sur la charge de travail de l’enseignant, surtout lorsqu’elles s’étendent sur plusieurs jours. Si l’enfant est très autonome et qu’il peut rattraper rapidement les notions manquées, la situation demeure généralement simple — à condition que le parent ne demande pas de matériel à l’avance. En effet, bien que certains enseignants planifient leurs leçons à long terme, la majorité le fait d’une semaine à l’autre. Lorsqu’un parent demande les travaux avant
le départ, cela oblige l’enseignant à planifier son enseignement plus tôt que prévu, à préparer et adapter du matériel supplémentaire, et souvent à répéter ces démarches pour plusieurs familles. Ce travail supplémentaire, combiné aux exigences quotidiennes déjà élevées, alourdit considérablement la tâche de l’enseignant.
Mon but n’est pas de vous dissuader de partir, mais bien de vous assurer d’avoir toutes les informations nécessaires qui vous permettront de faire un choix éclairé sur les dates avant de réserver un voyage. Il est donc souhaitable de communiquer avec l’enseignant pour en discuter. Cela vous permettra au moins d'être au fait des apprentissages prévus et des conséquences que pourrait occasionner son absence.
L’objectif est d’assurer un équilibre entre les expériences familiales et la continuité scolaire. Avec une bonne communication et un peu de prévoyance, tout le monde y gagne, l’enfant, le parent et l’enseignant.

s ur l A côte de p ortneuf, l’église de cA p- sA nté A une belle et longue histoire qui remonte jusqu’Aux lointAins jours de l A nouvelle-frAnce. il fAut l A visiter dAns le temps des fêtes. on y célèbre encore lA messe de minuit à l’Ancienne. sA crèche de noël A émerveillé des générAtions de pAroissiens.
De nouveau, cette année, dans beaucoup de nos foyers, des parents et leurs enfants, décorant le sapin, ouvriront des boîtes contenant les boules et mille et un ornements, rappelant tant de souvenirs des Noëls passés.
Bien des maisonnées ont gardé la coutume de placer une crèche au pied de l’arbre. Souvent, elle est constituée de petites statuettes. Depuis quelques années, nos crèches sont souvent entourées d’un village de petites maisons.
Et, de nouveau, le 24 décembre dans nos églises, des gens s’affaireront à fouiller dans les armoires des sacristies pour trouver tout ce qu’il faut pour monter la crèche, car tout doit être prêt pour les messes de Noël.
On se rappelle les paroles du touchant monologue Noël au camp de Tex Lecor. Éloigné de ses parents, regardant ses cartes de Noël, regrettant de ne pouvoir assister à la messe de minuit, le jeune homme s’exclamait : « Ah, c’est une grande chose pareil, un p’tit enfant vient au monde, pis toute la Terre le sait. » De tous les personnages historiques, c’est la naissance de Jésus de Nazareth qui fut la plus célébrée à travers les siècles.
Les livres les plus savants sur Noël nous expliquent que ce fut saint François d’Assise, dont on soulignera le 800e anniversaire de décès en 2026, qui eut l’idée en 1224 de réaliser une crèche pour éduquer et émouvoir devant ce « grand mystère de la Nativité d’un Sauveur »
Ce fut au cours du XVIe siècle que se répandit la tradition des crèches de Noël dans les églises et cathédrales d’Europe.
Chez nous, dans nos modestes églises de la NouvelleFrance, on pouvait admirer les petits Jésus de cire. Ceux que réalisaient les habiles Augustines de l’Hôtel-Dieu de Québec devinrent célèbres.
L’âge d’or de nos crèches d’église débuta dans les dernières décennies du XIXe siècle quand notre province de Québec eut ses fabricants de statues moulées en plâtre reproduites en grande quantité. Les gens qui ont fréquenté plusieurs de nos églises ont eu l’occasion de remarquer que les personnages de nos crèches ont de grands airs de parenté d’une église à l’autre. Mais cela n’enlève rien à leur charme.
Lorsque l’on visite des expositions de crèches, on se rend compte que, dans la chrétienté, chaque contrée a donné à ses crèches ses couleurs, ses traits, ses particularités.

La crèche de Noël de l’église de Cap-Santé en 2024
Qu’est-ce qui distingue nos crèches québécoises ? Ailleurs, l’Enfant Jésus est né dans une grotte. Ici, il a vu le jour dans une étable. C’est ce que nous disaient nos vieux cantiques de Noël Dans cette étable, Dans une étable obscure, D’où viens-tu bergère ? C’est pourquoi les personnages sont souvent placés sous une structure de bois évoquant une étable. De plus, n’y trouvons-nous pas un bœuf et un âne gris ? Et ils sont ici bien nécessaires, leurs souffles réchauffent l’Enfant Jésus, car, en notre pays, il vient au monde lors d’une nuit bien froide. Aux bergers accourus, l’ange avait annoncé, selon l’évangéliste saint Luc : « Vous trouverez un nouveau-né emmailloté et couché dans une mangeoire. »
Traditionnellement, c’était pour la messe du matin des Rois, le 6 janvier, que le sacristain ajoutait les Rois mages. C’est l’évangéliste saint Mathieu qui nous parle de l’adoration des mages venus d’Orient et de leurs présents à l’Enfant Jésus : de l’or, de l’encens et de la myrrhe. Au Moyen Âge, on en fit des Rois mages et on les baptisa Gaspard, Balthazar et Melchior. Peut-être nous pardonneront-ils d’avoir souvent confondu leurs dromadaires avec des chameaux ? Et une bonne vieille crèche de chez nous n’est pas complète sans son ange quêteur. À chaque pièce de monnaie que l’on glisse dans son gousset, il nous remercie d’un gracieux hochement de tête…
145 ART DE VIVRE

146 CLUB MED PUNTA CANA 148 NOUVELLE-ÉCOSSE
dAns un monde pressé qui mesure encore trop souvent lA réussite d’un voyAge Au nombre de pAys visités, le slow trAvel s’impose comme lA nouvelle tendAnce écoresponsAble et engAgée. voyAger lentement, ce n’est pAs renoncer à l’Aventure : c’est lui redonner son sens.
Savourer un café sans Wi-Fi dans une ruelle de Lisbonne, marcher plutôt que courir vers le prochain musée, s’attarder à la table d’hôte d’un riad marocain pour écouter l’histoire du propriétaire, voilà la quintessence de ce mouvement né d’un besoin de sens, de respect et d’équilibre. Le slow travel, c’est l’art de se poser, de comprendre avant de photographier, de s’imprégner plutôt que de cocher.
Cette approche exige une certaine discipline : celle de la patience et du respect du rythme local. Elle invite à privilégier la qualité de l’expérience à la quantité des escales. Louer un appartement pour une semaine plutôt qu’un hôtel différent chaque soir, choisir un train pour admirer les paysages plutôt qu’un vol intérieur, ou encore passer une journée entière dans un marché local pour en saisir la vie, les saveurs, les codes.
C’est aussi une étiquette intérieure : être présent, courtois, attentif. Un sourire sincère, un mot appris dans la langue du pays, un remerciement adressé à un artisan, autant de gestes simples qui traduisent une politesse universelle. Le slow travel n’est pas qu’une manière de voyager : c’est une manière d’être.
Dans une ère saturée d’images et de notifications, le slow travel réintroduit une rareté précieuse : celle du silence, de l’émerveillement et de la gratitude.
Alors, et si le vrai luxe résidait dans le temps que l’on s’accorde à ne rien faire d’autre que vivre pleinement, ici ou ailleurs ?

CLUB MED PUNTA CANA 2026
il existe des lieux qui ne se contentent pAs de vous Accueillir : ils vous trAnsforment. le club med puntA cAnA — premier tout-inclus à s’être instAllé sur lA côte dominicAine dAns les Années 1970 — fAit pArtie de ceux-là. entièrement repensé pour 2026, ce villAge incArne Aujourd’hui tout ce que représente l’Adn de lA mArque : un tout-inclus premium, porté pAr cet esprit hum A in et convivi A l qui fA it s A réputAtion depuis ses débuts.

Séjourner au Club Med, c’est bien plus qu’un confort raffiné ou une généreuse liste d’inclusions, c’est adopter un véritable style de vie en vacances. On y choisit la liberté de se laisser porter par des journées dénuées du moindre souci logistique, dans un environnement où tout est pensé et exécuté avec précision. Celui de Punta Cana, le plus gros au monde, se distingue depuis toujours par l’ampleur de son offre tout-compris, qui dépasse largement les standards du secteur. Une cuisine diversifiée, des bars élégants, des spectacles, des activités sportives et des Kids Clubs dès 4 mois sont inclus. Les sportifs y trouvent un terrain de jeu inégalé : voile, paddle, tennis, tir à l’arc, kayak, yoga, fitness et bien plus encore. Chaque activité est encadrée par des moniteurs certifiés, incarnant l’une des signatures les plus précieuses du Club Med : l’expertise autant que la passion.
Mais ce qui imprime les souvenirs les plus durables, ce sont les gens. À Punta Cana, la vie de village se déploie tout au long de la journée. Les G.O. vous saluent par votre prénom, croisent vos enfants au Mini Club, vous accompagnent dans un cours de sport le matin, puis montent sur scène le soir lors des spectacles. Ces instants partagés créent un sentiment rare : celui de faire partie d’une véritable communauté. Familles, couples, voyageurs solos, tous se retrouvent, jour après jour, dans cette atmosphère paradisiaque, chaleureuse et inclusive qui distingue le Club Med de tout autre complexe hôtelier.

L’année 2026 marque un tournant pour le Club Med Punta Cana, qui dévoile une série de rénovations ambitieuses, pensées pour élever encore davantage l’expérience. Un an après l’incendie qui a frappé le village, les installations se sont modernisées tout en conservant leur âme pionnière. Les nouvelles chambres Deluxe Costa Del Coco , apaisantes et lumineuses, s’inspirent de la douceur de la côte dominicaine. Balcons privés, salles de bain au design spa et matériaux naturels invitent à la détente absolue. Le Buena Vista Lounge, spectaculaire espace panoramique à 360°, offre un refuge bohème chic avec vue infinie sur l’océan. Au cœur du village, le tout nouveau restaurant El Mundo marie les influences françaises, latines, asiatiques et méditerranéennes dans une atmosphère conviviale. Pour un moment plus intime, le Bar Joia rappelle les casitas dominicaines et propose un cadre éclatant pour savourer un cocktail en soirée. Et pour les plaisirs simples, Le Café devient l’adresse privilégiée des amateurs de cafés fins, de douceurs et de discussions tranquilles.
Le Club Med Punta Cana s’adresse aux personnes souhaitant vivre des vacances haut de gamme, et où chacun, dans un même voyage, trouve exactement ce dont il a besoin. Les familles y profitent d’une sérénité totale grâce aux Kids Clubs, véritables univers créatifs et sportifs qui enthousiasment autant les enfants que les parents. Les couples et les groupes d’amis se dirigent souvent vers le Zen Oasis, un espace réservé aux adultes, comprenant piscine calme, chambres dédiées et zones de détente. Certains viennent pour le sport, d’autres pour tout arrêter, tous repartent plus légers.

L’expérience se veut aussi plus responsable : construits et rénovés selon des principes écoresponsables, les villages Club Med poursuivent leur engagement Happy to Care. Punta Cana n’y fait pas exception, en intégrant gestion durable, soutien aux communautés locales et respect des certifications environnementales exigeantes. Il y a aussi ces moments signature qui définissent un séjour au Club Med : l’horizon qui se colore à l’aube, l’éclat de fierté d’un enfant et une soirée où les rires se fondent sous un ciel scintillant. Des instants d’une intensité rare, où l’on goûte pleinement au luxe d’une totale déconnexion.
Le Club Med Punta Cana, un lieu où l’on pose ses valises… et où tout commence !

Pour en savoir davantage :
Voyage

lA conjoncture n’AurA jAmAis été Aussi idéAle pour prendre le temps de redécouvrir le « cAnuck », dont ses provinces m A ritimes. z oom sur l A n ouvelleé cosse, puis A nt encore A ujourd’hui d A ns ses rAcines mi’kmAq, AcAdiennes, Afro-néo-écossAises et gAéliques. où que vous soyez dAns lA province,
vous pourrez vous immerger d A ns ces cultures uniques qui f A çonnent l’identité des gens. d es sites incontournAbles Aux Aventures Absolument uniques, voici mon pA lm A rès de 15 expériences à tenter pendAnt un séjour en nouvelle-écosse.


Suivez la longue promenade côtière d’Halifax, où débordent de petits commerces et les meilleures expériences culinaires de la ville, les restaurants Mystic, Tribute et The Bicycle Thief entre autres exemples. De plus, l’histoire militaire de la Nouvelle-Écosse est intimement liée à son histoire maritime, que met à l’honneur le musée maritime de l’Atlantique avec, notamment, son exposition sur le Titanic. Tandis que le musée canadien de l’immigration du Quai 21 raconte quelques récits recueillis parmi le million de personnes passées à cet endroit.
Pourquoi ne pas monter à bord du traversier depuis le centreville d’Halifax afin de rejoindre Dartmouth en quelques minutes ? La ville abrite nombre de charmants cafés et boutiques, ainsi qu’un attrait qui lui est propre : ses lacs. Surnommée la « ville des lacs », Darmouth compte 23 lacs où l’on peut pratiquer une foule d’activités. Promenez-vous sur le front de mer de Dartmouth ou embarquez pour une excursion en bateau depuis Fisherman’s Cove, près du village d’Eastern Passage, jusqu’aux îles McNabs. Enfin, ne manquez pas de faire un saut au populaire marché fermier d’Alderney Landing le samedi en matinée.

DÉCOUVRIR LES PLANTES AQUATIQUES
COMESTIBLES À LA BAIE DE PROSPECT
Explorez la nature de la baie de Prospect ou de la plage de Lawrencetown afin de comprendre les écosystèmes et d’identifier les produits sauvages comestibles. Bouclez l’excursion en prenant le temps de déguster les plats préparés par votre guide-chef. Une expérience à ne pas manquer avec Fred Dardenne Wild Foods. fred-dardenne.com
OBSERVER L’AVIFAUNE
AU SENTIER DU MARAIS SALÉ
Le sentier du Marais salé représente un réseau de parcours polyvalents (randonnée, vélo, ski de fond et raquette) qui fait partie du Sentier transcanadien et reliés entre eux par une ancienne voie ferrée. Le sentier du Marais salé — qui s’étend sur 13 km aller-retour — comprend notamment un tronçon sur une chaussée à travers le marais salé de Cole Harbour, qui offre des vues magnifiques, des panneaux d’interprétation et une avifaune abondante.


Pour une expérience inoubliable, inscrivez-vous à un cours de surf à partir de la plage de Lawrencetown. Quant au parc provincial de la plage de la Martinique, il offre la plus longue (5 km) plage de sable de la province. Puis, en quelques pas seulement, passez de l’eau salée de l’océan à la plage d’Ingonish au lac Freshwater pour y pratiquer le kayak. Reliant les îles historiques de LaHave au continent, la plage de Crescent, quant à elle, s’étend telle une route sablonneuse, inspirant les œuvres des artistes de la région. Enfin, une expérience authentique de l’Atlantique vous attend au parc national de Kejimkujik Bord de mer, où vous pourrez aussi observer des phoques se prélassant au soleil sur les îlots côtiers.
La Good Cheer Trail de la Nouvelle-Écosse, première route des vignobles, des brasseries artisanales, des cidreries et des distilleries au Canada, lève son verre au savoir-faire de nombreux artisans. De Yarmouth à Sydney, découvrez de nouveaux produits locaux à l’une des quelque 80 haltes de la route. goodcheertrail.com

S’élevant majestueusement sur les rives de la baie de Fundy, le parc provincial Five Islands est l’une des principales destinations de plein air de la Nouvelle-Écosse. Situé non loin à l’est de Parrsboro, le parc offre des falaises de 90 mètres de haut surplombant les plus hautes marées du monde, un cadre spectaculaire pour la pêche aux palourdes.
L’iconique Vieux-Lunenburg est l’une des deux seules communautés urbaines d’Amérique du Nord inscrites au patrimoine mondial de l’UNESCO. On peut encore y admirer les grands voiliers amarrés au port, comme cette réplique de la goélette de course Bluenose II. Les rues du port de Lunenburg sont bordées de boutiques uniques et de restaurants primés se mariant harmonieusement avec les maisons historiques bien préservées.

C’est dans cette province que se trouvent certains des secteurs de pêche au homard les plus riches du monde, et ce crustacé est pêché tout au long de l’année. Le homard est certainement partout à l’honneur avec des festivals, des croisières, des festins (même de la poutine) dont vos papilles se souviendront. Le Nova Scotia Lobster Trail vous permet certainement de trouver les mets les plus savoureux et originaux de la Nouvelle-Écosse à travers 40 restaurants. novascotialobstertrail.com
Récemment classée parmi les dix plus belles villes du Canada par culturetrip.com , la colorée Mahone Bay est reconnue pour ses trois églises. Par ailleurs, saviezvous que la Nouvelle-Écosse compte plus de 160 phares historiques ? Mais aucun n’est aussi photographié que celui du pittoresque village de pêcheurs de Peggy’s Cove. Construit en 1915, le phare veille toujours sur les vagues déferlantes et les homardiers en activité.
VIBRER AU FESTIVAL DE FILMS CULINAIRES DEVOUR
Wolfville est au cœur de la scène viticole florissante de la province, regroupant une douzaine de vignobles. Abritant le Devour, le plus grand festival de films culinaires du monde, la ville compte plusieurs charmants restaurants et cafés, chacun dédié à la création de plats de saison à partir de produits locaux. devourfest.com



REVIVRE L’ACADIE
DU 1 8 e SIÈCLE AU PAYSAGE DE GRAND-PRÉ
Situé dans le bassin des Mines de la baie de Fundy, au sein de la vallée de l’Annapolis, le Paysage de Grand-Pré est même inscrit à l’UNESCO. S’étendant sur 13 km², le site est composé de terres endiguées, de champs et d’habitations sur les collines. Établi par les Acadiens dans les années 1680, Grand-Pré a été entretenu au fil des siècles par des planteurs originaires de la Nouvelle-Angleterre et par les divers immigrants.
Découvrez la beauté naturelle des hautes terres du CapBreton en empruntant la célèbre Cabot Trail longue de 298 km. Il est généralement suggéré de rouler dans le sens antihoraire comme on accède facilement à la plupart des aires d’observation. N’oubliez surtout pas de surveiller les baleines dans le golfe du Saint-Laurent. Le centre d’interprétation des baleines de Pleasant Bay vous permet justement de découvrir les écosystèmes de la région avant une excursion d’observation des baleines. Ou bien faites l’ascension du cap Smokey à bord du premier téléphérique de l’est du Canada. Finalement, admirez la vue imprenable depuis le camping Hideaway et son marché aux huîtres à South Harbour.

Du sommet de la montagne des Français, randonnez sur le sentier du Skyline, où une falaise spectaculaire surplombe la côte accidentée depuis l’extrémité de ce sentier plat. Vous pourriez croiser des orignaux, des pygargues à tête blanche et des ours qui vivent dans cet habitat. Poursuivez par une marche le long du sentier de la vallée de la Clyburn, où les spectaculaires peuplements de feuillus, les rochers plus gros que nature, les anciens étangs de castors et même les vestiges d’une ancienne mine d’or devraient vous émerveiller.
La plus grande reconstitution historique d’Amérique du Nord, la Forteresse-de-Louisbourg vous plonge dans la vie coloniale française entre 1713 et 1758. Le XVIIIe siècle a vu arriver sur les rives de cette terre d’accueil des Mi’kmaq, des Français, des Basques, des Allemands, des Anglais, des Irlandais, des Écossais et des Africains. Faites donc un saut dans le passé en explorant les fortifications, les jardins et les élégantes maisons reconstruites. Ces cultures continuent assurément de prospérer au Cap-Breton-Unama’ki, et ce, à travers la musique, la danse, la langue et l’artisanat.

BANQUE NATIONALE
les tensions commerci A les de l A dernière A nnée ont mis en lumière les risques d’une trop grAnde dépend A nce envers un seul pA rten A ire. « l es pme du québec ont donc tout intérêt à diversifier leurs Activités et leurs sources de revenus, A insi qu’à revisiter leurs strAtégies de croissAnce pour être plus résilientes », Affirme vincent lAndry, premier vice-président, entreprises et gestion privée 1859, q uébec et Atl A ntique. v oici trois leviers pour y pArvenir.
Le contexte géopolitique actuel et l’engouement pour l’achat local créent de belles occasions de revisiter certains marchés qui étaient peut-être jusqu’alors négligés. « Activez vos réseaux internes — personnel, fournisseurs, clients — pour cibler des partenaires d’affaires potentiels afin de leur présenter vos solutions et soutenir votre croissance sur le plan national », soutient Vincent Landry.
Un rapport de la Fédération canadienne de l’entreprise indépendante1 estime que 76 % des propriétaires de PME comptent céder leur entreprise d’ici 2033, ce qui représente plus de 2 000 milliards de dollars d’actifs commerciaux à transférer. « Les occasions en fusions et acquisitions au Canada sont omniprésentes, et elles offrent un levier de croissance intéressant pour profiter de nouveaux talents, d’une expertise complémentaire ou de l’accès à un marché convoité », poursuit Vincent Landry.
Dans un environnement inflationniste et protectionniste, des entreprises de partout dans le monde revoient leurs coûts et leur chaîne d’approvisionnement. « Appuyez-vous sur votre institution financière pour vous soutenir dans vos projets de diversification et d’expansion à l’international. Elle pourra vous mettre en relation avec des banques partenaires, des organismes publics d’aide au développement des affaires et des expertises professionnelles dans la région. »
1 Relève des entreprises au Canada : Se préparer au tsunami de successions prévues les dix prochaines années, 2023
La diversification offre aux PME les bases d’une croissance durable et une marge de manœuvre essentielle pour s’adapter, rebondir et demeurer concurrentielles en toutes circonstances. En période favorable, cette approche leur permet de saisir plus rapidement les occasions prometteuses. En temps d’incertitude, elles corrigent leur déséquilibre envers un seul marché géographique, client ou secteur.
« La diversification est un puissant levier pour réduire notre dépendance vers un nombre restreint d’alliés commerciaux, stimuler l’entrepreneuriat et l’innovation, et rendre notre pays plus fort et plus prospère. »
Vincent Landry, premier vice-président, Entreprises et Gestion privée 1859, Québec et Atlantique

Le 14e Bal du maire de la Fondation Jeunes en Tête aura lieu le vendredi 5 décembre prochain sous la présidence d’honneur de M. Laurent Ferreira, président et chef de la direction de la Banque Nationale. Une soirée caritative au bénéfice de la santé mentale des ados de la Capitale-Nationale et de l’Est-du-Québec.

6,5 M$ investis dans la prévention en santé mentale
60 partenariats locaux développés
Des milliers d’adolescents sensibilisés et soutenus chaque année
Depuis plus de 25 ans, les fonds amassés lors du Bal du maire de la Fondation Jeunes en Tête nous permettent de prévenir la détresse psychologique chez les jeunes de 11 à 18 ans et de soutenir la santé mentale des adolescents de la Capitale-Nationale et de l’Est-du-Québec.
MERCI DE CONTINUER À SOUTENIR LES ADOS : fondationjeunesentete.org
Cocktail Signature SP 2026 : quand la générosité rencontre l'harmonie

Laissez-vous emporter par la musique le temps d’une soirée durant laquelle chaque note résonnera pour faire vivre l’espoir et vous donner l’occasion de manifester votre soutien envers les 20 000 Québécois et Québécoises vivant avec la sclérose en plaques (SP).
Sclérose en plaques Canada et ses organismes partenaires convient la communauté d’affaires de la Capitale-Nationale à un cocktail dînatoire qui se déroulera au Palais Montcalm pour ensuite se transformer en concert magistral donné par l’Orchestre symphonique de Québec en présence du directeur musical Clemens Schuldt.
Aux côtés des coprésidents d’honneur, Véronique Dallaire et Jonatan Bérubé, venez profiter d’une soirée toute spéciale de réseautage à laquelle sont attendus près de 300 convives.
Pour acheter des billets : signaturesp.ca
La faim est si vite arrivée : la guignolée des médias vous invite à la solidarité

Dans la grande région de Québec, plus de 300 000 demandes d’aide alimentaire obtiennent une réponse chaque mois. Derrière ces chiffres, on trouve des parcours bouleversés par une séparation, une perte d’emploi, un problème de santé ou la hausse du coût de la vie. Des réalités qui peuvent toucher n’importe qui, à tout moment.
La Guignolée des médias invite à un geste simple, mais essentiel : donner. Parce que l’insécurité alimentaire ne se limite pas à manquer de nourriture. Ce sont des enfants qui vont à l’école le ventre vide, des travailleurs qui choisissent entre se nourrir ou se loger, des familles qui jonglent avec l’impossible.
Chaque don fait une différence concrète. En cette fin d’année, offrons plus qu’un repas : offrons du répit, du réconfort, et un peu d’espoir.
Donnez à moissonquebec.com
Un public conquis par la 7e édition de l’Open House de La Dauphine

Le 18 novembre dernier, la scène du Palais Montcalm a vibré au rythme des performances exceptionnelles de Luce Dufault, Lunou Zucchini, Geneviève Leclerc et Yama Laurent, qui ont offert au public des moments d’une remarquable intensité.
Grâce au talent et au savoir-faire du producteur Richard Aubé, cette soirée unique a une fois de plus tenu toutes ses promesses, au bénéfice des jeunes en difficulté accompagnés par La Dauphine. Présentée par la Fondation Maurice Tanguay, cette 7 e édition de L’Open House a permis d’amasser 161 000 $ au profit de la Fondation Maison Dauphine.
Pour faire un don : ladauphine.org

Coprésidents d’honneur : Régis Labeaume et Guylaine Tremblay Sylvie Martineau, directrice Fondation Maison Dauphine ; Olivier Tanguay, directeur général Fondation Maurice-Tanguay ; Stéphane Breton, directeur général Desjardins Caisse de Québec ; Marie-Pierre Boucher, vice-présidente du conseil exécutif et responsable du dossier de l’itinérance à la Ville de Québec ; Pierre Lapointe, président du conseil d’administration de la Fondation Maison Dauphine.
Fondation Philippe Laprise : une soirée réussie au profit du TDAH au féminin

Annick Héon, directrice générale de la Fondation Philippe Laprise ; Martin Beaulieu, directeur général de la Caisse Desjardins du Plateau Montcalm ; Zoheir Ferdjioui, pédiatre et membre du Doc Show ; Véronique Lord, radiologiste ; Newton Jose Godoy Pimenta, neurochirurgien ; Guy Chamberland, médecin de famille ; Philippe Laprise, humoriste, président et fondateur de la fondation ; Nathalie Lapierre, médecin de famille.
Le 15 novembre dernier, la Salle Jean-PaulTardif de Québec a vibré au rythme du Doc Show, un spectacle remarquable où des médecins ont littéralement ébloui les spectateurs en troquant leur sarrau pour un micro. Près de 450 billets ont trouvé preneur et le public s’est dit impressionné par la qualité et l’énergie du spectacle.
La première partie, assurée par le MedBand, formé d’étudiants de la Faculté de médecine de l’Université Laval, a su conquérir la salle.
Grâce à cette soirée inspirante, un peu plus de 25 000 $ ont été amassés pour soutenir la cause du TDAH au féminin.
L’événement était présenté par Desjardins grâce à la mobilisation des caisses de la région de Québec.
Pour faire un don : fondationphilippelaprise.com
Michel-Sarrazin - Soirée des leaders
Une présence qui traverse le temps : 40 ans d’humanité en héritage

Michèle Tourigny, présidente du conseil d'administration de la Maison MichelSarrazin ; Brigitte Laflamme, directrice générale de la Maison Michel-Sarrazin ; Josée Marceau, vice-présidente sénior, services-conseils, Unité d'affaires de Québec et associée de CGI ; Maryse Pineault, vice-présidente, affaires corporatives chez Beneva ; Maxime Laviolette, président et chef de la direction chez Dessercom ; Marie-Pier Frenette, directrice générale de la Fondation Michel-Sarrazin ; et Jean G. Morency, président du conseil d'administration de la Fondation Michel-Sarrazin.
Le 30 octobre dernier, au Manège militaire Voltigeurs de Québec, la Fondation Michel-Sarrazin a tenu la 11e édition de sa Soirée des Leaders, présentée par CGI. Sous la coprésidence d’honneur de Maryse Pineault, vice-présidente, affaires corporatives chez Beneva, et de Maxime Laviolette, président et chef de la direction chez Dessercom, l’événement a rassemblé près de 600 invités issus du milieu des affaires et de la communauté philanthropique. Grâce à leur mobilisation et à leur générosité, un montant exceptionnel de 470 222 $ a été amassé pour soutenir l’œuvre Michel-Sarrazin, qui accompagne gratuitement les personnes atteintes de cancer en phase palliative ou terminale, de même que leurs proches.
Pour faire un don : michel-sarrazin.ca
Cocktail-bénéfice « Des racines et des ailes » de la Société Alzheimer de Québec

Nicolas Maltais (CF), Chantal Arguin (CF), Diane Allaire (CA), Michel Baribeau (CA), Dr Rémi Bouchard, fondateur de La Société Alzheimer de Québec, Dr Guy Tremblay (CF), Émilie Bilodeau (CA), Marc-André Bouchard (CA), Francisca Dupuis (CA), Nicolas Dupont (CA), Marika Emond (CA), Marc Coulombe (CF) et président d’honneur du Cocktail-bénéfice, et Jérôme Gaudreault, directeur général de la SAQ
Le 2 octobre dernier, sous la présidence d’honneur de M. Marc Coulombe, près de 200 personnes de la communauté se sont réunis au Capitole de Québec pour le Cocktail-bénéfice « Des racines et des ailes » de la Société Alzheimer de Québec.
L’événement a permis de dévoiler les progrès de la campagne annuelle, qui approche fièrement son objectif de 400 000 $. Animé par l’auteur-compositeur-interprète Étienne Drapeau, le cocktail a plongé les convives dans une ambiance de jardin de nuit où émotions, solidarité et espoir se sont mêlés. Les fonds recueillis permettront de soutenir les familles touchées par la maladie d’Alzheimer et les autres troubles neurocognitifs.
Pour faire un don : societealzheimerdequebec.com
Cabaret du Blanchon 2025 : Feux de la rampe et cœurs généreux

Lyne Boivin et Marie-Josée Turcotte, coorganisatrices de la soirée et membres du C.A.; Guy Pelletier, président de Groupe GP, présentateur de la soirée; Annie Laliberté, présidente d’honneur de la soirée, directrice générale et associée chez Beauport Hyundai et Genesis de Québec; Guy Boutin, président-fondateur de la Fondation Le Petit Blanchon; et Sabrina Ferland, coorganisatrice et directrice artistique de la soirée, présidente de Bellita.
Le 17 octobre dernier, le Théâtre Capitole a brillé de tous ses feux à l’occasion de la deuxième édition du Cabaret du Blanchon. Présenté par Groupe GP devant une salle comble, et sous la présidence d’honneur d’Annie Laliberté, de Beauport Hyundai et Genesis de Québec, le spectaclebénéfice, qui mettait en vedette 10 personnalités de Québec coachés par des artistes professionnels, a permis de récolter 172 000 $ au profit de la Fondation Le Petit Blanchon. Les fonds serviront à réaliser un troisième projet d’envergure en collaboration avec le Centre de pédiatrie sociale de Québec, en soutien aux enfants les plus vulnérables de notre société.
Pour faire un don : fondationlepetitblanchon.com

Les Arbres de l’espoir

De gauche à droite : Alexandra Larochelle, Fondation du CHU ; Jean-François Vary, directeur général du Château ; Dr Jean Bond et Dre Mama Mia, Christine
Le 6 novembre dernier se tenait la 12 e édition des Arbres de l’espoir, un événement-bénéfice au profit de la Fondation du CHU de Québec. Sous la thématique « Élégance hivernale », vingt entreprises de la région ont démontré leur générosité en commanditant et en décorant chacune un arbre.
Les fonds recueillis ont été remis au Centre mère-enfant
Soleil afin de soutenir le programme Dr Clown, qui apporte réconfort et sourire aux jeunes patients. Cette édition a permis d’amasser un montant record de 31 000 $, portant à plus de 225 000 $ la somme totale remise depuis la création de l’initiative.
Nouvellement, les arbres sont exposés dans la verrière du salon Haldimand et peuvent aussi être admirés sur la page Facebook du Château.
Pour faire un don à cette cause : jedonneenligne.org/fondationchudequebec/ drclownfcf/

